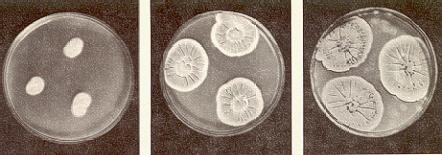

Figura 1. En el cuadro del pintor alemán Pieter Breughel (1525-1569) se ve cómo era un taller de alquimista: voluminoso alambique, formulario abierto, vasijas, reloj de arena, fuelle y, cerca de éste, el alquimista que trata de fabricar oro.
Todavía hoy no puedo olvidar la pregunta que me hizo uno de mis profesores, hace muchos años: -¿Cuántos años cree usted que tenga la química? Sus ojos azul claro se fijaron en mí, como si quisieran leer en mi cara la respuesta, antes que la formulara mi boca.
Miré a mi alrededor, por la sala de clase; a lo mejor alguien me ayudaba. ¡Nada! -Doscientos, trescientos años -dije sin saber.
El profesor se quitó los anteojos y los limpió con su pañuelo en silencio. -Usted sabe más que yo, amigo -dijo sonriendo y se sentó en un banco-. Por lo que sé, hasta ahora, nadie en el mundo ha llegado a determinar ni siquiera aproximadamente la fecha del nacimiento de la química.
Luego durante toda la hora nos habló de aquello. El silencio era tan profundo que se hubiera oído volar una mosca. Aunque no nos dijo exactamente cuándo empezó la química, hasta ahora no he olvidado la aventura que representa.
Y ahora quisiera hablar, sin fórmulas ni cálculos, de la química que nos rodea, la que vivimos y sin la cual ya no podríamos ni siquiera imaginarnos la vida sobre nuestro planeta. Quisiera contestar a todas las preguntas que me vienen a la mente cuando miro las cosas que están delante de mí, sobre la mesa: ¿Por qué son tan perfectas las manzanas rojas que brillan en el frutero de cristal? ¿Por qué tiene el mantel diversos colores? ¿Cómo obtuvo el hombre las pastillas blancas que están en el frasco amarillento que reza "Sólo con receta médica"? ¿A quién tendría que agradecer por la invención del papel sobre el cual estoy escribiendo estos renglones, y por esta bonita pluma verde de materia plástica? ¿Ante quién inclinarme por el hecho de que no ande envuelto en una piel de oso, sino que tenga un traje de lana y fibras sintéticas y calcetines de nylon? Y en fin ¿por qué envuelve a mi hija, que se prepara para un baile, un perfume de violeta?

Figura 2. Accesorios que utilizaban los químicos hace muchísimos años.
Si dijera que todo lo que acabo de mencionar se lo debemos al químico, sería la verdad, la pura verdad. Pero ¿a quién agradece el químico el hecho de que él mismo pudiera empezar por alguna parte, partiendo de las experiencias de otros? Al alquimista que, en los tiempos de los antiguos egipcios y árabes, o incluso de nuestros antepasados medievales, con sed de saber seria a medias, a medias charlatana, trató de penetrar el secreto de la materia, transformarla y modificarla. No importa que el motivo de los alquimistas no fuera pura nobleza de ánimo, que los predecesores de los químicos, con la copela en la mano, los alambiques llenos de mercurio, azufre y los más, variados elementos, buscaran el secreto de la producción del oro. El tiempo descubrió su verdadera faz y junto al nombre de más de uno de ellos se escribió una sola palabra: embustero. Tal es el caso de Michal Sedziwój, a quien volveremos a mencionar. Rodolfo II, emperador germánico y rey de Bohemia, en 1598 nombró consejero de la corte a este alquimista polaco que sabía de veras mucho acerca de la química de aquel tiempo, sólo porque el astuto polaco le convirtió una moneda de plata en oro. Naturalmente, por medio de un engaño sencillo: untó con mercurio una moneda de oro y luego la puso al fuego ante la mirada asombrada del Emperador; el mercurio se evaporó y apareció un magnífico pedacito de oro.
Pero hoy apenas le interesa a uno saber que los antecesores de los químicos modernos buscaran la piedra filosofal o el elixir de la vida, para hacer al hombre inmortal y cambiar materias sin valor en oro. Sólo los novelistas hojean con gusto los antiguos formularios, en los cuales escribían los alquimistas cuántos sapos o salamandras era necesario agregar a alguno de sus procesos de producción para obtener la tintura roja que pudiera preservar la salud del hombre eternamente.

Figura 3. Laboratorio de investigaciones de química orgánica. Algunos aparatos fundamentales del laboratorio químico: 1. Mechero, para calentar, hervir e incinerar. 2. Bomba de vacío para acelerar la filtración. 3. Baño de María, para calentar o secar diversas sustancias, en condiciones suaves. 4. Baterías de aparatos de extracción para obtener sustancias solubles por disolución selectiva.
Lo que más nos interesa es saber hasta dónde llegaron estos predecesores del químico actual. Por ejemplo, cómo Johann Friedrich Böttger, aprendiz de boticario de Berlín en el siglo XVIII, obtuvo por casualidad, en lugar de oro, una porcelana que adquirió casi más valor que aquel metal precioso que el alquimista trataba de preparar partiendo de plomo y mercurio. O el caso de Brand, de Hamburgo, quien descubrió por casualidad el fósforo, por evaporación de la orina y calentamiento con ciertas materias sólidas. (Nos sonreímos de su estupefacción cuando la materia que obtuvo empezó a fosforescer en la oscuridad.)
Ruego que se advierta la palabra "casualidad". Todos estos alquimistas, cualquier cosa que hayan descubierto, la descubrieron por casualidad, y hasta cierto punto, auxiliados por su experiencia. Pero no fueron capaces de explicar los procesos que seguían. Aún no conocían la constitución de la materia, no conocían la lógica de los procedimientos químicos, no conocían las leyes de la química.
Esta ciencia, sin la cual no podemos imaginar el mundo actual, cuyo nombre deriva probablemente de la palabra árabe alkimía , es nueva; sin embargo sus raíces penetran profundamente en la historia de la humanidad. Se dice que el hombre se hizo químico en el momento que descubrió el fuego.
Entonces conoció por vez primera una reacción química. Sin embargo, apenas en el siglo XIX, cuando se establecieron las reglas fijas de la composición de la materia, empezó el desarrollo frenético de la verdadera ciencia química.
Desde la época en que trabajaron Kekulé -descendiente de emigrados bohemios, del cual se habla también en este relato- y el gran científico ruso Mendelejev, descubridores de fundamentales reglas, encontramos cada vez menos la palabra "casualidad" en la historia de la química y de sus invenciones.

Figura 4. Y así es el laboratorio del químico moderno (1963).
No hay que confundirse si se la encuentra algunas veces en este libro, incluso a propósito de un descubrimiento tan moderno como el de la penicilina. Hay que entender bien esta palabra.
Es absolutamente cierto que Fleming descubrió la penicilina por casualidad, hasta cierto punto. Pero este médico inglés sabía mucho, durante sus experimentos tuvo una paciencia infinita, fue enormemente curioso y además -ahora tomemos una palabra de los cuentos de hadas- fue clarividente. Muchos otros hubieran tirado el contenido de la cápsula en que habían aparecido mohos en lugar de bacterias. Fleming quería precisamente cultivar bacterias, y no mohos. Sin embargo, Fleming quiso saber por qué nacían mohos en la cápsula en lugar de bacterias. Fue curioso, paciente y penetrante y por eso descubrió la penicilina.
Hablemos algo más acerca de la casualidad. Hoy el químico ya no es el caballero andante que vaga por el fabuloso imperio de la química, esperando que la suerte lo favorezca para descubrir algo desconocido hasta entonces. En todo el mundo trabajan ejércitos de químicos, en institutos de investigación, según planes precisos. Cada uno de ellos tiene su tarea.

Figura 5. DIMITRI IVANOVICH MENDELEJEV (1834-1907), gran químico ruso, advirtió que algunas propiedades de un elemento se repiten en otro, y que estas propiedades dependen del peso atómico de los elementos. Así estableció una tabla de los elementos conocidos en aquel tiempo, según las semejanzas entre ellos.
Tienen conocimientos científicos, aparatos modernos, y también asombrosa paciencia y tenacidad.

Figura 6. Así es hoy (1963) la tabla del sistema periódico de los elementos de D. I. Mendelejev
Ya está muerto hace mucho Keller, pobre tejedor de Sajonia que, para descubrir la producción del papel de la madera, tuvo que estar mirando a los niños jugando junto al molino con huesos de cerezas. Se encontrará luego algo más sobre esto.
El químico moderno se parece un poco al jugador de ajedrez, que sabe lo que va a pasar si mueve una u otra pieza.
Aunque la química actual está libre del romanticismo de los alquimistas de otros tiempos, aunque para los experimentos químicos no es necesario el plenilunio ni tener a mano un pedazo de soga de algún ahorcado, no deja de ser una gran aventura llena de secretos. Los métodos que emplea el químico moderno para descorrer el velo son diferentes de los del alquimista de la Edad Media. Sin embargo, el deseo de descubrir el secreto es el mismo.
Hablemos entonces del mundo de las retortas, las copelas y de los recursos modernos que ayudan al químico a alzar el velo que cubre este mundo lleno de misterios.
EL QUE SE COMÍA EL PAN DE LOS DEMÁS
Contenido:
1. El muchacho y el animalillo
2. El descubrimiento del profesor Millardet
3. Los animalitos y los grandes números
4. De la amanita a los gases de combate
5. La criada y las moscas muertas
6. ¿Por qué murieron las moscas alrededor del tubo?
7. Manzanas distintas
8. Un avión en lugar de un delantal
9. Las plantas que crecen donde no deben
10. "Cida" significa muerte
11. Hojeemos un formulario químico
12. El alquitrán es más precioso que el oro
13. Petróleo en lugar de papas
14. Pistas y DDT
1. El muchacho y el animalillo
En las riberas del río Usumacinta se apagaban los últimos fuegos y en el aire se sentía el perfume delicado del incienso que salía de uno de los más grandes templos del extraño pueblo de los mayas.

Figura 1. En el siglo VII de nuestra era empezó una increíble peregrinación del pueblo maya hacia el norte. El antiguo imperio de aquel pueblo tan civilizado se extendía sobre el territorio de lo que ahora es Honduras, Guatemala y los estados mexicanos de Chiapas y Tabasco. Los mayas lo abandonaron y emigraron al norte a la península de Yucatán.
Dentro del santuario atestado de gente hacía un calor sofocante, y no se podía dar un paso. Un adolescente acababa de cortarse la lengua para ofrecer algunas gotas de sangre: último sacrificio a los dioses.
Ya hacía algunos años que llenaban los templos mayas los habitantes, cansados y exhaustos, de la región que se extiende de la Cordillera al océano Atlántico, del istmo de Tehuantepec a Nicaragua. ¡Cuánta sangre había caído ya en el plato de los sacrificios, de plata, cuántas esperanzas vanas! Los habitantes de una de las tierras más civilizadas del principio de la Edad Media se estaban muriendo de hambre.
Estamos en el año 610 de nuestra era.
Esta gente, cuyas manos saben tejer telas de algodón e imprimirles bellos colores duraderos, artistas que saben cómo dar a las joyas un esplendor increíble, incomparables constructores de barcos, creadores de templos cubiertos de pinturas y esculturas, se está muriendo de hambre.

Figura 2. Reconstrucción de la ciudad de Copán. Cientos de miles de personas abandonaron esta ciudad por miedo al insignificante gusanillo del maíz.
Último sacrificio, última esperanza. Si los dioses no tienen compasión, se extingue la gran nación en las riberas del río Usumacinta y en los valles de sus afluentes. Hace ya algunos años que impera el hambre en esta tierra. La gente cultiva los campos con sus últimas fuerzas, cuidadosa y concienzudamente, pero la tierra no produce.
El maíz, alimento básico de los mayas, no da mazorca, las hojas son débiles y deslucidas. Los mayas conocen la piña, gran número de variedades de verduras, el cacao y el tabaco.

Figura 3. Hace 1500 años ya los mayas cultivaban el maíz.
Sin embargo, los dioses están airados contra esta nación tan trabajadora y culta. Las cosechas se marchitan, todo lo que se come se seca antes de madurar, o no produce fruto. La última gota roja cayó de la lengua del muchacho en el plato de los sacrificios.

Figura 4. Plástica maya del dios del maíz.
Ya no cree nadie en milagros. El día anterior se reunió el consejo de los ancianos y decidieron hacer el último intento: el joven Acuanas sacrificará su sangre para aplacar a los dioses airados.

Figura 5. El gusanillo del maíz (muy aumentado).
Si no se contentan aquellos de quienes depende la vida de miles de hambrientos y atormentados, no quedará más que despedirse de la tierra de los antepasados, abandonar templos, sobre cuyos muros está inscrita la sabiduría de tantas generaciones, dejar todo lo que está registrado en las cortezas e irse a medianoche.

Figura 6. La preparación que se vaya a observar con el microscopio electrónico deberá ser muy sutil y obtenida con gran cuidado.
El sacrificio terminó. El templo empezó a vaciarse; llegaba la noche que representaba la muerte en la tierra de los mayas.
El aroma fuerte de la resina de copal volaba sobre la multitud que abandonaba el templo, en el cielo aparecían las primeras estrellas, resplandecientes y claras. Los últimos fuegos se apagaban en las riberas del río Usumacinta, y con ellos se esfumaba la esperanza de milagro de los mayas.
Los dioses no atendieron al joven Acuanas, los campos de maíz no reverdecieron, los tallos marchitos no dieron mazorcas doradas. La tierra estaba condenada a muerte.
¿Quién la había condenado? ¿Los dioses? De ninguna manera. Hoy lo sabemos. Después de más de mil años nos lo han dicho los arqueólogos: un animalillo pequeño, insignificante, invisible a simple vista, destruía hacía años toda la cosecha del pueblo más civilizado del mundo en aquella época.
Si los mayas del siglo VII de nuestra era hubieran conocido el microscopio -hay el microscopio electrónico, que amplifica hasta 120 000 veces-, si hubieran conocido los insecticidas, productos químicos utilizados para exterminar los insectos nocivos y otros pequeños parásitos, el joven Acuanas no hubiera tenido que cortarse la lengua y sacrificar su sangre, sólo para calmar a los dioses. Y, sobre todo, aquellos mayas no hubieran tenido que abandonar su patria e irse a la península de Yucatán.

Figura 7. El microscopio electrónico, que aumenta hasta 120 000 veces, es un auxiliar indispensable del químico actual. Ocupa el lugar de la lupa y del microscopio óptico con los cuales el hombre multiplicaba antes las facultades de sus ojos.
Pero en aquel tiempo nadie sabía de la existencia de los parásitos de las plantas útiles, gusanillos insignificantes. Nadie sabía que en un solo grano de maíz se pueden esconder durante largos años hasta 15.000 parásitos. Aquí está, pues, el dios irritado que, año tras año, destruía la cosecha en los campos de los antiguos mayas: un animalillo invisible.
2. El descubrimiento del profesor Millardet
En la segunda mitad del siglo pasado la gente creía ya menos en los dioses enfadados; cuando entonces se extendió por la vid, primero en el suroeste de Francia y luego por toda Europa, una enfermedad extraña que llamaron peronospora, no se encontró ningún joven dispuesto a dejarse cortar la lengua para sacrificar algunas gotas de sangre a los dioses.
Los viticultores miraban con asombro las cepas invadidas por un moho desconocido. La química trató en vano de encontrar manera de conjurar la calamidad que amenazaba a los viñedos.
En la vid no dejaban de aparecer manchas oleosas amarillentas, el tejido de las hojas se oscurecía rápidamente, se secaba, se atrofiaba y caían las hojas. En los viñedos ya no se oían los cantos alegres de las vendimias de años anteriores. No había qué recolectar: la mayor parte de la cosecha estaba destruida.
Para que no robasen las pocas pobres uvas que quedaban en algunas cepas, los prudentes viticultores franceses decidieron rociar las cepas próximas a las carreteras con algo que les hiciese parecer envenenadas. Así, por lo menos nadie tocaría las uvas por puro miedo de envenenarse.

Figura 8. Hoja de la vid atacada por un moho y rociado con una aspersión
Y esta idea medio mezquina, medio ingenua, salvó los viñedos en todo el mundo. La astucia de los viticultores franceses consistía en utilizar una mezcla de cal y sulfato de cobre. Las uvas tocadas por esta preparación química parecían de veras repugnantes. Se le quitaban las ganas de comer uvas "venenosas" a la gente que pasaba por los viñedos salpicados de verdiazul. Maldecían al viticultor avaro, seguían su camino y ni siquiera tocaban las uvas. La única excepción fue cierto profesor de la ciudad de Burdeos. Se llamaba Millardet, era biólogo y todos los días iba a pasear fuera de la ciudad, Se sorprendió de la extraña idea de los viticultores de Burdeos.

Figura 9
Pero el profesor -a diferencia de los demás- no despreció las uvas manchadas, sino que advirtió que las cepas tocadas por la mezcla de cal y sulfato de cobre no eran atacadas por la plaga que le arrebataba el vino a la pobre humanidad. Al contrario, las cepas retiradas, que los viticultores de Burdeos no juzgaban necesario defender contra los ladrones, porque no se veían desde la carretera, estaban secas, sin hojas ni uvas. Este descubrimiento que hizo el profesor Millardet en 1885 en la carretera, a algunos kilómetros de Burdeos, hizo nacer una preparación química que se utiliza aún en todo el mundo contra las plagas y que se llama caldo bordelés.
Esta mezcla, que contiene cobre y calcio (el sulfato de cobre contiene este metal y la cal contiene calcio) salvó la viticultura en todo el mundo contra aquel moho, llamado entonces hongo destructor de la vid. No se repitió la historia de los mayas: el hombre salió del paso solo, aunque el azar le había ofrecido también su ayuda.
3. Los animalitos y los grandes números
Naturalmente, no basta el hallazgo del profesor Millardet para exterminar todos los parásitos de los vegetales. Existen otros enemigos secretos del hombre que tratan de arrebatarle su alimento o destruir las materias primas con que se hacen ropas y otras cosas vitales. En resumen, tratan de destruir las plantas que tienen para el hombre importancia vital y que llamamos plantas "cultivadas". Además de los insectos y hongos, se dedican a esto malas hierbas, roedores, bacterias y virus.

Figura 10. Escarabajo de la papa
Los daños que causan estos enemigos de la humanidad son increíbles. Por ejemplo, el ratón de campo, que roba sobre todo granos, en graneros y almacenes, hasta en un país pequeño como Checoslovaquia causa daños grandísimos: con la suma perdida se podrían comprar 30 000 automóviles. Si alguien lograra eliminar de los graneros, campos y almacenes este animalito gris, tendríamos riqueza mayor.
¿Nadie vio alguna vez a su abuela echar en un platito viejo unos granos violáceos y colocarlo donde pensaba que había ratones? ¿Qué respondía, al ser interrogada? "Es veneno, ten cuidado que las gallinas no vengan por acá". Los granos violáceos de trigo son de veras venenosos. Los tiñen así en la fábrica, al impregnarlos de veneno. Los colorean para distinguirlos de los buenos, que no hacen ningún daño ni a los ratones ni a las gallinas. El color violeta es el color de la muerte para el ladroncito que come tanto de las cosechas: el ratón de campo. Los granos venenosos -según decidieron varios estados en una conferencia internacional- deben teñirse de violeta en todos los países del mundo.


Figura 11 y 12. La hembra pone hasta 2 400 huevos al año
Imagínense ahora qué daños más grandes causaría al pueblo un solo insecto, si el hombre no lo combatiera con todas las armas químicas que tiene. Se conocen hoy en el mundo más de un millón de especies de insectos, y bien pocos de ellos -unas 10 000 especies- son parásitos nocivos, despiadados, que harían exactamente como el animalillo que atacó los campos de los antiguos mayas, si no tuviera el hombre una ayuda tan potente como la de la química. No sé si se podría evaluar el daño sin máquinas calculadoras electrónicas. Nos daría vuelta la cabeza con tantos miles de millones. Ya que no tenemos tal máquina calculadora, no intentemos el cálculo y sigamos nuestro viaje tras los parásitos vegetales.
Ya estuvimos en la tierra de los mayas, un momento nos detuvimos en la bella Francia, en Burdeos, y conocimos al profesor Millardet. Esta vez iremos a algunos kilómetros de Praga, a una pequeña aldea de los miles que hay allí. Vive en ella un viejo. Lleva una chaquetilla corta de piel de conejo, en la cabeza una gorra aplastada y siempre va detrás de él su perro. Tiene 73 años, pero nada se le escapa, pasea, se fija en la cerca recién pintada y en lo que los niños de Fulano o Mengano dicen. Hace poco, el viejo se detuvo junto a la puerta de mi jardín. Acababa yo de rociar los árboles con una disolución de DDT, del cual hablaremos luego.

Figura 13. Una familia de paros consume en un año un quintal métrico y medio de insectos. Una familia de cuatro paros ingiere durante un mes 6000 orugas. Una pareja de estorninos consume 86 abejorros en una hora y durante un día puede comer hasta 800 abejorros. Los pulgones que aparecen tanto en los árboles como en las rosas pueden multiplicarse hasta doce veces al año y cada generación representa 80 miembros.

Figura 14. Fumigación en una granja de frutales
-Qué sucio está usted, hombre -empezó sin saludar-. No se le ve ni siquiera la cara: gafas, trapos; está usted amarillo de pies a cabeza. ¿Qué sentido tiene esto? Sería mejor que dejara los árboles en paz. ¿A qué tantos esfuerzos? Yo en mi vida he rociado nunca nada y sin embargo vivo.
Al buen hombre le ayudan los pájaros; aquí picotean sólo los bichos de los árboles. El viejo no esperó mi respuesta; en aquel momento, además, no hubiera podido contestar, puesto que tenía sobre la boca un pañuelo para no respirar del chorrito con que trataba de proteger los árboles contra gusanos, orugas y otros animales que nos roban las cosechas. Llamó: -Ven, perrito, ven; que no te vaya a rociar con esa porquería -y se fue.
Figura 15. 800 en un día
Los hombres (naturalmente no todos, como lo vemos en el caso del viejo) se dieron cuenta hace mucho de que no pueden contar sólo con la naturaleza, que se las deben arreglar solos.



Figuras 16, 17 y 18. 6.000 en un mes
Tal vez nuestro antepasado desconocido de la edad de piedra mató de un manotazo la mosca que lo molestaba. La idea de destruir estos peligrosos enemigos del hombre, los insectos, es viejísimo, ya que saben también los hombres desde siempre que ni los pájaros ni los demás animales bastan para exterminar los insectos nocivos.
4. De la amanita a los gases de combate
En un libro que apareció en Nurenberg en 1709, se encuentran, por ejemplo, instrucciones para luchar contra las moscas: "Coge una amanita, ponla en un platito, córtala en pedacitos y échales leche. Luego coloca el platito donde haya más moscas. La mosca que come eso morirá. Mientras tanto debes tener cuidado de que el perro o el gato no se lo coman".
He aquí un viejo insecticida, o preparación para matar insectos. Además había otra indicación: si el veneno llega al aparato digestivo del insecto, lo mata. Es sin duda una receta un poco ingenua. Hasta el siglo pasado la gente no comenzó a utilizar un producto químico más eficiente contra los parásitos vegetales: la nicotina. La práctica de fumar se extendió por toda Europa y la gente reconoció -antes de darse cuenta de que el tabaco daría la propia salud- que una decocción de tabaco, que contiene nicotina, mata los insectos. Para que se adhiriera al cuerpo del insecto, se agregó al extracto de tabaco cierta cantidad de un producto pegajoso.

Figura 19
Esta mezcla química actuaba como veneno "respiratorio". ¿Es esto extraño? No. Es que el insecto respira por todo el cuerpo; así penetra la venenosa nicotina en el cuerpo del parásito. Pero la nicotina produce sólo un efecto de poca duración sobre el insecto. Por eso los químicos tuvieron que seguir buscando. Encontraron algo que podía proteger las plantas más tiempo y mejor. Fueron descubiertas dos plantas exóticas: el derris, que crece en Sudamérica y en Asia, y el pelitre o piretro, especie de margarita que se cultiva en Kenya, Francia, Yugoslavia, Suiza y hasta en Checoslovaquia.
Las raíces del derris y las flores secas de pelitre se molían y, como dicen los químicos, se complementaban con talco y carbonato de calcio. Así se producían los polvos para proteger las plantas. Sin embargo, no duró esto mucho tiempo, pues los agricultores se dieron cuenta de que, a pesar de que espolvoreaban concienzudamente el producto en sus campos, seguían sufriendo pérdidas en sus cosechas. El polvo no tenía ningún efecto sobre algunos insectos. Ciertos pulgones seguían pululando en las plantas útiles. Lo que hicieron los agricultores fue dirigirse a los biólogos y a los químicos. No se conocía todavía una de las propiedades de estos enemigos secretos del hombre: la facultad de acostumbrarse a la preparación mortífera, o sea la resistencia del insecto. Pero inventaron una nueva arma contra su gran enemigo.

Figura 20. Molino de bolas para pulverizar las plantas secas utilizadas contra los parásitos de las plantas. En molinos de esta clase se pulverizan también en colorantes y otras materias.
Durante la primera guerra mundial, los químicos militares de cada uno de los dos frentes trataban de inventar un gas de combate más eficiente que el de los otros. Los metcorólogos esperaban un viento favorable y los comandantes también. Se oyeron las órdenes, los tanques llenos de los más horribles gases se abrieron y, sobre las alas de la brisa que en todo tiempo cantaron los poetas del mundo entero, empezó a volar una muerte despiadada. Los gases de combate penetraban en el cuerpo humano por los pulmones y sembraban la muerte. Mataban al hombre, pero no mataban las plantas. ¿Cómo es posible? -se preguntaron los químicos. ¿No penetra el gas venenoso en la planta como penetra en el cuerpo humano? Las plantas tocadas por los gases de combate fueron examinadas: se descubrió veneno en ellas como en el cuerpo humano. Pero la planta seguía viviendo y en unas semanas ya no tenía veneno. El insecto que vivía de ella, que extraía de ella el jugo nutricio, moría aunque no directamente atacado por el gas. ¿Se envenenaba el insecto? y, en caso afirmativo, ¿cómo se envenenaba? -se preguntaban los químicos. Pronto pudieron contestar. La respuesta fue simple y asombrosa. Se alcanzó uno de los más grandes inventos de la química al servicio del hombre en su lucha contra el mundo secreto de sus enemigos, los insectos: se inventaron los famosos agentes "sistémicos" para defender las plantas. Pues se descubrió que la planta salpicada o rociada de ciertos cuerpos venenosos, absorbe y reparte tales materias por todo su cuerpo, con lo cual, de hecho, matan los parásitos sin dañar la planta. A estos compuestos químicos los llamamos agentes sistémicos. ¿Por qué? Porque circulan por todo el organismo o -más científicamente hablando- por el "sistema" de la planta. Hacen efecto aun en disolución muy diluida y persisten en los jugos de la planta hasta seis semanas. Durante este tiempo son como soldados que defendieran las plantas contra los insectos. Sin embargo, estos soldados no matan todo lo que encuentran.
5. La criada y las moscas muertas
Un día un químico suizo, el profesor Müller, recibió el encargo de inventar algún remedio eficiente contra las polillas. En aquella época la industria textil buscaba un colorante para telas de lana que repeliera las polillas.
El profesor empezó a trabajar en seguida: ensayó un producto químico tras otro, pero ninguno tuvo el efecto esperado. Entre muchos otros hubo un compuesto que tenía un nombre químico un poco largo: diclorodifeniltriclorometilmetano . Es un nombre horroroso, pero traten de descomponerlo así:
Examínenlo bien. Advertirán que aparecen dos veces "di", una vez "tri", dos veces "cloro" y además "fenil", "metil" y "metano", ya aprenderemos lo que es esto. (Nos las veremos con muchos otros términos complicados de química.)
No se trataba de ningún cuerpo compuesto nuevo. Los químicos lo conocían ya desde fines del siglo pasado.
El profesor Müller preparó este producto químico y lo puso en una probeta, exactamente como lo había hecho antes con los demás compuestos que usaba en sus experimentos. Colocó las probetas con los diversos productos químicos sobre su mesa de trabajo, pero la probeta del diclorodifeniltriclorometilmetano la puso en la ventana, sin ninguna intención especial, tal vez porque ya no cabía sobre la mesa, tal vez por distracción.


Figuras 21 y 22. Enemigos de los árboles frutales y su obra
Al día siguiente por la mañana esperaban al profesor dos sorpresas. La criada que se ocupaba de la limpieza del despacho del profesor, y que en general terminaba la limpieza mucho antes de que llegara él, esta vez estaba todavía barriendo afanosamente los alrededores de la ventana.



Figuras 23, 24 y 25
-Profesor, debiera usted quitar esta porquería de la ventana. Tiene una que quitar las moscas muertas. Mire cuántas hay aquí -y la criada le mostró el recogedor, donde se encontraba un montoncillo de moscas inmóviles. El profesor Müller empezó a examinar con interés las moscas y la probeta de la ventana y ya no escuchó más. Ni se ocupó tampoco de las demás probetas. Le interesaba la respuesta a esta pregunta:
6. ¿Por qué murieron las moscas alrededor del tubo?
Examinando los insectos muertos, el profesor Müller averiguó que el tegumento, los nervios y la grasa de las moscas se habían afectado: el compuesto contenido en la probeta puesta en la ventana del despacho del profesor era la causa de la muerte de innumerables moscas. Atacó nervios, tegumentos y grasa y así mató los insectos.
Se había descubierto el agente más eficaz para luchar contra los insectos, un insecticida de contacto: el DDT -para evitar el nombre largo de diclorodifeniltriclorometilmetano .
Lo llamamos insecticida de contacto porque el solo contacto del insecto con este veneno causa su muerte, aunque en el caso de algunos parásitos la muerte llegue más tarde, a veces hasta después de una semana. Sin DDT hoy no podemos imaginar una defensa eficiente contra el escarabajo de la papa, por ejemplo, que por poco destruyó, antes de la segunda guerra mundial, toda la cosecha de papa de Francia, y que se extendió rápidamente por Europa. Si no hubiera aspersiones de DDT, que utiliza cada aiío el buen hortelano para proteger sus árboles frutales de las orugas, los coleópteros y otros parásitos, tendríamos menos frutas, y muchas de las que tuviéramos estarían afectadas por alguna de las numerosas enfermedades cuyos autores son precisamente estos enemigos secretos del hombre: los insectos.
7. Manzanas distintas
Miremos dos manzanas del mismo árbol, cogidas en la misma época y almacenadas en la misma bodega. Una está sana, la otra agusanado.
Después de 5 meses y medio de estar en el almacén, la manzana sana resiste, aunque envejece, se debilita como una persona que se hace vieja. tiene o.25% de ácidos y 0.10% de azúcar menos que cuando la almacenamos. Y no sólo eso, cuando la comemos proporciona menos vitaminas que si estuviera fresca. Pero ¿qué le pasa a la enferma, a la manzana picada? La pobre pierde muchísimo: 50% de ácidos Y 32% de azúcar. ¿Ven de qué es capaz el gusanillo de la manzana?

Figura 26. ¿Dónde está la diferencia? Manzanas rociadas con una aspersión y manzanas que olvidamos de rociar.
8. Un avión en lugar de un delantal
El DDT no es activo contra todas las especies de insectos. Pero ahora el DDT ya no es el único insecticida de contacto. Conocemos por ejemplo otro insecticida de contacto muy eficiente, el HCH (hexaclorociclohexano), también llamado 666 o gammexano, muy activo contra acridios y sobre todo contra los animales nocivos que viven en el suelo: larvas y orugas.
La química ha encontrado un arma para luchar contra el mundo minúsculo de los enemigos de la humanidad, que tratan de arrebatarle lo que representa la base fundamental de su vida: el alimento. Sin embargo los parásitos no desaparecen, sobreviven, muchos se acomodan a las circunstancias y la lucha perpetua sigue.

Figura 27. El avión rocía aerosoles.
Ya no basta la bomba mecánica con la cual el agricultor cuidadoso rocíalos árboles con sustancias protectoras. Poco a poco desaparece de los campos la silueta del agricultor con su delantal, espolvoreando por el campo un puñado de polvo ceniciento.

Figura 28.
Contra los ejércitos de parásitos se lanzan hoy a la lucha aviones y helicópteros. Vuelan por encima de las grandes superficies de los campos y bosques, donde se guarecen los insectos, y lanzan aerosoles, nubes que contienen productos químicos que destruyen los parásitos. Pero se les agregan a aquéllos materias que ayuden a que los compuestos químicos se adhieran a las plantas: jabón, petróleo o aceite mineral, que es ahora el más eficiente de los "aditivos". Todos hemos visto alguna vez un avión de éstos. Vuela muy bajo encima del campo, de repente detrás de él aparece un velo blanco y fino que llega hasta el suelo, es la niebla de aceite mineral y las materias químicas activas, mensajeros de muerte que ayudan mucho al hombre en su lucha contra sus enemigos, sean insectos, mohos o malas hierbas. Tal vez el velo que vimos contenía DDT corriente con algunos litros de aceite mineral. Esto parece una verdadera guerra. Aviones y aerosoles; en lugar de tanques, grandes aparatos de aspersión; gases, venenos, muerte. Pero hay una gran diferencia: el hombre mueve esta guerra para que viva la humanidad, no para exterminarla.
9. Las plantas que crecen donde no deben

Figura 29. Mala hierba que crece entre los cereales
De la misma manera que el hombre se defiende contra los insectos nocivos, se defiende también contra las plantas. Un viejo proverbio checo dice: "La mala hierba se come el pan antes de salir del horno". Esta mala hierba nace junto a las raíces del trigo, del centeno y de otros cereales, y les arrebata materias indispensables para la vida de las plantas cultivadas. Hay muchas plantas parecidas así. Son propiamente plantas que crecen donde no deben. Roban la sustancia alimenticia a la planta cultivada, impiden que le lleguen la luz y el aire y a menudo traen parásitos y enfermedades contagiosas. Y contra ellas el hombre solicita la ayuda de la química. Hace cien años la gente, que no tenía más recursos, echaba sal corriente a la mala hierba, para tratar de deshacerse de ella.

Figura 30. Estos frutos son la mejor recompensa, después de los cuidados concedidos a los árboles frutales durante todo el año.
Llamamos herbicidas a los productos químicos que matan las malas hierbas. La química actual ha inventado un herbicida que daña las plantas de hojas anchas (y las malas hierbas son plantas de éstas), mientras que no hace daño a las otras plantas (de hojas angostas): de éstas son los cereales. Por ejemplo, si rociamos un campo con ácido metilclorofenoxiacético, destruimos la mala hierba y no le pasa nada al trigo, éste se deshace de un gran enemigo que lo ahoga.


Figuras 31 y 32. Herbicidas e insecticidas
10. "Cida" significa muerte
Hablemos más de nuestros aliados del imperio sin límites de la química, que ayudan al hombre. Ya conocimos el cobre, escondido en el sulfato de cobre. Mencionemos uno de los más antiguos productos utilizados para proteger las plantas: el azufre, que en polvo fino echamos a la planta atacada por parásitos; al quemarlo se produce un óxido sulfuroso que destruye los filamentos del hongo. Las preparaciones químicas a base de mercurio se mezclan en cilindros giratorios con las semillas antes de sembrarlas: con eso se destruyen gérmenes de enfermedades infecciosas que de otra manera penetrarían en la tierra y luego en las nuevas plantas.
Otros productos químicos importantes para proteger las plantas son, entre otros, el arsénico -veneno violento-, el fósforo, el sulfuro de carbono, derivados antracénicos, nicotina y otros. Son toda una serie, y asociados a otras materias químicas sirven como herbicidas, fungicidas e insecticidas.
Acaso olvidemos alguna de estas palabras. Pero seguramente no olvidaremos que todas terminan en "cida". Esto se refiere a la muerte que causan estos productos químicos a las malas hierbas, a los mohos y a los insectos. Sin saber latín se ve que herba es hierba, fungus , hongo, e insectum insecto. No son palabras difíciles: los herbicidas eliminan las malas hierbas, los fungicidas combaten las enfermedades causadas por hongos y los insecticidas destruyen los insectos.
11. Hojeemos un formulario químico
La preparación de materias químicas para proteger las plantas varía en complicación desde la receta sencilla del caldo bordelés -en la que, si acaso, será necesario recordar que hay que echar el sulfato de cobre encima de la cal y no al revés- hasta la producción compleja realizada en la fábrica.
¿Qué pasaría si nos pusiéramos a preparar DDT? ¿Piensan que lo lograríamos? Tal vez. Sin embargo, en 1873, mucho antes de que el hombre hubiera reconocido en el producto un enemigo mortal de las moscas, un estudiante austriaco de química, llamado Othmar Zeidler, había recibido el problema. El profesor con el cual Zeidler debía pasar su examen final, escribió una fórmula en un pedacito de papel y dijo: -Hasta ahora nadie ha producido esta sustancia química. No quiere decir que no exista. Ésta es su fórmula, trate de producirla; si le sale bien, le servirá en su prueba final.
Aquella tarea no le cayó muy en gracia; sin embargo, se puso a trabajar y hasta ahora se sigue encontrando su nombre en muchos manuales de química. Vale la pena saber lo que hizo Othmar Zeidler o lo que se hace en la fábrica.
"Para producir DDT se necesitan tres materias primas fundamentales: benceno, alcohol etílico y cloro" -algo así decía el examen final de Othmar Zeidler.


Figuras 33 y 34. Esquema de una retorta
Si simplificamos mucho las cosas, podemos afirmar atrevidamente, y al mismo tiempo con toda razón, que el DDT es en verdad un derivado de la hulla, de la papa y de la sal. El profesor que examinó a Zeidler ¿le puso en la mano pedazos de hulla y de papa y un salero? Claro que no.


Figuras 35 y 36. La destilación seca se realiza en estos gigantes metálicos. · Cargando las retortas con carbón.
Para su experimento, Zeidler partió de veras del benceno, del alcohol etílico y del cloro, exactamente como ponía en su examen. Sin embargo, es cierto que estos cuerpos compuestos provenían de tres cosas que conocemos bien: el benceno, de la hulla; el alcohol etílico -alcohol medicinal-, de la papa; el cloro, de la sal corriente. Ya que no lo podemos hacer solos, vamos a la fábrica a ver cómo se las arreglan allá. Primero veamos cómo se produce el benceno.

Figura 37. Es necesario averiguar con un pirómetro óptico si la retorta ha alcanzado la temperatura debida. Las llamas de los quemadores de gas calientan las paredes de la retorta.
Llegamos precisamente cuando sacan el coke caliente del gran recipiente de acero que se llama retorta. Le echan mucha agua para que no arda. Esto es extraño. ¿Por qué no ardió en la retorta, ya que echa tanto humo, y por qué ardería al aire libre? Pues porque las retortas son un sistema de destilación seca y no de combustión. No hay oxígeno dentro de estos gigantes de acero que se cargan con hulla. La hulla no arde en las retortas, calentadas por fuera. Así la hulla se calienta hasta que desprende un gas. Y este gas sale por un conducto y entra en contacto con agua. Los sedimentos que quedan se llaman alquitranes.

Figura 38
12. El alquitrán es más precioso que el oro
En la época de nuestros abuelos tiraban estos alquitranes, pues olían mal y donde los tiraban no crecían plantas. Hoy no podemos imaginar de ninguna manera la producción de colorantes y medicamentos sin el alquitrán. Y precisamente en estos alquitranes separados del agua, existe uno de los ingredientes fundamentales de la química orgánica: el benceno.
Pero de momento lo que tenemos es maloliente alquitrán. Es decir, debemos hacer otra destilación para obtener lo que buscamos: benceno. Esta vez no será una destilación seca, sino que calentaremos el alquitrán hasta cierta temperatura; en momentos definidos empezarán a vaporizarse las materias, una tras otra. Cada sustancia tiene un punto de ebullición diferente, más bajo o más alto, pero fijo; llegado el momento, comienza a evaporarse y se la puede recoger en el condensador o refrigerante, que es un aparato enfriado con agua. Los vapores de benceno siguen el mismo camino que los de los demás compuestos desprendidos al calentar el alquitrán de hulla. Éstos también pasan al condensador. Así obtenemos la primera materia fundamental para preparar el DDT.
Ahora es necesario procurarse el alcohol. Lo obtendremos de las papas. Primero se machacan y luego se les agrega cebada germinada y pulverizada que se llama malta. Este pequeño hechicero, que desempeña un papel tan importante en la producción de la cerveza, no nos defrauda en la producción del alcohol: es tan potente que transforma en azúcar el almidón de las papas. A esta azúcar basta agregarle levadura para que se vuelva alcohol y anhídrido carbónico. Luego nos debe ayudar de nuevo uno de los más importantes servidores de la química, que ya conocemos: la destilación. Con la destilación conseguimos sólo alcohol impuro. Se purifica y se destila de nuevo. Entonces conseguimos la segunda materia que necesitamos para la producción del DDT: alcohol etílico.
13. Petróleo en lugar de papas

Figura 39. Estación final de un oleoducto. De estas torres de destilación se obtienen bencina y otros productos del petróleo.
Sólo entre nosotros: obtener alcohol de las papas es hoy como escoger el peor de dos males. Es un derroche imperdonable. Las papas se aprovechan más útilmente para la alimentación del hombre o para engordar animales domésticos. Hoy el alcohol se obtiene más económicamente del petróleo crudo. De este líquido espeso y oscuro que viaja por largos conductos, los oleoductos.
Los químicos hacen con el petróleo crudo algo parecido a lo que se hace con la hulla, al destilarla en seco. Lo descomponen por medio del calor, hasta alcanzar temperaturas elevadas, pero otra vez sin entrada de aire. Este proceso químico se llama cracking . Bajo el efecto del calor el petróleo se descompone en, cuerpos compuestos de carbono e hidrógeno, más simples: lo que se llaman hidrocarburos inferiores. Son otras "piedras de construcción" de la química orgánica. Naturalmente, no obtendríamos alcohol etílico con sólo recibir en agua el gas producido durante el cracking , como lo hicimos en el caso de la destilación seca. Ahora no se trata de eso. Pero lo importante es saber que el alcohol etílico -o alcohol, a secas- se puede obtener más económicamente de otras materias primas, y no de la papa; la mejor fuente es el petróleo crudo.

Figura 40. No se utiliza sólo un reactor para la fabricación del DDT sino toda una serie. En éstos se realiza la condensación del clorobenceno con el cloral, con la ayuda del ácido sulfúrico.
Ya tenemos, pues, dos materias primas fundamentales, necesarias para la producción del DDT: benceno y alcohol.
Sabemos que la sal común es un cuerpo compuesto de cloro y sodio: cloruro de sodio. Para conseguir la tercera piedra de construcción que necesitamos para producir DDT, el cloro, necesitamos la ayuda de la corriente eléctrica. Por su acción -esto se llama un proceso electrolítico- obtenemos una disolución y un gas. La disolución, que tiene el nombre químico de hidróxido de sodio, es una materia prima importante, sin la cual no se podrían producir fibras sintéticas. El cloro es un gas venenoso, amarillo verdoso y pesado. ¡Se han hecho muchas cosas malas con el cloro! Durante la primera guerra mundial se utilizó como gas de combate, y los ejércitos enemigos trataron de exterminarse mutuamente con él.
Ahora hemos llegado a donde estaba Othmar Zeidler, aquel estudiante austríaco con gafas, cuando el profesor le escribió la fórmula del diclorodifeniltriclorometilmetano y quiso que preparase este compuesto químico. Pero dejemos los frascos de Zeidler.
Están ustedes invitados a una de las fábricas donde se produce el DDT, para que vean cómo se prepara en grande.
14. Pistas y DDT
Llegamos ante una gran caldera esmaltada donde se fabrica el DDT. Tiene paredes dobles entre las cuales circula una salmuera. Así es también el sistema de refrigeración que produce hielo artificial en las pistas de patinar. Allí circula en tubos debajo de la pista. Pero ahora fijémonos en lo que hay en la caldera: 1) clorobenceno, que se obtuvo del cloro y el benceno; 2) cloral, que se obtuvo por cloración -o sea por acción del cloro- del alcohol. En la caldera hay cantidades precisas de los dos productos. ¿Qué es esto que está encima de la caldera? Un recipiente graduado lleno de ácido sulfúrico que va cayendo dentro de la caldera. La salmuera se ocupa de controlar la temperatura dentro de la caldera; no debe pasar de 0°-5° C. Todo lo que se encuentra en la caldera es mezclado íntimamente por un gran agitador. Lo que pasa en la caldera es una especie de boda química: se unen las moléculas de cloral con las de clorobenceno. Apenas termina esta boda, emprendemos una gran limpieza: dentro de la caldera separamos la capa inferior del resto de la disolución. ¿Cómo? Con agua corriente. Echamos más y más agua en la caldera, hasta que desaparece el sedimento del fondo. Luego introducimos allí vapor de agua que arrastra el clorobenceno que quedaba todavía; en las paredes de la caldera queda una materia fundida, es el DDT de Zeidler, el terrible diclorodifeniltriclorometilmetano del profesor Müller y de su criada, causa de la muerte de decenas de moscas en la ventana del despacho del profesor. Nada más fácil que sacar la materia fundida del fondo de la caldera, echarla en moldes y luego -ya solidificada- molerla o disolverla en otra sustancia química o disolvente. Así se produce el DDT en la fábrica, uno de los medios más eficientes para exterminar los insectos.

EL ENCANTO DE LOS COLORES
Contenido:
1. El poeta y el mar
2. Una vez más el espectro, y diversos artefactos
3. El César y el molusco
4. Los secretos de los colores de las plantas
5. La muerte del capitán Périllat
6. El hombre pintor
7. Color en lugar de medicina
8. Los ganchitos de plata en el escudo
1. El poeta y el mar
Estábamos sentados en la orilla del mar Adriático, el Sol se acercaba lentamente a las cumbres de las montañas de las islas de enfrente, el mar estaba silencioso y tranquilo. Había un poeta entre nosotros.
-¡Qué juego de colores más maravilloso! -exclamó, y mostró el mar profundo debajo de nosotros-. Se ve hasta el fondo. Qué raro; mientras más profunda, más azul es el agua.
El Sol tocó el pico más alto de la cordillera que atravesaba la isla, delante de nosotros. El poeta, lleno de admiración ante la belleza que descubría de nuevo aquel día, después de tantos años, no cesaba de asombrarse.

Figura 1. Los rayos del Sol atraviesan el prisma de vidrio, se descomponen y exhiben el espectro solar. ¡Qué abanico de colores tan variados puede crear un pedacito de vidrio!
-¿Ven aquel juego de colores? -preguntó de nuevo, pues ninguno de nosotros le contestaba.
El poeta inquieto corrió hacia el agua, la tomó en la mano, estaba límpida. Aunque se hubiera zambullido hasta el fondo, el agua no sería diferente, a pesar de que nos parecía azul como el zafiro en la profundidad.
¿Veíamos todos mal?
Al anochecer nos sentamos en la terraza; hacía mucho tiempo ya que el Sol se había puesto detrás de las montañas, de las islas e islotes repartidos por el mar. El poeta quiso saber por qué le pareció -y a nosotros también- el agua más azul donde es más profunda. Entonces nos enteramos de lo que es el color y el espectro luminoso, y también de por qué el agua, en las grandes profundidades, parece ser azul. Escuchen lo que nos contó un joven técnico:
-Tendré que desilusionarlos -dijo-, no existe ningún color.
Se quedó callado un momento, como si quisiera ver si nos había sorprendido mucho con su noticia.
-¿Qué dice usted? -preguntó el poeta-. Estuvo con nosotros; ¿quiere decir que no vio lo mismo que nosotros?

Figura 2.
-No quiero decir eso. Vi como ustedes la puesta del Sol rosada, el cielo azul claro, las rocas grises en las islas, el agua azul a lo lejos. Y sin embargo debo insistir en lo que dije: no existe ningún color. Lo que percibimos como color es sólo una impresión del ojo, causada por la excitación de la retina por la luz. Todos los colores no son más que impresiones de nuestro ojo y no existen en realidad.
-Pero ¿cómo es que vemos el rojo, el verde, el azul o el negro? -preguntó el poeta, que seguía sin entender.
-Lo mejor sería que les hiciera un experimento. Pero para eso necesitaría, por ejemplo, la luz del día y un prisma triangular de vidrio. Pero desgraciadamente no tengo ninguna de las dos cosas en este momento. Pero podemos imaginárnoslo fácilmente.
El poeta fijó los ojos con curiosidad en el joven. Éste siguió hablando:
-Imagínense un pedazo de cristal, pulido en forma de prisma triangular. Nuestro experimento se debe realizar en un lugar oscuro, en el cual dejamos entrar un rayo de luz del Sol hasta un papel blanco, de modo que antes atraviese un prisma. ¿Qué creen ustedes que aparece en el papel?
-¿Qué va a aparecer?, la luz del Sol -dijo el poeta sin reflexionar mucho.
-¿La misma que se ve afuera? -preguntó el técnico.
-Claro que sí -contestó el poeta.
-Es lo que usted cree. En el papel blanco aparece de veras la luz del Sol, pero descompuesta: es lo que se llama espectro solar, algo como un abanico de colores. Allí se encuentran todos los colores del arco iris: violeta, añil, azul, verdiazul, verde, amarillo, anaranjado, rojo. Pasan los colores gradualmente uno a otro. ¿Qué ocurre exactamente? ¿Por qué vemos estos rayos de colores con el prisma de cristal y por qué no los vemos sin este pedacito de cristal corriente? La respuesta es sencilla. Los rayos luminosos no atraviesan directamente el prisma, sino que sus trayectorias se desvían, como si algo los apartase de su camino inicial. El violeta se desvía más, el rojo menos. El prisma descompone simplemente el rayo de luz, constituido por rayos de varios colores. Imagínense esto, más o menos: el rayo del Sol es un haz de flechas que se diferencian no sólo por el color sino también por la longitud y la estabilidad de la trayectoria. Las menos estables se retractan más que las demás, en cuanto se topan con un obstáculo. Esto depende de las propiedades del objeto que se encuentra en el camino del rayo del Sol. Algunos objetos son de tal naturaleza que todos los rayos, o casi, se reflejan en ellos. Por otra parte, hay objetos que absorben todos los rayos. ¿Cómo reacciona nuestro ojo a la interacción de los rayos con el obstáculo que se interpone en su camino? De diferentes maneras: si los rayos topan con un objeto que los absorbe a todos, el objeto nos parece negro. Si todos los rayos se reflejan en el objeto, lo vemos blanco.
-¿Y qué pasa cuando el obstáculo con el cual topan los rayos, absorbe una parte de ellos y refleja otra parte? ¿Cómo se nos presenta tal objeto? -preguntó uno de nosotros.
-Depende de qué rayos absorba el objeto, de cuáles deje pasar y de cuáles refleje. Si por ejemplo absorbe los rayos rojos del haz de rayos luminosos, tenemos la impresión de que el objeto es verdiazul. Si absorbe los amarillos, lo vemos azul; si absorbe los azules y los verdes, el objeto nos parece ser rojo. En resumen: el color del objeto con el cual topa la luz del Sol depende del color de los rayos que interactúan con la composición química del objeto. El carbón es negro porque absorbe todos los rayos luminosos, el papel es blanco porque no absorbe ninguno, este vidrio es verde porque absorbe todos los rayos menos los verdes. Naturalmente, la absorción de los rayos no se efectúa de una vez por todas: es más considerable en capas gruesas del objeto iluminado que en capas delgadas, y aquí tienen la respuesta a la pregunta que me hicieron: por qué el agua nos parece límpida en una pequeña profundidad y azul en las grandes profundidades. Simplemente porque mientras más profunda es el agua, más absorbe los rayos.
-¿Entonces la luz del Sol se compone de sólo siete colores, como el arco iris?
-De ninguna manera. Es que el ojo humano no los puede percibir todos. En la luz del Sol hay otros rayos, invisibles al ojo humano; los llamamos ultravioletas e infrarrojos. Son mucho más numerosos que los que podemos ver.

Figura 3. Los elementos colorean la llama del mechero Bunsen.
El asistente técnico calló. Asomó la Luna sobre las rocas y su luz amarillenta se derramó sobre la superficie del mar debajo de nosotros. El poeta nos dio las buenas noches y se acercó a la orilla del mar, donde las olas doradas por la Luna se estrellaban con furia contra las rocas grises y silenciosas. Fue a consolarse con el encanto de los colores de una noche de Luna en la orilla del mar. No le importaba nada saber que los colores eran sólo impresiones que reciben los ojos. Le daba gusto saber que el hombre tiene la facultad milagrosa de percibir el encanto de colores que no existen de veras.
2. Una vez más el espectro, y diversos artefactos
Dejemos al poeta a la orilla del mar y por un momento retrocedamos más de un siglo, en la pequeña universidad de la ciudad alemana de Heidelberg. Allá vive -no se olviden que estamos en 1858- el profesor de química Robert Bunsen. El mundo ya sabe de él; por primera vez habló del profesor alemán cuando éste ideó el mechero que aún lleva su nombre. El invento del químico de Heidelberg no pareció ser ningún milagro: un tubo de metal corriente sobre un pie al cual llega el gas por una tobera de metal y el aire por un orificio lateral. Cuando se aplica un cerillo encendido a la parte superior del tubo y se hace salir el gas, se enciende con una llama casi incolora. Pero precisamente esta llamita es un pequeño milagro: se desarrolla en ella una temperatura que llega hasta 1800° C.
¿Para qué necesitaba el profesor Bunsen una temperatura tan elevada? Muchos grandes inventos tienen su origen en una idea muy simple. Bunsen quería saber cómo se conducirían diversas materias químicas a altas temperaturas. Para realizar sus experimentos, además del mechero construyó unas pincitas de platino muy sutiles -dos hilillos con un anillo en la punta- y con ellas sujetaba el producto químico y lo mantenía en la llama. La sal común fue la primera sustancia que ensayó. En cuanto la puso con las pincitas encima del mechero, la llama se puso amarilla. El profesor sabía que la sal o cloruro de sodio era un cuerpo compuesto de cloro y sodio. ¿Cuál de los elementos del cloruro de sodio hacía que la llama incolora se pusiera amarilla? ¿El cloro o el sodio? El hilillo de platino solo no colorea la llama.
¿Qué hubieran hecho ustedes para averiguarlo? Sin duda hubieran escogido un producto químico que contuviera sodio sin cloro, o al contrario, cloro sin sodio, para saber exactamente cuál colorea la llama.
El químico de Heidelberg escogió el carbonato de sodio, que contiene sodio pero nada de cloro. Lo sostuvo con las pincitas de platino y lo puso en la llama. No tuvo que esperar: la llama se puso amarilla. Pero esto no le bastaba todavía al químico concienzudo y prudente para afirmar definitivamente que el sodio colorea siempre la llama de amarillo. Sólo cuando se convenció, después de varios experimentos, que aun el sodio puro colorea la llama de amarillo, se atrevió a afirmar que así se puede reconocer el sodio sin tener que hacer ningún experimento complicado: cuando no estamos seguros de que algún producto químico contiene sodio, lo ponemos en una llama de alta temperatura. Si la llama se pone amarilla, el producto químico contiene sodio.

Figura 4. Mechero de Bunsen
Naturalmente, Bunsen ensayó de esta manera una serie de compuestos químicos de lo más variados, y así averiguó que el potasio colorea la llama de violeta, el cobre de verde, etc. Fíjense que se trata siempre de elementos. Bunsen logró siempre descubrir su presencia según el color que tomaba la llama del mechero.
Pero ¿cómo averiguar cuáles son los elementos que se encuentran, por ejemplo, en las disoluciones de sales? Otra vez empezó con la sal común. Encendió tres mecheros; en la llama del primero puso las pincitas con una gota de una disolución de sal común pura, en la del segundo una gotita de una solución de sal a la cual agregó litio, en la del tercero una gotita a la cual agregó potasio. Esperaba impacientemente ver el color de las llamas. Pero esta vez el profesor Bunsen se quedó desilusionado: las tres llamas se pusieron amarillas, no se podían distinguir. Era como si la coloración roja que emite el litio y la coloración violeta del potasio desaparecieran ante la intensidad amarilla del sodio. El ojo humano no percibía más que el color amarillo, pero el rojo del litio y el color violeta del potasio tenían que estar en alguna parte, no podían haber desaparecido. Entonces el profesor Bunsen se dijo: utilizaré un filtro para ayudarme. Disolvió un colorante en un tubo y empezó a mirar las llamas de los tres quemadores, a través del tubo, que actuaba como filtro. Y con alegría vio que la llama en la cual había puesto la gotita de solución de sal común y litio estaba roja como la frambuesa, y la llama con la gotita de sal y potasio estaba púrpura. Sólo la llama obtenida cuando con las pincitas se tomaba la gotita de sal común pura desaparecía completamente.
El químico de Heidelberg conocía el espectro luminoso, y también sabía lo que acabamos de conocer, gracias al joven técnico, a la orilla del mar, acerca de la absorción de los colores. Así se explica fácilmente por qué no se ve el color amarillo de la llama cuando se mira a través de la disolución azul: simplemente el colorante azul absorbe los rayos amarillos de la llama del mechero y ayuda al ojo humano a ver los matices rojos que no podría percibir de otra manera.
Bunsen se entusiasmó; creyó haber encontrado la llave de uno de los grandes secretos de la química: cómo determinar la presencia de diversos elementos con la ayuda de la llama y de cristales de colores.
Pero esta vez su alegría fue prematura. A pesar de toda su serie de filtros en colores, no pudo averiguar la composición de algunos cuerpos mediante su método. Es que a veces aparecían los mismos colores en la llama, aunque se tratara de cuerpos de composición química completamente diferente. No le sirvió de nada ponerse delante de los ojos cristales de todos los colores.
En aquellos momentos de incertidumbre desesperante, otro profesor de la Universidad de Heidelberg, el físico Kirchhoff, ayudó al químico. Pensó también en el espectro luminoso y razonó así: la luz del Sol que atraviesa el prisma triangular de cristal exhibe los colores que lo componen; la luz de la llama en la cual ponemos alguna materia química se debe descomponer también. Vamos a ver.
Un día lluvioso, el profesor Kirchhoff, llamó a la puerta del laboratorio químico de Bunsen. Debajo del brazo traía un paquetito cuidadosamente envuelto.
-Traigo algo para usted -dijo, y se limpió los zapatos lentamente, sin apresurarse de ninguna manera.
-Entonces pase, pase -respondió Bunsen con impaciencia.
Kirchhoff empezó a deshacer el paquetito lentamente. El químico miraba con curiosidad para ver lo que venía envuelto en los papeles, y cuando vio una de las cajitas en las que se solían vender los cigarros puros en aquel tiempo, dijo desilusionado:
-Gracias, pero hoy no tengo la menor gana de fumar -y, sombrío se volvió hacia la ventana.
Pensó que aquello sólo le hacía perder el tiempo.
El profesor Kirchhoff sonrió nada más.
-Aquí tiene para su... No había terminado de hablar siquiera cuando Bunsen le arrebató de la mano la cajita, que no tenía ningún cigarro sino dos tubos de metal.
-¿Qué es esto?
Kirchhoff empezó a explicarle pacientemente cómo había cortado unos gemelos en dos pedazos, cómo los había colocado en la caja de cigarros, formando el ángulo necesario; ante una de las aberturas Kirchhoff colocó una ruedecilla de cartón con un agujerito por el que penetraba la luz en la caja, dentro de la cual se encontraba nuestro viejo conocido el prisma triangular de cristal. Era posible hacer girar el prisma, y cuando el profesor Bunsen miró por el segundo tubo, que tenía dos lentes, vio con asombro un abanico de colores: el espectro. En seguida encendió el mechero y apuntó a él la caja de cigarros cargada con los pedazos de gemelos y el prisma de cristal. O sea que en realidad era un espectroscopio, y ya no una caja de cigarros con unos gemelos rotos. Así llamaron al aparato del profesor Kirchhoff, tosco pero de una importancia extraordinaria en la historia de la química.

Figura 5. Espectroscopio moderno. El profesor Kirchhoff se sorprendería de cómo se ha transformado su caja de cigarros.
Cuando el químico miró por el tubo, vio un espectro diferente del solar. En lugar de los colores del arco iris, fundiéndose gradualmente uno en otro, aparecieron líneas de colores netamente diferentes unas de las otras. Cuando Bunsen puso potasio en la llama, vio en el espectroscopio dos líneas rojas y una violeta. Cuando calentó el sodio vio una línea amarilla y cuando puso cobre en la llama con las pincitas de platino, hubo en seguida varias líneas: tres verdes, dos amarillas y dos anaranjadas. Lo que no podía ver el hombre a simple vista, lo percibía el sencillo aparato del profesor Kirchhoff -el espectroscopio- exacta e infaliblemente. Aún hoy llamamos análisis espectral a este modo simple que utilizaron los dos profesores de Heidelberg, un físico y un químico, para averiguar la composición química de diversas materias. Seguimos usando el aparato inventado por Kirchhoff. Naturalmente, ya no es una caja de cigarros, un vidrio y unos gemelos rotos, sino un espectroscopio perfecto construido en una fábrica, gran ayudante del químico.
3. El César y el molusco
Ya sabemos bastante acerca de los colores, que son impresiones producidas por una excitación del ojo; sabemos que la descomposición de la luz aparentemente simple revela el espectro solar, y también lo que es un espectroscopio. Pero nos falta hablar precisamente de uno de los capítulos más interesantes de la química: los colorantes y la tinción, que trata de la preparación de las materias que ayudan al ojo a ver los colores.
Hojeemos viejos libros para ver cómo trató el hombre de imitar a la naturaleza desde tiempo inmemorial, cómo trató de dar colores a sus vestidos y a las cosas. Esta vez no abriremos ningún voluminoso libro de química, ni siquiera las notas poco comprensibles de los alquimistas que buscaban el secreto de la fabricación del oro.

Figura 6. Los barcos de los antiguos fenicios se hacen a la mar inmensa.
Abramos un libro de poemas de uno de los más grandes autores romanos: Publio Ovidio Nasón, los Fastos . Busquemos la caracterización del cortejo de los cónsules, delante de los cuales marchan doce lictores portadores del emblema del poder consular: un haz de varitas. En las hogueras del sacrificio, ante el templo de Júpiter, en el Capitolio, se oye un crepitar y huele el azafrán, y el resplandor de la llama ilumina el techo de bronce del santuario. Es el primero de enero, el cortejo solemne se acerca al templo.

Figura 7. La ciudad de Tiro, uno de los puertos más antiguos del mundo, al cual no era grato acercarse. Muy lejos llegaba la fetidez de los moluscos, de los cuales se extraía el colorante púrpura en calderas.
La procesión avanza hacia el Capitolio, el pueblo lleva sus ropas de ceremonia, vestidos limpios y blancos de fiesta. Delante van los lictores y detrás de ellos la púrpura de los cónsules.
La púrpura de los cónsules...
¿Por qué llevaba el pueblo ropa blanca y por qué estaban los cónsules vestidos de púrpura? La explicación es simple. La púrpura -y bajo este nombre se incluían colores de todos los matices desde el morado hasta el rosado- era el color de los más altos funcionarios del Estado romano. Era el color del emperador romano y de los cónsules. Pertenecía a los emblemas de su dignidad, pero era también testimonio de su riqueza.

Figura 8. Moluscos productores de púrpura
En las épocas de los emperadores romanos, la gente no conocía los colorantes sintéticos baratos que tenemos nosotros. Los antiguos romanos obtenían a duras penas, y a precio elevado, colorantes provenientes de los cuerpos de animales y plantas. Y el colorante purpúreo con que teñían los mantos de los emperadores romanos provenía de los cuerpos de pequeños moluscos marinos: las púrpuras o múrices. Pero los que descubrieron este colorante no fueron los romanos. Este hallazgo llegó a ellos desde la ciudad de Tiro, pasando por Grecia. Tiro, considerado uno de los más antiguos puertos del mundo, si no el más antiguo, se encuentra en la faja de litoral entre el actual Líbano y el mar Mediterráneo, lo que se llamaba Fenicia. Allí, muchísimos años antes de nuestra era, los antiguos fenicios pescaban con redes menudos moluscos marinos con conchas de hermosos colores. Estos animalitos, los múrices, tienen junto al hígado una glándula que contiene un líquido que al aire adquiere color rojo oscuro. Como los moluscos eran pequeños, no era posible sacarles el jugo uno por uno; por eso los fenicios los trituraban, luego les echaban sal y después de algunos días los cocían en calderas. Separaban la carne y quedaba un zumo incoloro, que sólo al aire, por acción del oxígeno, se ponía amarillo, rojo y finalmente púrpura. Pero los fenicios no se contentaban con el producto así obtenido: lo mezclaban con el colorante de otro molusco o incluso con miel. Muchos de ellos guardaban celosamente sus secretos de producción que los ayudaban a producir colorantes de otros matices que los de sus vecinos. Sin embargo, estos colorantes eran extraordinariamente caros. Para obtener sólo un gramo de púrpura, eran necesarios unos diez mil animales. No es raro, pues, que sólo el emperador de Roma y sus más altos funcionarios pudieran permitirse la ropa de color púrpura.

Figura 9. Cochinilla del nopal. Después del descubrimiento de América esta cochinilla llegó a ser para los tintoreros europeos una materia prima con la cual se fabricaba un colorante caro.
Hablemos ahora de otro colorante extraído también del cuerpo de un animal y que conocieron los europeos casi dos mil años después de que los fenicios preparaban la púrpura del múrice.
Después del descubrimiento de América, algunos conquistadores se fijaron que había en los cactos del Nuevo Mundo, unos insectos pequeños, parecidos a la chinche. Recibió el insecto el nombre de cochinilla. Los conquistadores se dieron cuenta también de que la hembra del insecto, de cuerpo gris, tiene entrañas rojas. Empezaron a recogerlas, secarlas y triturarlas, y así pronto en los mercados europeos apareció un colorante, raro en aquel tiempo y por eso caro, la cochinilla.
4. Los secretos de los colores de las plantas
Con la riqueza creciente aumentó también el número de personas que suspiraban por ropas de bellos colores. La gente buscó cómo conseguir colorantes distintos de los caros, extraídos de los cuerpos de animales. Los buscaron y los encontraron, esta vez en las plantas. El hombre descubre poco a poco un secreto tras otro. Las plantas, junto a las que pasaban hasta entonces sin hacerles caso, se volvieron de repente un centro de interés.
Ya en la Antigüedad se sabía, por ejemplo, que se podía obtener un bello colorante rojo de la rubia tintórea, cuyas raíces se secaban y molían. Con los estigmas secos de] azafrán, los tintoreros de la Edad Media producían un colorante amarillo. No olvidaron ni siquiera el liquen de tornasol, que crece en las rocas a orillas del mar y que servía para obtener un colorante azul. Y el Talmud, libro religioso de los antiguos judíos, prohíbe y considera pecado cortar el añil de menos de tres años. Ya hace dos mil años que los judíos sacaban de esta planta, procedente del Oriente, un colorante azul: el índigo o añil.
Consideremos un momento este colorante, pues el añil ocupa, por su belleza y su estabilidad -dos propiedades por las cuales suspiran todos los tintoreros- uno de los primeros lugares entre los colorantes.
5. La muerte del capitán Périllat
Sobre el empedrado de la ciudad de Nantes se apretujaba una multitud considerable. Las mujeres curiosas se ponían de puntillas, increpaban a las que estaban delante, cuyas tocas no les dejaban ver. A lo lejos se oía el estruendo sordo de los tambores.
-Ya vienen -dijo alguien. La muchedumbre se agitó con curiosidad. De una de las calles laterales salió la carreta del verdugo.
-Es él. Lo reconozco por la nariz aguileña -dijo una mujer a su vecina.
La carreta se acercó lentamente al centro de la plaza, donde se alzaba la horca. Los tambores cubiertos con paños negros retumbaron otra vez y el eco cavernoso sacudía los balcones de las casas de los ricos burgueses de la cuidad. El condenado, de perilla entrecana y rojiza, se enderezó, miró la muchedumbre curiosa y luego la horca de madera iluminada por el sol primaveral.
La carreta se detuvo. Dos ayudantes agarraron al reo, cuyas manos estaban atadas a su espalda con cuerdas gruesas, y lo arrastraron hacia el cadalso. Otra vez se oyeron los redobles. Las mujeres curiosas ya no decían ni una palabra; en la plaza reinaba el silencio.
-En nombre del más categórico de los monarcas, el Rey de Francia -leyó un representante regordete del poder real. Un golpe de viento primaveral lo interrumpió un momento, como si quisiera llevar a todos los rincones del mundo la severa sentencia.
- Por el hecho de que, a pesar de la severa prohibición, trajo al país de todos los franceses, en su barco llamado "Aurora", algo nocivo, inútil y por eso malo, llamado añil, el capitán del barco mencionado, Jean-Baptiste Périllat, ha sido condenado a la horca. Su nombre será borrado para siempre de todos los documentos y libros de a bordo y olvidado.
La voz del representante del Rey calló, de nuevo redoblaron los siniestros tambores. El condenado a muerte levantó la cabeza, quiso decir algo, tal vez el orgullo se lo impidió. De su boca no salió ni una sola palabra.
Era el año 1648; por última vez el sol de marzo tocó los tejados de la ciudad, a orillas del océano Atlántico, y antes de que cayera la noche se mecía en la horca de madera el cadáver del capitán de la "Aurora", que había contravenido a la prohibición del Rey y había traído a Francia desde la lejana India el colorante azul.
Para la gente del siglo XX la prohibición del Rey de Francia es incomprensible. Pero no eran sólo los reyes franceses quienes estaban convencidos de que el añil era nocivo. En aquella época no era posible llevar ni a Italia ni a Alemania el colorante fabricado en la India. Hasta el siglo XVIII los holandeses no decidieron abrogar aquella ley absurda, y entonces Europa pudo apreciar el colorante que ya conocían los egipcios, los judíos y algunos otros pueblos, ya 1500 años antes de nuestra era.

Figura 10.Ramillete de plantas tintóreas. No se trata de flores de bonito aspecto: eran materias primas que utilizaban nuestros antepasados para fabricar variados colorantes.
En el siglo XVIII, los holandeses empezaron a importar añil de la India, donde este colorante se extraía de una manera muy simple de la planta que lleva el mismo nombre. Metían hojas frescas en un agujero y les echaban agua. Bajo la acción de ciertas bacterias que viven en las hojas de esta planta, se producía una fermentación. Para estimular el proceso químico, los aborígenes removían la materia de fermentación con bambúes. Así tenía acceso el oxígeno; el tejido de las plantas, luego de haber formado una materia química muy compleja, dejaba que se disociase en varias sustancias colorantes y azúcar. Después de algún tiempo, se empezaba a depositar en las paredes una materia azulada. Sólo faltaba liberar el añil azul de partículas de otras materias coloreadas, rojas, pardas, amarillas. Para esto se cocía el añil bruto con agua. Así se destruían también las bacterias que hubieran podido provocar otra fermentación, ya no deseable. Para producir un kilo de colorante se necesitaban cien de hojas.
Sin embargo, todavía no se podía teñir con este índigo de la India. Es que no se disolvía en el agua. Pero los tintoreros de la Antigüedad sabían hacerlo. Pensaban que si el añil solo no se disolvía en el agua, tal vez se disolvería en compañía de alguna otra materia química. Y en efecto, encontraron el mediador entre el colorante y la tela por teñir.
El procedimiento ideado, en el que se usaba cal, causaba la "reducción" (lo contrario de la oxidación) del colorante insoluble, haciéndolo soluble. En esta reacción entraba hidrógeno en el colorante. Pero el oxígeno -oxidante por excelencia- no se daba por vencido. Como se encuentra en el aire, en cuanto el tintorero sacaba el tejido de la tina, el oxígeno empezaba a actuar sobre la forma reducida del añil, oxidándola y haciendo aparecer de nuevo el color azul.
El ingenio humano descubrió además que agregando al colorante sales de algunos metales, como por ejemplo el hierro, el cobre, el cromo o el aluminio, no sólo se liga el colorante al tejido, sino que además (aun que se trate de sales incoloras) la tela adquiere toda clase de colores nuevos.

Figura 11.
Hace un momento hablamos del colorante de las raíces de rubia o granza. Si se agrega una sal de aluminio a dicho colorante, un tejido de algodón se teñirá de rojo. Pero si en lugar de una sal de aluminio se usara una de hierro, se obtendría un color violeta, y si se mezclaran las dos sales -de hierro y de aluminio- y se agregaran al colorante de la granza tintórea, se podría teñir de pardo un tejido de algodón.
Como ven ustedes, las sales de metales no se conforman con ser modestos mediadores entre el colorante y el tejido, sino que, en colaboración con el colorante, influyen sobre el color que tomará el tejido.
El tintorero moderno debe saber teñir todo: lana y algodón, papel y caramelos, lápices, materias sintéticas, hule, aceite, medicinas, tintas o lápices labiales. Los químicos han descubierto cómo teñir sin tener que remojar en el colorante el objeto. Basta dispersar partículas del colorante directamente en la materia. Así se tiñe el papel, por ejemplo. De una vez se agrega el colorante a la pasta de celulosa con la que después se hace el papel, y ya no es necesario teñir éste. También se puede agregar al colorante un vehículo, como alcohol u otro disolvente, que se adhiere junto con el colorante al objeto. La pintura mezclada para ventanas y puertas es un ejemplo de unión de colorante y vehículo, sin el cual el colorante no se adheriría a la madera.
6. El hombre pintor
El hombre es por naturaleza un ser curioso. Busca, observa, inventa. No se contenta sólo con lo que le ofrece la naturaleza; transforma sus dones de una manera que a primera vista parece increíble. Vimos cómo aprovechó el pequeño múrice o el añil y cómo agregó los colores que preparó por su cuenta a los proporcionados por la naturaleza. Pero también entre los minerales encontró el hombre una gran cantidad de colores, como la cal para blanquear los muros. Moliendo la limonita -mineral que se utiliza también para la producción de hierro- y luego calcinándola, se obtiene un colorante rojizo, el ocre. El sulfato de cobre, que mencionamos al hablar del profesor francés Millardet, quien, precisamente con la ayuda de esta sal cuprífera, salvó la vid de la plaga, es también un colorante, pero malo, pues no se adhiere a nada.

Figura 12. Fragmento de un sarcófago egipcio. Hasta hoy, los colores no han perdido intensidad.
Nuestros antepasados conocían muchísimos minerales con los cuales obtenían colorantes. Cuando abrieron las pirámides de los antiguos faraones egipcios, los arqueólogos quedaron maravillados ante los colores tan bien conservados que utilizaban los antiguos pintores egipcios para decorar los sepulcros de los monarcas. Una maravilla de colores creados a partir de minerales sobrevivió a los siglos. Los romanos -esto también lo averiguaron los arqueólogos- conocían no menos de 30 000 matices encantadores, obtenidos con colorantes provenientes de minerales. Los pintores de la Edad Media, en particular los maestros italianos y holandeses, preparaban ellos mismos los colores de aceite que utilizaban para pintar sus famosos cuadros. Hasta ahora no se ha logrado imitar algunos de ellos.
Pero ahora dejemos caer el telón sobre el remoto pasado. Hablamos de él para demostrar con qué tenacidad el hombre trató de imitar el encanto de colores que exhibe la naturaleza. Sin embargo, a pesar de todos sus esfuerzos, hasta mediados del siglo pasado no se habían descubierto más de treinta colorantes naturales. Muchos de ellos no eran fijos; las telas teñidas con ellos palidecían pronto, aunque el proceso era complejo y lento. En el siglo pasado, fue como si le hubieran abierto las puertas de par en par a quienes trataban de descubrir nuevas fuentes para obtener más colorantes. Empieza la era de los colorantes artificiales o sintéticos. Ya no es del múrice, ni del añil, ni de las de más plantas tintóreas de donde el hombre saca los colorantes, sino de una materia maloliente desdeñada hasta hace poco: el alquitrán de hulla. Nosotros ya lo conocemos un poco: nos familiarizamos con él cuando hablamos de la producción de uno de los agentes para exterminar insectos nocivos, agente que tiene un nombre largo, difícil de recordar: diclorodifeniltriclorometilmetano o DDT.
7. Color en lugar de medicina
Abramos otro libro, esta vez de veras un libro de química, y veamos las fórmulas químicas de los colorantes sintéticos: una tras otra, y al lado de cada una está explicado cómo se puede preparar el colorante en el laboratorio. Hojeemos el libro, leamos qué producto químico debemos agregar a otro, y en qué forma, para conseguir colorantes amarillos, azules, verdes, rojos o negros. Casi al final del libro acaso caigan nuestros ojos sobre estas pocas palabras: "y finalmente, he aquí el histórico y famoso malva de Perkin, sin ninguna importancia práctica hoy". Como lápida sepulcral se verá al lado una fórmula química, con letras, hexágonos y líneas:

Figura 13.
Esto me recuerda la cara alargada y pecosa de un muchacho de dieciocho años, de pelo rojizo, que vi una vez en un viejo cuadro. Sus ojos impacientes y curiosos examinan un tubo al trasluz. El muchacho mira mucho tiempo, luego deja el tubo, se frota los ojos y con dedos inquietos toma una cápsula de porcelana con un líquido rojizo.
William Henry Perkin es ayudante del químico alemán Hofmann. El muchacho es inglés y lo que empezamos a contar pasa en Londres, donde los ingleses invitaron al doctor Hofmann para que los ayudara a establecer la primera escuela superior de química de las islas Británicas.
Perkin tenía 15 años cuando se matriculó con Hofmann. El químico alemán observó de pies a cabeza al muchacho esbelto:
-¿Y su papá le deja estudiar química? -preguntó.
-No quiere -fue la respuesta sorprendente.
-¿Y entonces qué piensa hacer? -sonrió el doctor Hofmann al muchacho pecoso.
-Alguien debe convencer a mi padre. Yo no quiero ser arquitecto de ningún modo, como lo desea él; quiero ser químico.
Así empezó uno de los más grandes químicos ingleses. Por fin, después de convencerse de que todas las bellezas que le contaba sobre la profesión de arquitecto no producían ningún efecto, el señor Perkin dio su consentimiento. Pero algunos días después volvió a disgustarse. William sacó trastos del desván y los llevó al patio, donde se instaló un laboratorio químico. No le bastaba mezclar, calentar, enfriar y por último tirar al vertedero toda suerte de sustancias químicas, en la Escuela Real de Química, de la mañana hasta las cuatro de la tarde: quería seguir trabajando en su casa.
-¡Maldita química! -repetía a menudo el señor Perkin, que no sabía de aquello. Más tarde a veces se acordaba de aquella imprecación, que ya no podía retirar.
Pero volvamos al joven Perkin. Hace ya tres años que es alumno de Hofmann, el profesor lo quiere, porque el muchacho es inteligente, listo y aplicado.
-Voy al campo por algún tiempo a descansar -dijo Hofmann un día a sus asistentes y a algunos de sus mejores alumnos, que mandó llamar-. No me gustaría que ustedes se quedaran aquí perdiendo el tiempo. En Asia la gente muere por miles de paludismo. Debemos esforzarnos ahora por producir quinina sintética, ya que la corteza de quina, de la cual, como saben, se saca el medicamento contra el paludismo, es muy insuficiente.
El profesor examinó algunas páginas que tenía en la mano; en ellas estaban descritos los experimentos que debían realizar sus alumnos durante se ausencia.
-Probar, probar y probar de nuevo, señores. Sólo es difícil lo que no nos atrevemos a hacer. Tal vez logrará alguno de ustedes, si no resolver completamente el problema de la quinina sintética, por lo menos dar un paso adelante hacia la solución. Les deseo mucha suerte.
-Quinina, quinina y sólo quinina, como si no existiera nada más en el mundo. ¡Y sacarla, para remate, de este maloliente alquitrán! -Uno de los alumnos de Hofmann expresó en voz alta lo que los demás sólo pensaban.
-Si él no lo puede hacer, ¿cómo lo podemos conseguir nosotros?
Esperó un momento para asegurarse de que el profesor estuviera ya bastante lejos, se puso el sombrero y salió a la calle inundada de sol. El joven Perkin no tardó en quedar solo en el laboratorio.
Entonces examinó la hoja que le había dado el profesor Hofmann.
Perkin leyó y releyó: "Nadie nos puede impedir. Pero sabía muy bien cuántos químicos mucho más viejos que él -pues tenia sólo 18 años- no habían podido resolver el problema, a primera vista tan sencillo: agregar a alguna materia cierto número de partículas de hidrógeno u oxígeno, o al contrario retirarla de dicha materia. Sabía también que muchos de ellos habían seguido el proceso que Hofmann había publicado ya y que estaba descrito en pocas palabras, con la letra diminuta y bonita del profesor alemán, en el papel que él tenía en la mano en aquel momento.
¿Y no podría utilizar otra cosa en lugar del naftaleno que me recomienda mi profesor y con el cual todavía nadie ha logrado nada? ¿Otra sustancia, de la familia del naftaleno, extraída también del alquitrán de la hulla?
Por suerte el joven Perkin tenía en aquel tiempo muy escasos conocimientos sobre la composición de los compuestos químicos y sobre las reglas fijas que rigen estas composiciones, además Hofmann se había equivocado en cuanto a la composición de la quinina.
Perkin se sentó en el viejo sillón que tanto gustaba a su profesor, se abismó en sus pensamientos y ni siquiera se dio cuenta que caía la noche.
-Ensayaré la toluidina -se dijo; se puso en pie, se desperezó, encendió la luz de gas y puso toluidina en el tubo. Le añadió unas gotas de agua -con lo cual quiso agregar a la toluidina 2 partes de hidrógeno- y empezó a calentar el tubo. En un momento le agregó un poco de dicromato de potasio, para introducir el oxígeno necesario.
-Ahora esto tiene que ser quinina -se dijo, cuando le pareció que el tubo se había calentado bastante tiempo en la llama.
Pero el joven quedó desilusionado. La quinina es blanca; en el tubo debieran aparecer cristales blancos, pero resultó un sedimento color pardo claro en el fondo, y además muy poco.
-Debo probar otra vez. En lugar de toluidina pondré esta vez anilina. De ésta sé más que de aquélla, pues nuestro Hofmann la descubrió. La extrajo también del alquitrán de hulla.
Perkin vertió anilina en el tubo y repitió el experimento: agregó agua, luego dicromato de potasio y calentó.
¿Qué pasaba? La mano del muchacho de dieciocho años, que sostenía el tubo, temblaba. En las paredes ya no había sedimento pardo rosado, sino un precipitado negro. Con cuidado, Perkin extrajo del tubo todo menos el precipitado. Lo vertió en una cápsula llena de agua caliente. No podía creer a sus ojos.

Figura 14. Malva: "Mauve" francese
El agua tomó un bello color purpúreo. William Henry Perkin, estudiante de dieciocho años, de quien su padre quería hacer un arquitecto, había descubierto por primera vez un colorante sintético. El muchacho reconoció fácilmente que aquello no era quinina sino un colorante: mojó unas hebras de seda blanca en la disolución púrpura, y se tiñeron en seguida de rojo. Y el color resistió toda una semana expuesta al Sol donde lo había dejado el joven químico. Ni siquiera el jabón lo pudo quitar. Perkin no perdió tiempo y en seguida mandó una muestra de su colorante a Escocia para que el tintorero Pullar, que se lo había pedido, lo probara allá. Todos los días salía al encuentro del cartero, todos los días le preguntaba lo mismo: -¿No tiene nada para mí? ¡De Escocia digo! Todos los días el cartero movía la cabeza. -Tal vez mañana, señor Perkin.
Después de una semana llegó una repuesta corta: "Acuso recibo de su envío. Su servidor, Pullar".
El muchacho estaba desilusionado, pero convencido de que el mundo entero recibiría su descubrimiento con los brazos abiertos, pese a aquellas pocas palabras lacónicas.
Pasaron tres semanas más. Un día desde lejos, el viejo cartero hizo un signo al muchacho: ¡carta de Escocia! Perkin rompió el sobre con impaciencia:
"Si su invención no eleva demasiado el precio de las telas teñidas, podría ser uno de los descubrimientos más interesantes de nuestra época", escribía el tintorero Pullar.
Aquel mismo día corrió William Henry Perkin, adolescente de dieciocho años, a la oficina de patentes, para hacer registrar su invento. El día 26 de agosto de 1856 fue concedida a Perkin la patente número 1984 por la fabricación del colorante malva, que recibió el nombre de las bellas flores color rojo violáceo. Y para mostrar al prudente tintorero escocés que la fabricación del producto en la fábrica no encarecía las telas teñidas, el muchacho construyó durante las vacaciones, con la ayuda de su hermano, un pequeño modelo de la máquina necesaria para la preparación de su colorante. Y cuando logró producir unos gramos de mauveína con el aparato, telegrafió al señor Pullar: "Esto vale la pena. Perkin".

Figura 15. Con su compuesto púrpura en el tubo donde había calentado anilina, agua y bicarbonato de potasio, Perkin, joven de 18 años, había obtenido el primer colorante sintético que llamó mauveína.
Con esto se termina (sólo para nosotros) el interesante episodio del descubridor del primer colorante sintético, William Henry Perkin, quien se dijera que dio la señal a los demás químicos, que empezaron a rivalizar en la producción cada vez más variada de colorantes sintéticos, derivados no sólo del alquitrán sino también de otros cuerpos como por ejemplo el azufre. Casi todos los años, alguno de ellos anunciaba que había inventado otro colorante sintético que remplazaba a algún colorante natural.

Figura 16. Este escudo perteneció a los antepasados de Federico Augusto Kekulé, uno de los grandes químicos del siglo pasado.
La granza tintórea, la púrpura de Tiro, el extracto de palo de campeche, árbol exótico que da un tinte violeta, la sangre de dragón, de los frutos de una palma llamada en latín Calamas draco , el carmín de la cochinilla y, en fin, el rey de los colorantes, el índigo o añil, extraído de las hojas de la planta del mismo nombre, fueron vencidos por una materia maloliente, el alquitrán de hulla. Hasta la fecha han salido de éste millares de clases de colorantes sintéticos. La producción de este cuerpo, que remplaza a los animales y las plantas, alcanza anualmente alrededor de 370 mil toneladas.
Encontramos en los anales los nombres de los descubridores de colorantes, que permitieron al pueblo vestirse también de púrpura: los nombres del francés Verguin, del ruso Butler, de los alemanes Graebe y Liebermann y de muchos otros químicos que fueron descorriendo el velo que ocultaba los secretos de la química de los colorantes.
8. Los ganchitos de plata en el escudo
Sería injusto no mencionar a otro químico que, en realidad, no inventó ningún colorante sintético, pero que ayudó mucho a que se descubrieran nuevas especies de éstos. Se llamaba Federico Augusto Kekulé, descendía de emigrados checos, nació en 1829, y, como a Perkin, se le destinaba al estudio de la arquitectura, pero más que los planes de sus padres, le atrajeron las fórmulas. Y así el joven se puso a estudiar química.
No hay que tomar demasiado en serio la e acentuada que aparece al final del apellido Kekulé: sin acento se trata simplemente de un nombre de hacendados checos de Stradonice, que lucían en su blasón tres ganchitos de plata que servían para sangrar a los caballos. Kekulé le puso un acento a la e cuando fue profesor de química en la ciudad belga de Gante, para que los varones de habla francesa no pronunciaran "Kekul" sino Kekulé. Kekulé se parecía más al nombre original del hacendado de Stradonice que el Kekul mutilado.
Trataremos de explicar muy simplemente la idea un poco complicada de Federico Augusto Kekulé, que permitió a los químicos definir de antemano en su mesa de trabajo, sin un solo tubo, sin mechero, sin vasitos llenos de reactivos, sólo con un lápiz en la mano, los procedimientos químicos por seguir.
Kekulé fue el primero que descubrió que cada átomo de carbono de cualquier compuesto orgánico es capaz -como si tuviera cuatro manos- de coger cuatro manos de otros elementos: el carbono es tetravalente.
Imaginemos la cosa en esta forma: un elemento monovalente, como por ejemplo el cloro en muchos casos, tiene una mano, y por eso cuando se combina con otro elemento monovalente, como por ejemplo el sodio, le da sólo esta mano y se produce un compuesto sencillo, el cloruro de sodio o sal común. El oxígeno ya es diferente, tiene siempre dos manos y cada una de ellas agarra firmemente una mano del hidrógeno monovalente: así un oxígeno agarra dos hidrógenos y el resultado es agua. Ahora imaginemos otra vez el carbono, que -en un sentido figurado, recuérdese- tiene en casi todos los casos cuatro manos y con cada una de ellas agarra la mano de otro elemento -y la coge firmemente. Decimos que el carbono es tetravalente: cada átomo de carbono agarra cuatro "manos" de otros átomos de carbono que se encuentran ligados unos a otros en numerosos compuestos químicos, como por ejemplo los derivados del alquitrán de hulla, forman hexágonos de este tipo:

Figura 17.
Kekulé llamó a esto núcleo bencénico. Y digámoslo más sencillamente todavía. Kekulé descubrió que rige en los compuestos de carbono una ley estricta en la combinación de los átomos de carbono consigo mismos y con otros elementos.

Figura 18. Federico Augusto Kekulé, descendiente de emigrados checos, contribuyó de una manera decisiva a la elucidación de la constitución de los compuestos orgánicos.
Naturalmente, esto fue un descubrimiento genial que permitió a los químicos calcular muchas veces de antemano lo que pasaría al hacer actuar un cuerpo sobre otro, sin necesidad de tomar en la mano un tubo con algún compuesto de carbono ni de hacer experimentos con él a la buena de Dios. La consecuencia práctica de eso fue que los químicos pudieron, con más éxito que nunca, preparar cada vez más colorantes sintéticos a partir del alquitrán de hulla. Por eso precisamente tuvo tanto mérito aquel descendiente de checos. Por eso pertenece también Federico Augusto Kekulé a la galería de los químicos famosos que ayudaron con la maravilla de los colorantes a enriquecer aún más la paleta, ya tan variada, de nuestro mundo.
EL CUERPO HUMANO, LABORATORIO QUÍMICO
Contenido
1. La noche oscura
2. Nansen, latas envenenadas y carne de foca
3. La tierra de la leche sin leche
4. ¿Qué son las vitaminas?
5. Medicina en lugar de colorantes
6. El muchacho de Lochfield, las truchas y el moho
7. Uno de los seiscientos mohos
8. Diez años de investigaciones
9. La muerte ayuda a la vida
10. Miles de unidades en un solo pinchazo
11. ¿Qué es la penicilina?
12. Milagro sin milagro
1. La noche oscura
Las ruedas de la carroza arrastrada por una cuadriga cansada tropezaban con las piedras, el cochero blasfemó, el látigo restalló, pero los caballos no hacían más que adelantar lentamente por el borde del camino. Caía la noche, la tempestad llegaba por el oeste y el señor que venía sentado en la carroza se asomaba sin cesar a la ventanilla y preguntaba con impaciencia por qué los caballos iban tan despacio, y cuantas veces se le contestaba que necesitaban descansar, refunfuñaba algo con enojo y otra vez se hundía en el rincón de la carroza.
Quería alejarse lo más posible de Bohemia. En Praga se había declarado la peste, se había extendido rápidamente y la gente se moría. No tenían ningún efecto los filtros preparados según los consejos de los más famosos alquimistas que vivían en la corte de Rodolfo II, emperador romano y rey de Bohemia. Ni siquiera el bálsamo mezclado con sangre de pato, al cual se agregaban en noches de Luna siete gotas de veneno de serpiente. Sin embargo, aquélla era una receta secreta que le había revelado al Emperador uno de sus más estimados alquimistas, el sabio Michael Sendivogius. Los enemigos del favorito del Emperador trataron en vano de difamarlo. Rodolfo II creía en su Sendivogius. Sólo cuando se enteró de que el alquimista había salido de Praga a toda prisa, por miedo a la peste, ordenó lleno de ira que despacharan a los jinetes más rápidos tras Sendivogius para traer al alquimista infiel.
Fue como si la tierra se lo hubiera tragado. Tal vez de veras sabía hacer brujerías este hombre vendido al diablo. Los jinetes regresaron sin el alquimista. Había evitado los caminos imperiales y obligado al cochero a ir por senderos que a los cocheros no les gustaba seguir, y sólo cuando estuvo seguro de que ya había pasado la frontera morava le dio al cochero la orden de regresar a la carretera que lleva a Silesia.
El fiel sirviente del famoso alquimista, Bodowski, iba sentado en el pescante de la carroza, al lado del cochero; le decía a éste que fuera más de prisa, que la región estaba despoblada, los tiempos eran inseguros, la gente mala.

Figura 1.
La carroza saltaba de nuevo, en los ejes se oían chasquidos; el cochero tiró violentamente de las riendas. Atravesado en el camino había un tronco enorme. Los caballos se detuvieron y en aquel momento aparecieron algunas siluetas tenebrosas al borde del camino. Rodearon la carroza; una de ellas montada a caballo miró adentro.
- Tendrá que bajar su señoría - dijo el jinete.
Pero el hombre de la carroza no se movió.
- ¿No oyó? ¡Bájese! - ordenó el jinete.
- ¿Quién es usted? ¿Y con qué derecho detiene a un consejero de la corte de Su Majestad el Emperador? - preguntó el hombre de la carroza.
- Lo esperaba, señor Sendivogius - replicó el hombre del caballo- . Soy Jost, caballero de Haugvic. Sabía que venía usted por aquí. Detuvimos al mensajero que debía entregar su carta al Elector de Sajonia. El hombre, más calmado, sacó la carta, con el sello roto.
- ¿Quiere regresar a Praga con mis guardias o hacerme un pequeño favor por el cual le estaré agradecido toda la vida?
Sendivogius miró al jinete con curiosidad; su cara le parecía conocida.
- ¿Qué quiere de mí?
- La piedra filosofar - dijo Haugvic brevemente.

Figura 2. Michael Sedziwój (1556-1636), alquimista polaco
Michael Sedziwój de Cracovia, llamado Sendivogius, consejero de la corte del emperador Rodolfo, alquimista afamado, sonrió.
- Ese secreto no lo he revelado ni siquiera a Su Majestad el Emperador - su voz era firme y llena de desprecio contenido.
El caballero de Haugvic, señor del castillo de Bouzov, abrió la portezuela de la carroza, ordenó que apartaran el árbol colocado en el camino y que bajaran al que iba en el pescante junto al cochero.
Así se encontró el alquimista Michael Sendivogius en Bouzov. El señor del castillo esperó tres días que le dijera el gran secreto. El cuarto día acudió solo a ver al alquimista.
- ¿No revela su secreto? - preguntó.
Sendivogius movió la cabeza.
- Entonces ¿quiere por lo menos curar a mi señora Salomena?
Ya no era el hombre severo que cuatro días antes había detenido la carroza del famoso alquimista.
- ¿Qué le pasa a la señora Salomena? - preguntó Sendivogius.
- Tiene un gran dolor en el pecho - contestó Haugvic.
Sendivogius reflexionó un momento.
- Llévenme junto a ella; que dispongan doce huevos, una lengua de ciervo, sesenta caracoles, una libra de azúcar, trece cucharadas de vino, y mi fámulo que venía en el pescante escogerá en mi saco las hierbas que le ordenaré.

Figura 3. En 1766 apareció en Nurenberg el libro de Sedziwój, titulado "Novum lumen chemicum" (traducido libremente del latín: "Nueva ojeada sobre la química").
Al día siguiente, después de pulverizar los huevos y los caracoles y agregarles la lengua de ciervo, las trece cucharadas de vino bien llenas, la libra de azúcar rosada, hepáticas y berros, el alquimista del Emperador especificó qué dosis debía tomar cada día la señora Salomena. Luego se despidió y siguió su viaje a Silesia con su fiel fámulo.
Dos semanas después, el caballero de Haugvic, señor de Bouzov, comunicó al emperador Rodolfo II por carta que por allí había pasado el embustero más asqueroso del mundo, Michael Sendivogius, y que por poco le arrebató la vida a la noble señora Salomena con su filtro infernal.
No seamos injustos con los alquimistas, ni siquiera con Michael Sedziwój, charlatán en cuanto a curaciones. Si consideramos la época en la cual vivió, no era mal químico.
Olvidémonos ahora de los boticarios y médicos que recomendaban "utilizar ajo asado si duele una muela", o que afirmaban que se puede curar la tuberculosis si el enfermo se aplica en el pecho hiel de oso mezclada con miel, y que la mordedura de un perro rabioso no hace daño a quien traga un pelo de la cola del perro. Es cierto que las lenguas de rana, los ojos de lagarto o los dientes de dragón que recetaban los charlatanes de la Edad Media no eran más que obras de su imaginación, exactamente como la receta que dio el alquimista del Emperador a la señora Salomena.
Pero el hombre - tal vez desde el principio de su existencia en este planeta- observó los procesos complejos de su cuerpo y trató de encontrar una explicación. Quiso saber qué remedio puede devolver al estado normal una fábrica química tan extraordinaria como el cuerpo humano, si algo se descompone en ella.
Hoy sabemos que se realizan en el cuerpo humano procesos químicos como en una verdadera fábrica: la trituración de la materia prima sería la masticación de los alimentos en la boca; vienen luego la fermentación - que también empieza en la boca y sigue en el aparato digestivo- , la producción de anhídrido carbónico, de materias orgánicas e inorgánicas, la transformación de la energía, la filtración en los riñones, etc. El hombre ha aprendido que tiene en su cuerpo potasio necesario para conservar el agua en las células y para el trabajo del músculo cardiaco. Sabe que sin calcio - tenemos kilo y medio en el cuerpo- es inconcebible que se formen huesos, que en los músculos, en los glóbulos rojos, en el hígado y en los nervios hay 20 gramos de magnesio, sin el cual no tendríamos ni dientes, ni huesos, ni cartílagos.

Figura 4. Vitamina C. Microfotografía de los
Un adulto necesita cada día 12 miligramos de hierro, sin los cuales se presenta la anemia. El cuerpo humano, este maravilloso laboratorio químico, contiene 150 miligramos de cobre, que ayudan a su funcionamiento. En el pelo y en los huesos se encuentran 2 gramos de zinc. No debe bajar de 80 g el cloro que está en la sangre, los riñones, la piel y el líquido cefalorraquídeo, ni de 120 g el azufre que tenemos en todo el cuerpo. Contenemos otros muchos elementos químicos, ácidos y bases, que hacen funcionar esta fábrica humana tan compleja.
Fíjense en que la mayoría de los elementos químicos están presentes en cantidades ínfimas en el cuerpo: miligramos o gramos. Y estas pequeñas cantidades están asociadas a una enorme cantidad de agua. No menos de 66% del peso del cuerpo de un adulto es agua. En un cuerpo humano de 80 kg hay 50 kg de agua.
Todo esto lo referimos sólo para disculpar un poco a los médicos de antiguos tiempos que no sabían mucho de la complejidad del cuerpo humano. Pero la gente del pueblo contestaba a la ciencia de la época con proverbios como éste: "Si quieres vivir mucho tiempo, apártate de tres cosas: médicos, boticarios y pepinos".
Los pepinos entraron tal vez injustamente en el proverbio. Hoy sabemos que contienen vitaminas que desempeñan un papel muy importante en nuestro cuerpo. La falta de vitaminas produce en la extraordinaria fábrica humana trastornos que pueden hasta interrumpir su funcionamiento.
Ahora veamos qué son las vitaminas, dónde las encontramos y de qué son capaces.
2. Nansen, latas envenenadas y carne de foca
El explorador polar Fridtjof Nansen estaba aterrado. Este noruego taciturno y atrevido trataba de llegar al Polo Norte en su barco llamado "Fram", en los años 1893-1896. Ya tenía bastantes problemas, y ahora además aquello: alguien había envenenado las conservas que representaban la única comida de toda la tripulación. Después de comer la carne en conserva, los marineros empezaban a tener fiebre, el cansancio se apoderaba de ellos, les salían úlceras en el cuerpo y se les caían los dientes.

Figura 5. El barco "Fram" en el cual el explorador polar noruego Fridtjof Nansen partió hacia el Polo Norte a fines del siglo pasado.
- Pero ¿quién podría tener interés en que no llegáramos al Polo? - Nansen pensaba en todos los que no deseaban su expedición- . ¿O acaso se habrá formado algún veneno en los víveres en conserva? Pero ¿cómo, si hace ya mucho tiempo que estamos viajando? - Nansen estaba de veras muy preocupado por aquella dificultad imprevista. Ordenó que se lavara bien la comida con agua de mar y que se cociera más tiempo que de costumbre. A lo mejor se evaporaba el veneno al hervir. Sin embargo, el estado de salud de los marineros no mejoraba. Había cada vez más enfermos, algunos no querían ni siquiera tocar los comestibles en conserva. No quedaba más que tratar de cazar, en la superficie del mar eternamente helado, alguna foca o algún oso. A decir verdad, la carne y la grasa de estos animales no les gustaban mucho, pero vieron con asombro que las úlceras empezaban a desaparecer de los cuerpos de los marineros, que las fiebres descendían y que los marineros sanaban.
La misma enfermedad que se abatió sobre los marineros de Nansen había afectado también a toda la tripulación del navegante portugués Vasco de Gama, quien por primera vez en la historia de la humanidad llegó a la India dando la vuelta al África. Sin embargo, en 1497, cuando el navegante portugués emprendió su largo viaje, no tenía la menor idea de lo que eran víveres en conserva. ¿Quién había envenenado la comida de los ciento sesenta tripulantes de las tres carabelas de Vasco de Gama, de los cuales acabaron por morir más de cien?
Nadie. De la misma manera que nadie había envenenado tampoco la comida del "Fram" de Nansen. Todos padecieron la misma enfermedad: escorbuto. Enfermaron porque les hacía falta vitamina C en la comida. Naturalmente, cuando el navegante portugués partió hacia el oriente y Nansen, 300 años más tarde, hacia el norte, nadie sabía nada de la vitamina C. Se conocía la enfermedad, pero no su causa. Todavía en el siglo pasado, los médicos afirmaban que para disfrutar de buena salud el hombre debía ingerir proteínas - que ayudan a la constitución del cuerpo- , grasas e hidratos de carbono - que proporcionan al cuerpo la energía necesaria- , sales minerales y agua - que modifican los alimentos químicamente para que desempeñen su papel constructor y proporcionen infaliblemente la energía necesaria. El médico ruso I. N. Lunín fue uno de los primeros que se dieron cuenta de que esto no bastaba. En 1881 escogió algunos ratones experimentales y los alimentó con una mezcla de grasa, azúcar de caña y caseína, que es la proteína contenida en la leche. Después de 21 días no quedaba ni un solo ratón vivo, a pesar de que consumían mucho alimento del que acabamos de mencionar.
Lunín comprendió que los alimentos del hombre y de los animales deben contener algo más que proteínas, hidratos de carbono y grasas. Pero ese algo quedó mucho tiempo envuelto en el misterio.
Los capitanes de barco experimentados, desde hace más de cien años ordenaban que se diera a la tripulación, después de cierto tiempo de navegación, por lo menos una naranja o un limón por cabeza cada día. Tampoco sabían nada de la vitamina C, pero la experiencia les había enseñado que así los marineros no padecían escorbuto, aunque sólo comieran carne salada durante mucho tiempo: la única condición era que comieran todos los días por lo menos una naranja o que tomaran jugo de limón.
3. La tierra de la leche sin leche
Hacia el fin de la primera guerra mundial, en 1917, los médicos daneses advirtieron que aumentaba el número de niños cuyas córneas primero se endurecían, luego empezaban a desecarse, y al final se cubrían de úlceras y se ablandaban. Los niños se quedaban ciegos. La situación era terrible en uno de los hospitales de Copenhague. Los niños afectados por aquella enfermedad eran más numerosos que en los demás hospitales y su estado de salud empeoraba cada día. Los médicos preguntaron a la enfermera principal si tenían apetito los niños.
- Sí - contestó la enfermera- , hasta dos platos de sopa se comen algunos.
- ¿Y les gusta la leche? - preguntó uno de los médicos.
- Hay escasez de leche, por eso no se la damos aquí - contestó la enfermera.
El médico se dio cuenta de que los niños que tomaban leche, así fuera de vez en cuando, estaban mucho mejor que los que tomaban nada más sopa. Pero no sabía aún que la causa de la enfermedad que endurecía la córnea era la carencia de vitamina A, que proporciona precisamente la leche. Con estos ejemplos demostramos que la fábrica química que es el cuerpo humano necesita algo más que proteínas, hidratos de carbono, grasas, sales minerales y agua. Necesita vitaminas.
4. ¿Qué son las vitaminas?
Son sustancias que se encuentran en los organismos de plantas y animales y que son capaces - bastan pequeñas cantidades- de intervenir en los procesos químicos que se realizan en el cuerpo. Son muchas y las designamos con las letras mayúsculas del alfabeto: A, B, C, D, etc. Fue el médico polaco Kazimierz Funk quien les puso el nombre, en 1910. Se compone de dos partes: vita en latín quiere decir vida; lo de "amina" es porque pensaba que todas las sustancias del grupo incluían en sus moléculas el grupo llamado "amino", cuya fórmula química es -NH 2 . En esto último se equivocó Funk. Hoy sabemos que las vitaminas tienen muy diversas estructuras químicas. Por ejemplo la vitamina A, cuya insuficiencia en los alimentos hace que el hombre vea muy mal con poca luz, es un derivado del caroteno, colorante anaranjado. ¿No les sugiere nada el nombre? Tal vez: es el colorante de la zanahoria. La vitamina A proviene de la zanahoria. La vitamina C que les hacía falta a los marineros del navegante portugués Vasco de Gama y del famoso Nansen, es ácido ascórbico que, como ya dijimos, se encuentra en las naranjas, los limones y otras frutas. La vitamina D, cuya carencia trae como consecuencia en los niños el raquitismo - enfermedad que se manifiesta por cráneo anguloso y desproporcionado, dientes con mal esmalte, caja torácica aplastada y columna vertebral desviada- , se encuentra sobre todo en las grasas de peces de mar. No todas las vitaminas tienen el mismo aspecto. Algunas son cristalitos incoloros que se disuelven fácilmente en el agua, por ejemplo la vitamina B 1 . Otras veces son solubles en aceites pero insolubles en agua, como por ejemplo la vitamina A, de color amarillo claro.
Como ya dijimos, las vitaminas son numerosas. La vitamina B, cura una enfermedad que se llama beriberi. El individuo afectado por esta enfermedad anda como borracho, por tener el sistema nervioso alterado. Esta terrible enfermedad invadió los países asiáticos, cuando los indígenas empezaron a comer arroz ya no entero, sino descascarillado: precisamente las cascarillas contienen vitamina B 1 . La vitamina P, que consolida las paredes de los vasos sanguíneos y protege de las hemorragias - junto con la vitamina K- se encuentra también en los limones. La descubrió un laureado con el Premio Nóbel, el húngaro Szent-György, que extrajo 15 miligramos de esta vitamina de 70 kg de cáscaras de limón.
Se averiguó que las vitaminas están muy repartidas en la naturaleza: en las plantas y en el cuerpo de los animales. Los químicos trataron de aislar las vitaminas, o sea obtenerlas puras. El primero que lo logró fue Kazimierz Funk, a quien mencionamos ya por haber puesto nombre a las vitaminas. Fue el primero que, en el año 1912, extrajo de la levadura la vitamina B 1 , que faltaba en los alimentos de los pueblos asiáticos que consumían arroz descascarillado. Más tarde otros químicos encontraron la manera de extraer otras vitaminas. Hoy ya no encontramos sólo denominaciones simples como C, E, P, etc., sino también cosas como B 1 y B 2 , D 2 , K 2 , y hasta B 12 , etc. Esto quiere decir que se trata de vitaminas que en realidad pertenecen al mismo grupo, pero que tienen composiciones químicas distintas.
Los químicos lograron incluso preparar sintéticamente las vitaminas que encontramos en la naturaleza. Descubrieron también sustancias químicas que estrictamente hablando, no son vitaminas, pero que se transforman en éstas en el cuerpo. Son las provitaminas, de las que el mejor ejemplo es el caroteno, ya mencionado, que se encuentra en la zanahoria.
Composición aproximada del cuerpo humano
| Peso total Agua Residuo seco Azúcares Grasas Proteínas Sales | 2.1 kg 0.8 kg 0.01 kg 0.35 kg 0.34 kg 0.1 kg | 41 kg 29 kg 0.4 kg 12.6 kg 13 kg 3 kg |
El cuerpo humano contiene muy diversas materias inorgánicas. Un hombre que pesa 70 kg contiene:
más o menos 250 g de potasio
más o menos 1-1.5 kg de calcio
más o menos 1.5-3.5 mg de magnesio
más o menos 4200 mg de hierro
más o menos 100 mg de cobre
más o menos 2 g de zinc
más o menos 80 g de cloro
más o menos 7 g de flúor
más o menos 30 mg de yodo
casi 700 g de fósforo
más o menos 120 g de azufre
y otras muchas materias


Figuras 6 y 7.
Las fuentes más ricas de vitamina C son el pimiento, los espárragos, los jugos de limón y naranja, la fresa, la grosella negra. Hay 6 g de ácido ascórbico - o sea vitamina C- en 12 litros de jugo de limón. El adulto necesita cada día sólo 500 mg de vitamina C, es decir, la duodácirna parte de aquella cantidad. Naturalmente, esto no quiere decir que debamos tomar a diario medio litro de jugo de limón.

Figura 8
La vitamina C se encuentra también en otros alimentos, como vemos en las tablas. Al cocerlas se destruyen las vitaminas. Cuando se cuecen las papas sin mondar se destruye más o menos 10% de la vitamina C; cuando las cocemos peladas se destruye hasta el 25%. También la leche cocida mucho tiempo pierde vitamina C. Las frutas cocidas o asadas pierden completamente la vitamina C. Por eso es mejor comer las frutas y verduras crudas.
Terminaremos este relato de investigaciones subrayando una vez más que el químico moderno puede preparar en su laboratorio las sustancias que llamamos vitaminas, tan bien como la naturaleza.
Pero no basta que el hombre facilite el proceso químico de su organismo mediante las sustancias que acabamos de mencionar. La humanidad se debe proteger también de eternos enemigos microscópicos, cuando se acumulan demasiados en el mecanismo de la fábrica humana. En el capítulo siguiente veremos qué armas sabe fabricar el químico en el laboratorio contra esos huéspedes importunos del cuerpo humano.
5. Medicina en lugar de colorantes
Ya hacía días que el doctor Gerhard Domagk, de la ciudad de Elberfeld, estaba atareado poniendo inyecciones a ratoncitos blancos. En centenares de aquellos animales investigaba los efectos de una sustancia de la que hasta entonces no se sabía mucho.

Figura 9
En 1908, un estudiante de la Escuela Superior Técnica de Viena, Paul Gelmo, descubrió una nueva sustancia, trabajando en su tesis para obtener el título de ingeniero químico. Le tuvo que dar un nombre extraordinariamente largo: para-amino-bencen-sulfonamida. Su fórmula química era C 6 H 8 O 2 N 2 S.
Si nuestros conocimientos químicos fueran un poco más hondos, nos daríamos cuenta de que este polvo blanco es un derivado de la anilina - la cual, como se recordará, fue extraída por Hofmann del desagradable y maloliente alquitrán de hulla- y de que este nuevo producto pudiera servir para obtener colorantes sintéticos. Después de que el joven Perkin descubrió la mauveína, muchos químicos se pusieron a buscar más colorantes cuyo progenitor último es la hulla. En todo el mundo se buscaban nuevos colorantes sintéticos. El resultado fue que se descubrieron centenares de ellos. Por eso el descubrimiento de Paul Gelmo apenas era digno de atención, por deberse a un estudiante. Los investigadores de las grandes fábricas, que husmeaban en las bibliotecas, en los artículos o en las listas de patentes, en busca de nuevos descubrimientos, no se fijaron en él.
- Más colorantes sintéticos, ¿y qué? Ya hay tantos, que hasta los estudiantes saben fabricarlos.
Hacían un gesto con la mano y volvían a poner la revista, donde Gelmo había descrito cuidadosamente las propiedades de su sustancia, en el estante de donde la acababan de sacar.
Pasaron muchos años - ya estamos en 1932- y nadie se ocupó en serio del descubrimiento del estudiante de Viena. Hasta que en el mes de mayo subió un hombrecillo a la tribuna, en un congreso de médicos en Dusseldorf. Había mucho ruido en la sala, los médicos conversaban y nadie hacía caso del hombre que levantaba las manos para pedir silencio.
- Señores, les pido por favor su atención. Tal vez les interesará - era el doctor Foerster, que miraba en forma suplicante al público. Acabaron por callar todos.
- He logrado curar a un niño que padecía envenenamiento de la sangre causado por estafilococos. Utilicé sulfonamida.
En la sala reinó un silencio de muerte y el doctor Foerster contó con voz tranquila cómo había utilizado la sustancia, descubierta 24 años antes por el estudiante austriaco, la para-amino-bencen-sulfonamida, o sulfonamida, para que fuera más corto.
- No es un colorante; es una medicina que destruye los estafilococos e impide así la formación de pus - concluyó el doctor Foerster.

Figura 10. Estos enemigos del hombre, invisibles a la vista (estreptococos, estafilococos, neumococos y meningococos), fueron invencibles, hasta que se descubrió contra ellosun arma tan eficiente como la sulfonamida.
Durante un momento, cuando acabó de hablar, duró el silencio. Luego se oyó un aplauso de cortesía y más tarde muchos de los médicos movían la cabeza con desconfianza. - ¿Y este Foerster se atrevió a ensayar la sustancia directamente en un ser humano vivo? Pues ni siquiera mencionó haberla ensayado primero en animales.
En la penúltima fila estaba sentado el doctor Gerhard Domagk. Tomó algunas notas y cuando regresó a su casa en Elberfeld se encerró en su laboratorio e inició un gran experimento, durante el cual lo encontramos al principio de este capítulo. Domagk era minucioso. Decidió inyectar a cada ratoncito una dosis de estreptococos suficiente para matar no sólo a un ratón sino a un gato. Esperó con impaciencia para ver cuántos de los mil ratoncitos infectados en esta forma morirían. Pero no murió ninguno. Sobrevivieron a infecciones mortíferas. El médico concienzudo y minucioso no se contentó con aquello. Decidió hacer el mismo experimento usando conejos. Igual resultado: no murió ni un conejo, a pesar de recibir dosis mortales de bacilos. ¿Por qué no le pasó nada a ninguno de los animales? Porque poco tiempo después de inyectarles las dosis mortales de estreptococos a los ratoncitos y a los conejos, les inyectó también sulfonamida.
El profesor de Elberfeld llamó a sus asistentes.
- No podemos conformarnos ni siquiera con esto. Antes de experimentar la sulfonamida en seres humanos será necesario ver cómo actúa sobre otros microbios, como neumococos, gonococos, meningococos.
Adviértase que los nombres de todas las bacterias mencionadas por el doctor Domagk terminan en "coco": es que todos pertenecen al mismo grupo de microorganismos muy sencillos, que hasta entonces resistían con obstinación a todos los medicamentos conocidos y sin cesar sembraban enfermedades por el mundo: los estreptococos y los estafilococos causan la producción de pus; los neumococos, pulmonía; los meningococos, inflamación de las membranas cerebrales o meninges.
El doctor Gerhard Domagk repartió el trabajo entre sus asistentes. Todos se fueron al laboratorio y el profesor regresó tarde a su casa aquella noche. Allí le esperaba una sorpresa desagradable. Su hijita se había pinchado el dedo con una aguja; la herida empezó a supurar y tuvieron que llevar a la niña al hospital, con envenenamiento de la sangre o septicemia. Domagk estaba convencido de haber llevado él a su casa, en el pelo o en la ropa, algunos de aquellos microbios homicidas, y de ser, por lo tanto, causante de la enfermedad de la niña.
Los médicos del hospital intentaron todo lo que era posible; al final apareció el cirujano, porque era necesario amputar el dedo. Era la única manera de salvar a la niña. ¿Era ésa la opinión de todos? De todos menos uno, el padre de la niña, Gerhard Domagk.
- Antes de permitir que le amputen el dedo a la niña, intentaré esto todavía - dijo. Los demás se encogieron de hombros.
El doctor Domagk puso a su hija la misma inyección que había aplicado a mil ratones blancos y a muchos conejos: la sulfonamida. La niña salió del hospital unos días después. La sulfonamida, que los asistentes del profesor tenían que ensayar todavía a fondo en animales, mostró su eficacia en el organismo humano en estas circunstancias dramáticas.
Hoy se fabrican 2 000 medicinas que contienen sustancias sintéticas de este grupo, cuyo primer representante fue descubierto por el estudiante vienés Paul Gelmo.
La noticia del nuevo remedio "milagroso" se divulgó pronto por todo el mundo. Al principio creyeron los médicos que aquel compuesto podía destruir todas las bacterias nocivas en el cuerpo humano. Creyeron que se había realizado el sueño de aquel cazador de microbios, el doctor Ehrlich, un poco chiflado pero tan genial, que se enviaba recados él mismo para no olvidarse de ir a la peluquería "No olvides ir a la peluquería a las tres de la tarde", que presentía con toda su sensibilidad científica que la química ocultaba, en algún misterioso rincón de su imperio secreto, la sustancia que podría destruir los más grandes enemigos del organismo humano, que son invisibles.
Sin embargo, este remedio milagroso no era la sulfonamida. Pronto se apreció que esta medicina sólo ayudaba al cuerpo a defenderse en su lucha contra las bacterias, en el sentido de que entorpecía su desarrollo, pero sin matarlos directamente. Y además se diría que la sulfonamida tenía miedo al pus, pues fácilmente resultaba ineficaz en la lucha contra una colonia de estreptococos bien establecida. Y así el hombre tuvo que inclinarse de nuevo sobre el microscopio, poner en la llama abrasadora del mechero de Bunsen tubos con toda suerte de materias químicas y buscar pacientemente la respuesta a esta pregunta: ¿Existe un remedio que pueda exterminar todos los enemigos minúsculos del organismo humano? Y en sus búsquedas de este remedio el hombre tropezó con un moho digno de no poco interés, del que hablaremos en seguida.
6. El muchacho de Lochfield, las truchas y el moho
Un día de septiembre el doctor Alexander Fleming, médico escocés, regresaba a Londres. Había pasado dos días maravillosos en su casa de campo. Había tenido suerte y pescado más truchas que nunca antes, en el torrente que desembocaba al lado del molino, junto a su jardín. No hay nada más maravilloso que cebar cuidadosamente el anzuelo con la mosca, lanzar el sedal, ver cómo se pone tirante y entonces tirar bruscamente.
El doctor Fleming quiso saber exactamente cuántas truchas eran. Pero no las pudo contar. Nunca había tenido tanta suerte, ni siquiera en su Lochfield natal, en Escocia. El médico de cuarenta y ocho años se acordó de la casa solitaria, en el monte pelado, expuesto al viento; de cómo se levantaba temprano, cuando era muchacho, bajaba la colina empinada corriendo hacia el torrente y no soltaba la caña hasta que pescaba una trucha de la corriente. Luego subía con ella por el camino pedregoso hasta la casa y, jadeando, le pedía a su madre que se la preparara para el desayuno:
- Pronto, por favor, que si no llego tarde a la escuela.

Figura 11. El microscopio electrónico ligero BS 242, de fabricación checoslovaca. El haz de electrones va del cátodo negativo al ánodo positivo. El sistema óptico del microscopio consta de una serie de bobinas, por las que pasa el haz electrónico. El objeto que se va a observar se pone en el camino de los electrones. Por las bobinas pasa corriente continua, que genera un campo magnético, el cual actúa sobre los electrones lo mismo las lentes sobre los rayos de luz en el microscopio óptico. El haz de electrones cae sobre una pantalla de sustancia fluorescente, que emite la luz al ser golpeada por los electrones. En dicha pantalla se observan entonces los objetos, ampliados.
La escuela estaba lejos, todos los días por el mismo camino se apresuraba el chico escocés con su cartapacio a la espalda; seis kilómetros de ida, seis de vuelta.
No era fácil la vida en casa de los Fleming, cinco hijos y tres hijas compartían el cariño, pero también los modestos ingresos, del pobre agricultor escocés. Así que el señor Fleming aceptó con gusto cuando uno de sus hijos mayores le propuso llevarse a Londres a Alexander, de trece años. Allá seguiría yendo a la escuela dos o tres años y luego se le buscaría un trabajo.
El hermano cumplió su promesa: el muchachito de Lochfield, al que le gustaba pescar, fue recadero en una compañía marítima. Le pusieron un uniforme azul oscuro con botones dorados y brillantes, y en la cabeza una gorra negra. Y Alexander Fleming, como conviene a un empleado de la "City" de Londres, iba al banco llevando su cartera cerrada con dos vueltas de llave, con los cheques de sus patronos o cartas para sus numerosísimos clientes. Cuatro años llevó el uniforme con botones de oro falso. Durante todo este tiempo fue ahorrando algún dinero, y cuando su hermano prometió ayudarlo otra vez, quien mientras tanto había terminado sus estudios de medicina, Alexander tomó la decisión de ser médico también. Tenía entonces 20 años.
Ahora el doctor Fleming no recordó cómo había terminado sus estudios ni cómo se había hecho bacteriólogo en uno de los hospitales de Londres. Pasaba al lado del lago de Hyde Park, vio a los niños que echaban barquitos a la superficie tranquila. Dentro de un momento llegaría a un gran edificio sombrío, sobre cuya puerta se leía, escrito con letras doradas un poco ennegrecidas: St. Mary's Hospital.

Figura 12. Sir Alexander Fleming, descubridor de la penicilina.
Entró en el laboratorio, saludó a uno de sus compañeros de trabajo, el doctor Todd, que ni siquiera levantó la cabeza del microscopio, y quiso empezar a contar en seguida qué suerte tan asombrosa había tenido el día anterior. Pero al hombre inclinado sobre el microscopio le interesaban más los microbios que las truchas. Entonces el doctor Fleming calló y se sentó ante su mesa de trabajo, llena de tubos, frascos, vasos de precipitados, en medio de los cuales se encontraba el microscopio.
El viernes, antes de salir de Londres, había decidido cultivar las bacterias que causan la supuración que se llaman estafilococos. No era nada difícil. Tomó un pedacito de músculo cardiaco - este tejido debía servir de medio de cultivo- y puso allí las bacterias para que se reprodujeran. Siguiendo el camino del gran científico francés Pasteur, los médicos de entonces buscaban bacterias que destruyesen otras bacterias según la ley eterna de la naturaleza. Y Fleming quería ver qué bacterias destruían los estafilococos.
Empezó a examinar las cápsulas donde debían haberse formado más estafilococos, entre el sábado y el domingo.
- Parece que no resultó nada - se dijo, y ya iba a limpiar las cápsulas. Pero algo se le ocurrió. Se detuvo y volvió a examinar una cápsula. Había en ella un círculo inusitado, verdoso, del tamaño de una monedita.
- ¿Qué será esto? Tal vez algún moho.
Lo raro era que no había ninguna bacteria en el medio de cultivo. El doctor Fleming pensó que alguna otra especie de bacterias había destruido los estafilococos. No sería nada extraordinario: en el aire hay un número incalculable de bacterias.
Pero ¿qué era aquello? En la segunda cápsula había una mancha de moho más pequeña que en la primera, pero aquí había más bacterias que en el otro caso.
Donde estaba el moho no había bacterias, pero pululaban en la porción del tejido cardiaco que el moho no alcanzaba.

Figura 13. Penicillium aumentado unas 500 veces.
En este momento, el doctor Fleming se planteó una cuestión que, bien contestada, tendría un significado decisivo para la ciencia médica: el medio de cultivo donde se debían reproducir las bacterias ¿es igual en toda la superficie de la cápsula? No. El moho se encuentra en medio del trozo de músculo cardiaco nada más, pero no en los bordes. Las bacterias viven sólo donde no hay moho. Las bacterias están muertas donde se encuentra el moho.
El doctor Fleming se volvió hacia su compañero de trabajo: - Mire esto, por favor - y le mostró la cápsula de los estafilococos aniquilados- . ¿No le parece interesante?
Todd se inclinó sobre el microscopio. - Interesante - dijo con cortesía y regresó a su trabajo.
Ninguno de los médicos presintió en aquel momento que lo que acababa de llamarle la atención al doctor Fleming sería considerado uno de los descubrimientos más importantes de la medicina moderna - el descubrimiento de la penicilina, de los antibióticos.
7. Uno de los seiscientos mohos
Fleming separó con cuidado el moho del medio de cultivo y lo puso en otro medio: agar-agar sin bacterias, en un tubo. El moho se desarrolló algún tiempo; entonces lo puso, con su medio de cultivo, en una cápsula y esperó.
Figura 14. Cápsulas con agar-agar en las cuales Fleming cultivó el moho "Penicillium". Nótese qué pronto crece el moho. En el primer vaso el moho tiene cinco días, en el segundo tiene siete días y en el tercero diez días.
Cuatro días pasaron antes de que el moho estuviese en condiciones de recibir, con ayuda de un hilo de platino, varias especies de bacterias que causan enfermedades, entre ellas nuestro conocido el estafilococo, que causa la supuración de las heridas, el microbio de la difteria y el de la tifoidea. Fleming puso una muestra del moho en otro tubo y se lo mandó a un especialista de los que se llaman micólogos ( mykos significa hongo en griego, y el moho es un hongo unicelular), para que le indicara con exactitud de qué especie de moho se trataba. Se puso a esperar entonces, ya con más calma, para ver si se repetiría lo que había observado el lunes pasado; es decir, quería ver si el moho destruiría algunas de las bacterias puestas en el medio de cultivo. Pero el resultado superó toda previsión. El moho destruyó todas las bacterias, incluso la de la tifoidea.
Al día siguiente el doctor Fleming recibió del micólogo la noticia de que el moho que le había mandado se llamaba en latín Penicillium rubrum . Sólo después se supo que el especialista se había equivocado y que Fleming, quien no era especialista en mohos, tenía razón cuando insistía en que con toda seguridad se trataba de otro moho. Hoy sabemos que era el moho que se llama Penicillium notatum .
El error no tuvo ninguna influencia sobre los experimentos de Fleming. Es que Fleming tomaba el moho que necesitaba para todas sus investigaciones del medio de cultivo en el cual había aparecido el moho por primera vez. Después los químicos y médicos hicieron sus experimentos con mohos que les mandaba el doctor Fleming. Lo cómico es que quince días después de haber cometido el error, el micólogo le mandó al doctor Fleming una carta para disculparse.
Hay que darse cuenta de que se conocen 600 especies de mohos. Sólo dos de ellas tienen la gran facultad de producir la sustancia que destruye las bacterias que Fleming encontró muertas en su cápsula. Y precisamente una de estas especies de mohos penetró accidentalmente en el medio de cultivo aquel feliz día en que Fleming pescó tantas truchas cerca del molino. Precisamente esta milagrosa especie entre las seiscientas otras.
Pero, desgraciadamente, termina aquí la historia del doctor Fleming. El bacteriólogo de Londres trató de poner a prueba su descubrimiento en ratoncitos y conejos, pero sin éxito. Los animales experimentales, infectados con estafilococos, estreptococos o bacilos de la difteria, y que recibieron luego una inyección del moho mencionado, murieron siempre. Lo que salió bien en la cápsula de Petri - donde el moho destruyó las bacterias- no resultó en los animales experimentales. Hoy ya sabemos por qué. Fleming no consiguió extraer del moho, en cantidad suficiente, la sustancia milagrosa que cura a millones de personas en todo el mundo: la penicilina. Lo que inyectó a ratones y conejos era una disolución muy diluida de penicilina. En tan pequeña cantidad no bastaba para matar a enemigos del hombre tan resistentes como las bacterias.
Tiempo después, cuando le preguntaron a Fleming por qué no pudo llevar a cabo su descubrimiento, contestó modestamente: - Yo no soy más que un bacteriólogo, y para extraer del moho una cantidad suficiente de penicilina era necesario un químico. Y no lo teníamos en nuestro hospital.
8. Diez años de investigaciones
De vez en cuando algún médico se fijaba en el artículo que había publicado Fleming, después de su descubrimiento, en una revista técnica; algunos trataron de repetir el experimente, pero nadie logró arrancar su secreto al moho misterioso. Nadie pudo obtener la cantidad de penicilina necesaria para hacer experimentos adecuados no sólo en animales experimentales sino también en seres humanos. Incluso el doctor Fleming, diez años después de su descubrimiento, llegó a declarar que todo intento de producir penicilina industrialmente fracasaría.
Sin embargo, los que continuaron, si bien sin completo éxito, la obra de Fleming, afirmaron que:
- El moho pierde su poder milagroso de destruir las bacterias después de algunos días,
- No sólo él puede destruir otras bacterias, sino que existen en el aire muchos otros organismos que pueden destruirse incluso a sí mismos, exactamente como lo hacen los ácidos y las bases,
- No le conviene el calor; por eso es necesario conservarlo en refrigeradores a bajas temperaturas,
- Y tal vez lo más importante: existe un procedimiento químico que permite extraer con mucho trabajo, y sólo en pequeña cantidad, una penicilina más pura que la que consiguió Fleming. ¿Cómo? Se agrega a la disolución en que se desarrolla el moho, agua destilada y éter, para que se disuelva la penicilina. Esta disolución diluida se concentra aplicando vacío brevemente para que se evapore el éter, y se eliminan luego algunas otras materias superfluas. Naturalmente, no se obtiene así todavía la penicilina sólida y pura que deseaban los que habían reparado en el descubrimiento de Fleming.

Figura 15. Oxford, antigua ciudad universitaria inglesa, donde varios químicos y médicos continuaron, durante la segunda guerra mundial, la obra que empezó el doctor Alexander Fleming.
9. La muerte ayuda a la vida
La segunda guerra mundial empezó en 1939. No sólo a los campos de batalla, sino también a las ciudades de las islas Británicas llegaba la muerte con los aviones alemanes.
En la antigua ciudad universitaria de Oxford, algunos médicos y químicos decidieron acabar lo que Fleming había comenzado. Esto quiere decir encontrar la manera de obtener penicilina pura del moho, para curar a los heridos. Y en efecto, el joven químico F. P. Abraham y el doctor F. B. Chaine lograron construir el primer aparato para la producción de la penicilina. Era un aparato muy primitivo, hecho con algunas botellas y unos tubos de vidrio. Por un extremo del tubo entraba la disolución impura de penicilina, proveniente del moho, por el otro extremo entraba éter. Las dos corrientes se encontraban, el éter, que tiene un peso específico más bajo que el agua, subía y el agua descendía. Como la penicilina se disolvía en el éter, subía con él por el tubo, y en el agua quedaban sólo numerosas impurezas que el químico quería eliminar. Abraham completó este tubo de vidrio con otro tubo grande en forma de U, que llevaba una llave. Cuando el joven químico la abría, salía el éter con la penicilina disuelta y caía en un receptáculo.
Es verdad que Abraham y Chaine obtuvieron una disolución que contenía más penicilina que nunca antes, pero aun así no era todavía penicilina pura. Entonces agregaron a la solución toda clase de sustancias químicas como zinc, cobre, mercurio, plomo - incluso uranio y quinina- con la esperanza de que con alguna se combinase la penicilina dando un precipitado de naturaleza salina que contuviera penicilina pura. Hasta que un día - eso fue en 1940- estudiaron la utilidad del óxido de aluminio. Este polvo blanco, parecido al almidón corriente, tiene una propiedad interesante e importante. Es como si absorbiera muchas sustancias que se le agreguen. Abraham hizo pasar por un tubo lleno de este cuerpo una disolución de color pardo rojizo de penicilina impura en éter. El polvo de óxido de aluminio se apoderó instantáneamente de las impurezas presentes en la solución, y en el tubo aparecieron tres capas de colores, como si las hubieran pintado: pardo, amarillo claro y pardo oscuro. Según averiguó Abraham, no había más que huellas de penicilina en la primera y la tercera capa. La segunda - la de color amarillo claro- contenía 80% de la preciosa sustancia. Pero Abraham no se contentó con aquello. Filtró el producto amarillo oscuro, lo enfrió y de nuevo le agregó éter para extraer otra vez la penicilina, más libre ahora de impurezas. La pureza aumentaba con cada una de las operaciones químicas. Pero faltaba eliminar el agua para conseguir la sustancia. ¿Qué hacer? Si Abraham calentaba la disolución acuosa de penicilina, la penicilina perdía su facultad de destruir las bacterias, se descomponía. Ya sabemos que no tolera temperaturas elevadas. Pero el joven químico sabía que la temperatura de ebullición de un líquido depende de la presión atmosférica, que se ejerce sobre la superficie del líquido, como si se le pusiera encima un peso. ¿Es esta presión atmosférica igual en todas partes? ¿Al nivel del mar o en la cumbre de una montaña? No. El agua necesita calentarse mucho más antes de empezar a hervir en un lugar bajo que en las cumbres de las montañas, donde el aire está más enrarecido. Abraham lo sabía muy bien; por eso hizo evaporar el agua de la disolución de penicilina de esta manera: conectó con la máquina neumática el recipiente que contenía la disolución, y entre las dos partes puso un recipiente para recibir el agua que se evaporaba. El recipiente con la disolución se metió en hielo seco. La temperatura no tardó en descender hasta -40° C, al aspirar el aire la máquina neumática. El agua congelada se evaporaba, la máquina neumática extraía el vapor y en las paredes del primer recipiente apareció un polvo amarillo congelado: penicilina. Penicilina sólida, por primera vez en el mundo.
Más tarde - fue en el año 1942- se obtuvieron cristales de penicilina. Terminemos este corto relato de las largas vacilaciones, penas e investigaciones en pos del medicamento milagroso, la penicilina, con estas palabras, que conocemos ya por otro de los capítulos de este libro: sólo es difícil lo que no nos atrevemos a hacer. Tal vez muchas de las fábricas inglesas y estadounidenses no se daban cuenta de esta verdad pues se preguntaron mucho tiempo si debían o no intentar producir penicilina. Sólo la necesidad ocasionada por la guerra las decidió a empezar a fabricar esa sustancia, sin la cual es difícil imaginar la ciencia médica moderna.
10. Miles de unidades en un solo pinchazo
¿Se acuerdan del día que vino el médico a casa, les miró la garganta y pidió: - Diga "a"? Luego movió la cabeza: - Anginas. Con trescientas mil unidades tal vez bastará. Sacó la jeringa, la llenó con un líquido lechoso y antes de poder protestar ya había recibido uno varios miles de unidades de penicilina.
¿Qué son exactamente estas unidades? ¿Quién las inventó y por qué?
Cuando los médicos y químicos trataron, hacia 1940, de producir la penicilina más pura posible, tuvieron que definir una manera de averiguar si la penicilina que acababan de producir era más eficiente que la obtenida antes. ¿Qué hicieron? Simplemente escogieron una disolución de penicilina que ya conocían y designaron como unidad la cantidad de penicilina contenida en un centímetro cúbico de esta disolución. Esta unidad - este centímetro cúbico de solución de penicilina- podía destruir la bacteria llamada estafilococo dorado ( Staphylococcus aureus ) en una cápsula de Petri en un círculo de 24 milímetros. Cuando se obtenía otra disolución de penicilina, sólo había que comparar su eficiencia con la de la unidad básica. Lo hacían así: en una cápsula ponían cierta cantidad de la nueva disolución y en otra, igual cantidad de una disolución conocida. Agregaban estafilococos dorados a las cápsulas, colocaban éstas en un incubador (una especie de armario, calentado por electricidad, donde se puede mantener una temperatura uniforme) y las dejaban allí de 12 a 16 horas. Durante este tiempo se formaban zonas en donde la penicilina había destruido las bacterias. Comparando las superficies de estas zonas en las dos cápsulas se lograba decidir no sólo si la nueva disolución era más eficiente que la primera, sino también en qué grado. Así nació la unidad internacional de penicilina.
No hay que asustarse, pues, de los grandes números de unidades que tal vez nos recetará algún día el médico. Indican sólo dosis de penicilina capaces de destruir las bacterias responsables de la enfermedad, y además demuestran hasta qué punto la penicilina de hoy es más eficiente que la que conocían los médicos y químicos hace veinticinco años.
Hoy se lucha eficazmente con la penicilina contra las bacterias que causan supuraciones, pulmonía y mil padecimientos más.
11. ¿Qué es la penicilina?
Mucho hemos hablado de la penicilina, y sin embargo no sabemos todavía exactamente lo que es. No lo supieron, por mucho tiempo, ni siquiera quienes descubrieron la sustancia y sus propiedades benéficas. Hoy sabemos que es un ácido débil secretado por un moho ( Penicillium notatum ) para defenderse de sus enemigos. Debemos saber también que los químicos han logrado producir sintéticamente penicilina, es decir sin el moho. Pero la preparación de esta penicilina resulta tan cara que no vale la pena fabricarla así.
Olvidábamos mencionar que existen varias especies de penicilina. La forma obtenida depende de qué materias químicas se agreguen durante su formación por el moho. Las distintas especies de penicilina se designan con letras mayúsculas: G, V, H, F, etcétera.
- ¿Y cómo obtienen la penicilina en la fábrica? ¿Lo mismo que cuando la investigaban Fleming, Abraham y Chaine? - pregunté a uno de los ingenieros de una fábrica de penicilina.
Se sonrió, tomó un lápiz y empezó a dibujar en un pedazo de papel.
Yo veía con qué rapidez se complicaba el dibujo.
Cuando terminó, el ingeniero me preguntó: - ¿Entiende usted esto? - y me enseñó su croquis. Volvió a sonreír al ver mi confusión y empezó a explicarme:
- Sin duda cree usted que hoy se produce la penicilina en las fábricas de una manera completamente diferente que en los años cuarenta, en los laboratorios de Oxford.
De repente el repiqueteo del teléfono interrumpió nuestra conversación. El ingeniero escuchó un momento sin decir palabra.
- Gracias, llegamos dentro de un momento - dijo, y colgó.
- ¿Qué estaba diciendo? - preguntó- . Ah, sí. Pues bien: todavía hoy la penicilina se fabrica exactamente como hace veinte años. La materia prima inicial sigue siendo el moho, Penicillium notatum , la misma especie de moho que descubrió el doctor Fleming. Naturalmente, la producción en la fábrica está más perfeccionada, mucho más que hace veinte años. Se lo enseñaré.

Figura 16.
El ingeniero se acercó al estante, sacó un libro, lo hojeó un momento y me enseñó una fotografía.

Figura 17. Con este aparato fue obtenida la primera penicilina.
- Lo que ve a la izquierda es el primer aparato utilizado para la producción de penicilina. Lo construyó uno de los investigadores de Oxford, el doctor N. G. Heytley. Arriba a la derecha aparecen los estreptococos amplificados 1.000 veces. Todavía no les pasa nada. Abajo, los estreptococos ya están en lucha con la penicilina. Fíjese cómo se reducen las bacterias.
Luego el ingeniero me señaló con el lápiz un círculo y unos puntos blancos. - Esta gran mancha blanca es el moho. Estas manchitas blancas son los estreptococos que ya venció la penicilina. Es como si los disolviera. Y finalmente el último dibujo: vea el vaso completamente cubierto de bacterias, menos en los cinco círculos negros, donde no se encuentra ninguna.
Interrogativo, miré al ingeniero.
- De veras no. Porque esa especie de tubos son vasitos que contienen penicilina. Por eso no hay ninguna bacteria alrededor de ellos.
Examiné la fotografía un momento.
- Y ahora nos debemos ir - dijo el ingeniero.
Cruzamos el pasillo; al otro extremo había una puerta pintada de blanco con una placa donde decía con letras negras:
Nadie contestó. En el patio de la fábrica alguien silbó. Luego se oyó el estruendo de unos bidones y el silbido se apagó. Nada.
El ingeniero tiró del picaporte. Estaba cerrada la puerta.
- La laboratorista me llamó por teléfono hace un momento para que viniéramos, pero ha salido ya. Qué le vamos a hacer; la esperaremos y para no perder tiempo le explicaré mientras tanto lo que se hace en un laboratorio micológico.
Estábamos de pie ante la puerta con la placa blanca y las letras negras. El ingeniero se apoyó en la pared y empezó a hablar:
- El trabajo en el laboratorio micológico no se diferencia en general mucho de lo que hicieron Fleming o Abraham. Nosotros también empezamos con el moho. Las esporas de mohos se guardan en conserva - naturalmente no en las latas de carne o de sardinas que se llevan a una excursión, sino en tubos de cristal cerrados a la llama. Las esporas son mohos en estado latente, como decimos nosotros; esto es, los microorganismos se encuentran en una situación que no les permite multiplicarse, porque no están en condiciones indicadas para eso. Empiezan a reproducirse sólo cuando les proporcionamos estas condiciones, cuando les ofrecemos agua y calor, lo cual se realiza prácticamente poniendo las esporas en contacto con el medio de cultivo. El ingeniero sacó el papel donde había dibujado el esquema de la producción de la penicilina un rato antes, y me señaló con su lápiz el cuadrado número 2.
- ¿Y qué es para ustedes el medio de cultivo? - le pregunté.
- Es un caldo de carne de res, endurecido con un extracto de alga marina que pescan los buzos y que se llama agar-agar. Son filamentos grises, secos, que se hinchan en el agua. Hay quien utiliza también el agar-agar para hacer jaleas para los pasteles de frutas.

Figura 18. Parte biológica de la producción

Figura 19. 3 Tanque de siembra; 4 Tanque de fermentación
- ¿Por qué agregamos el agar-agar al caldo?
- Si no agregáramos este producto de algas marinas al caldo, el moho no se formaría más que en la superficie del medio. Pero necesitamos una capa muy gruesa y por eso debemos espesar el caldo, que es poco consistente.
- El moho obtenido así ¿no bastará para la producción de la penicilina en la fábrica?
- Claro que no. Por eso lo pasamos a los tanques de siembra, después de haberse multiplicado en el caldo - el ingeniero me enseñó el recipiente cilíndrico que había dibujado un momento antes y que había designado con el número 3- . Allí hay algunos cientos de litros de agua a temperatura un poco más baja que la del cuerpo humano. Para que el moho se reproduzca lo más rápidamente posible agregamos al agua azúcar, almidón, harina de soya o residuos de maíz. Esto es la siembra.
Por el otro extremo del pasillo se oyeron pasos. La laboratorista regresaba. Se disculpó, la llave dio unas vueltas en la cerradura y entramos en el lugar donde se hace esta medicina maravillosa, la penicilina.
Debo reconocer que a primera vista quedé desilusionado. Nada en este laboratorio micológico recordaba la producción industrial: ninguna máquina, nada de lo que se ve en las fábricas. En los estantes había tubos cerrados a la llama.
- Sentémonos cerca de la mesa - dijo el ingeniero- . De momento se tendrá que contentar con el laboratorio micológico y mi croquis - me enseñó el dibujo que había hecho en el papel un momento antes- . Debe tener un poquito de paciencia antes de llegar a la verdadera producción industrial de penicilina.
Quisiera enseñarle primero en este esquema el proceso de producción del principio hasta el fin, para que se dé una idea general. Luego veremos la verdadera producción industrial. ¿Adónde habíamos llegado?
- Al tanque de siembra, al cual se agregan azúcar, almidón.
- Bien.
El ingeniero señaló con su lápiz el número 4 del dibujo, donde estaba escrito "tanque de fermentación": - Ya hay algunos miles de litros de líquido en este recipiente. A decir verdad, es en él donde se reproduce el moho, pero es allí también donde muere. Y es precisamente al morir cuando libera la penicilina. Con esto termina la parte biológica de la producción de la penicilina y el químico empieza a hablar.
- Al fin - suspiré. Afuera se oyó otra vez un silbido y otra vez también el estruendo de los bidones.
12. Milagro sin milagro
- La primera preocupación del químico es deshacerse del micelio (el organismo del moho) del que sale la penicilina - siguió diciendo el ingeniero- . Esto se consigue en filtros rotatorios - y señaló el número 5 en el dibujo- . No es nada más que una tina donde gira un tambor forrado con una red fina. El aire es aspirado del tambor por una máquina neumática, junto con el líquido. Éste atraviesa fácilmente la red fina. El micelio, que no interesa al químico, se queda en el tambor. La disolución de penicilina que obtenemos así es, por supuesto, inestable, hay que enfriarla y se debe trabajar rápidamente.
- ¿Por qué es inestable? ¿Y qué se hace con ella?



Figuras 20,21 y 22. Izquierda, filtro rotatorio con vacío, centro, sistema de extracción, derecha, filtro



Figuras 23,24 y 25. Izquierda, llenando los frascos , centro, sublimación con vacío, derecha, penicilina terminada

Figura 26. Penicilina lista para salvar vidas humanas
- Si hubiéramos dejado la disolución un poco más de tiempo, se habría echado a perder, su composición química hubiera cambiado tanto que resultaría imposible extraer de ella la penicilina que es lo que buscamos precisamente. Ahora le diré cómo se trabaja. Como vio, empezamos con una cantidad insignificante de agua y pronto llegamos a varios miles de litros de disolución. Ahora trataremos de eliminar el agua. Para eso mezclamos esta disolución diluida de penicilina con un disolvente líquido que no se mezcla con el agua, pero que disuelve la penicilina. Hay menos disolvente que agua: tratamos siempre de eliminarla. La dejamos salir, y con esta eliminación de grandes volúmenes de agua nos acercamos a la meta: obtener penicilina sólida.
- ¿Cuánta penicilina pura se encuentra en el líquido que conseguimos?
- Poca. Muy poca.
- Entonces ¿cómo obtienen penicilina sólida de este líquido tan diluido?
- Hasta este momento la penicilina estaba en forma ácida, gracias al disolvente agregado; por eso no se disolvió en el agua. Agregando al disolvente una lejía que es básica, como ya sabe, obligamos a la penicilina a disolverse de nuevo en agua.
¿Otra vez agua, después de extraerla de ella antes?
- No debe olvidar que se usa esta vez mucho menos agua que antes; recuerde que la que eliminamos era muchísima. Por eso la disolución será ahora más concentrada: mientras menos agua, más penicilina. Si hablara como una lavandera y no como un químico, diría que exprimimos la penicilina por todos los medios posibles con la ayuda de ácidos y bases hasta lograr eliminar todo el líquido. Así que debemos deshacernos del agua otra vez; en pocas palabras, debemos extraer la penicilina del agua otra vez. Por eso tratamos de disolverla en una materia química que pueda evaporarse fácilmente al final. Naturalmente, la penicilina debe disolverse primero.
- Y esta materia es el éter de Fleming y de Abraham, ¿verdad? - pregunté.
- De ninguna manera. Aquí es cloroformo. Para que pase la penicilina al cloroformo debemos acidificarla, sino el cloroformo no la acepta.
- ¿Eso quiere decir que le agregan algo ácido?
- Sí. Por ejemplo ácido sulfúrico.
- ¿Y el cloroformo está en tan enorme cantidad como el agua al principio?
- Qué va. Se usan unos litros de cloroformo nada más. Agregamos a la disolución el cloroformo y a él pasa toda la penicilina. Sólo en este momento, la disolución clorofórmica, que llamamos segundo concentrado, se filtra a través de una capa de amianto que los microorganismos no pueden atravesar. Esto quiere decir que obtenemos una solución estéril, es decir sin bacterias, que no tienen nada que hacer en la penicilina.
- Pero todavía no tenemos más que una solución de penicilina, no penicilina sólida.
- Claro. La disolución se vierte, por medio de tubos graduados automáticos, en frasquitos donde se seca - y ya está la penicilina.
- ¿Espera que se evapore el disolvente en los frascos?
- Habría que esperar mucho tiempo. Hacemos lo que hizo Abraham, si se acuerda usted todavía. Congelamos la disolución a -40° C y luego la evaporamos al vacío; al polvo de penicilina que conseguimos así basta ponerle un tapón. En las fábricas muy modernas no es necesario siquiera congelar la disolución. Basta agregar algunos compuestos químicos para obtener cristales de penicilina pura. El ingeniero señaló una vez más con su lápiz la última figura de su dibujo.
- En fin: es sencillo - sonrió.
- ¿Sencillo? - lo miré de reojo.
- De veras es sencillo. En este juego con grandes y pequeños volúmenes de disoluciones, no se trata más que de obtener penicilina sólida.
El ingeniero dobló el papel donde había hecho el esquema de la producción de penicilina y me lo tendió.
- Y ahora vamos a ver cómo son los tanques de fermentación y de siembra, los filtros: en fin, todo lo que se emplea en la producción de penicilina.
Al terminar de visitar la fábrica de penicilina, me despedí del ingeniero.
- Gracias por sus explicaciones sobre la producción de la medicina milagrosa - dije.
- ¿Milagrosa? - se extrañó el ingeniero- . Tal vez se consideró antaño la penicilina como una medicina milagrosa, pero hoy ya no. ¿Oyó usted alguna vez algo del organismo Streptomyces aureofaciens ? - No esperó mi respuesta y siguió hablando: - Fabricamos con él, por un proceso parecido al de la penicilina, una medicina que sirve para curar enfermedades infecciosas que no se pueden tratar con la penicilina. Este moho libera, al morir, en lugar de penicilina, clorotetraciclina.
- ¿Cómo se llama eso? Cloro
- Déjelo - me interrumpió el ingeniero- . Se llama aureomicina. Tal vez le interesará saber que con la clorotetraciclina no hacemos medicinas sólo para personas.
Miré al ingeniero con curiosidad.
- Gracias a la clorotetraciclina podemos dejar al Sol una semana aves muertas y la carne no se descompone. Basta rociar el pollo o el pavo, recién muerto, con una disolución diluida de clorotetraciclina. La carne de res dura más tiempo, si se pone al animal una inyección de este producto antes de matarlo. Hoy la industria moderna de la fermentación no puede pasarla sin esta nueva sustancia química. De la misma manera, la industria cervecera no podría existir tampoco sin ella. La clorotetraciclina elimina, por ejemplo, las levaduras "silvestres" que no tienen nada bueno que hacer en la cerveza. Y por lo demás no les hace ningún daño a las levaduras necesarias a la producción de la cerveza.
Miré el reloj. Me despedí del ingeniero y salí a la calle oscura. Había andado apenas unos cientos pasos cuando oí un bocinazo. Un automóvil se detuvo en la casa de enfrente; bajó un médico apresurado. Seguramente en el maletín del doctor, al lado de la jeringa, estaba la medicina milagrosa y de uso corriente para nosotros hoy: la penicilina.
LA CAJA DE PANDORA

Figura 1. En la mitología griega, Pandora abrió por curiosidad la caja que debería contener los dones de los dioses. De la caja salieron toda especie de males, peripecias y dificultades, que oprimieron al mundo desde aquella época. Quedó una sola esperanza en el fondo de la caja.
Contenido:
1. El fuego griego, dos monjes y una sola pólvora
2. Dos mil grados centígrados en un milésimo de segundo
3. La pólvora en bolsa de seda
4. Las rocas se abren, la tierra tiembla
5. Explosivos preparados con harina y madera
6. El almirante y el barril de hojalata
7. Medicina para el dolor de cabeza
8. La fábrica flotante
9. Un descuido, un poco de arcilla y mucha sed
10. El dedo herido
11. ¡Adiós, pólvora negra!
12. La carta secreta
13. Solución
14. La fábrica que no parece una fábrica
15. El testamento de Nóbel
1. El fuego griego, dos monjes y una sola pólvora
Hasta hoy los historiadores no han logrado ponerse de acuerdo sobre quién descubrió la pólvora y cómo. Unos afirman que fueron los habitantes de la India, dos mil años antes de nuestra era, otros están convencidos de que los chinos conocían ya la pólvora negra hace mil años. Por lo que se refiere a Europa, la situación es igualmente confusa. Unos están dispuestos a darle la prioridad a un monje alemán, Berthold Schwarz, quien, en lugar de entregarse piadosamente al examen de conciencia, pasaba la mayor parte de su tiempo mezclando azufre, salitre y carbón de leña.

Figura 2. Máquinas con las cuales lanzaban, en la Edad Media, las famosas faláricas sobre los barcos y las ciudades cercadas.
Estaríamos dispuestos a concederle una patente por ser el primer europeo que preparó pólvora negra en 1340, si no fuera porque otros le niegan tal prioridad y, como prueba de lo que dicen, recurren a los escritos de otro fraile, inglés esta vez, Roger Bacon, quien ya en 1249 había descrito lo que descubrió Berthold Schwarz cien años más tarde. Lo único cierto es que en la Europa del siglo XIV, la pólvora negra apareció en todos los campos de batalla.

Figura 3. Falárica
Pero ya antes de que las espesas nubes de humo empezaran a invadir los campos de batalla después de los disparos de los cañones, los europeos conocían otra especie de explosivo. Era el fuego griego. Su fabricación era en realidad sencilla: se mezclaban azufre, nitro y resina, y se impregnaba con esta mezcla un pedazo de estopa enrollado en un palo. Esta lanza tenía un nombre muy bonito: falárica. La estopa impregnada de combustible se encendía y estos proyectiles admirables que a veces hasta estallaban, eran lanzados contra los barcos enemigos y contra las ciudades cercadas, con ayuda de máquinas lanzadoras.
Pero regresemos a la pólvora, que está más cerca de los explosivos que la estopa pringada de azufre y resina. En el siglo XVII no eran sólo los artilleros los que preparaban la pólvora negra sino que se empezó a fabricar - lo decimos exagerando un poco- "industrialmente". No era únicamente por consideración a los soldados, quienes a veces no tenían mucho tiempo para fabricar pólvora, sino sobre todo porque este explosivo tenía mucha demanda hasta cuando las bocas de fuego callaban. Es que en el siglo XVII empezó a utilizarse la pólvora con fines más nobles que el de matar gente: para extraer minerales.
Hasta el siglo XIX, la mezcla de nitrato de potasio, azufre y carbón de leña, llamada pólvora negra, era propiamente el único explosivo conocido en el mundo. En aquella época, no se sabía mucho de las propiedades químicas de este mensajero de destrucción. La gente no hacía más que aprender a utilizar la pólvora de una manera práctica. Pero a menudo pagaban sus experiencias muy caro, precisamente porque no conocían los procedimientos químicos que se desarrollaban durante la explosión.
Miremos, pues, la pólvora negra con los ojos del químico moderno.
2. Dos mil grados centígrados en un milésimo de segundo
¿Qué es exactamente una explosión? ¿Cómo es posible que un pedacito de materia aparentemente inofensiva, pueda derribarlo todo en una fracción de segundo? Muchos se rompieron la cabeza durante mucho tiempo buscando la respuesta, hasta que descubrieron que la explosión es muy parecida a la combustión corriente. La única diferencia es que en la explosión la energía escondida en la materia se libera mucho más de prisa. La generación de los gases es más vigorosa, tiene la violencia del relámpago.
¿Creerían ustedes que un kilogramo de benceno al arder libera más energía que la misma cantidad de dinamita? No les aconsejo experimentarlo, pero así es. Sólo que el benceno libera su energía lentamente, mientras que la dinamita libera toda la suya en una fracción de segundo. Pero a veces este terrible explosivo puede quemarse tranquilamente, es decir sin explosión. Veamos cómo. La principal sustancia que entra en la composición de la dinamita es la nitroglicerina. Aprenderemos más cosas acerca de ella y de la dinamita más tarde. Cuando se acerca una llama a la dinamita, la nitroglicerina que contiene empieza a arder. El calor que se produce en la combustión pasa de una capa de dinamita a la otra. Como la dinamita no conduce bien el calor, el fuego se extiende despacio, de una capa pasa a la otra, los gases que se liberan en la combustión escapan lentamente al aire y se dispersan tranquilamente. Esperamos la explosión en vano. No pasa nada; la dinamita que debería derribarlo todo con un estruendo espantoso se quema tranquilamente.

Figura 4. Granada de cañón
¿Qué tipo de explosivo es éste que no explota? ¿No estaba húmedo, por casualidad? ¿O era producto defectuoso? Ninguna de las dos cosas. Ya habrán comprendido lo que pasó. La combustión fue paulatina, los gases que se desprendieron no encontraron nada en su camino - hallaron espacio libre- , se escaparon al aire: la dinamita se quemó.
Pero hagamos esto ahora de una manera un poco diferente. Hagamos que la dinamita reciba un choque violento. De esta forma el calor provocado por el golpe será más elevado que cuando acercamos la llama a la dinamita. La primera capa de dinamita se encenderá mucho más violentamente, los gases se generarán mucho más pronto y en mayor cantidad, y como no tienen tiempo de disiparse lentamente, ejercerán presión sobre la siguiente capa de dinamita, con fuerza considerable. Ésta se descompondrá a su vez, habrá otros gases, otra presión, y así sucesivamente, como un alud. En un corto instante se alcanza una temperatura de 2 000 grados centígrados y una presión de miles de atmósferas. ¿Pueden imaginarse tal temperatura? Cuando hace 30° en casa abrimos todas las ventanas porque hace demasiado calor; aquí en una fracción de segundo surge en este pedacito de materia una temperatura casi cien veces más elevada. Las ondas de explosión debidas a la dinamita alcanzan una velocidad superior a 6 000 metros por segundo.
No necesito insistir en que la presión de estas ondas es considerable: una atmósfera - tal se llama la unidad de presión- equivale a un kilogramo sobre un centímetro cuadrado, y en la explosión la presión es de varios miles de atmósferas: barre todo lo que encuentra en su camino.
Ahora tenemos idea de lo que es capaz una explosión, y conocemos también aproximadamente el mecanismo que la provoca, pero todavía no sabemos lo que pasa desde el punto de vista de la química durante la explosión.

Figura 5. Casoillo
Si analizáramos el explosivo en sus elementos, averiguaríamos que contiene carbono, nitrógeno, hidrógeno y oxígeno. Éstos son los cuatro autores del terrible estruendo y de la devastación que deja la explosión. No tienen ningún sentido del humor: en cuanto se llama violentamente a la puerta de su castillo de dinamita, hay agitación adentro, arman un remolino infernal, pero en seguida concluyen alianzas entre ellos, que se llaman en química anhídrido carbónico y óxido de carbono, óxidos de nitrógeno y buena cantidad de vapor de agua. Y toda esta conjura militar sale y ataca con la velocidad del relámpago. Y el hombre se conforma con llamar explosión a esta maravillosa acción, como si no se distinguiera de cualquier estruendo corriente.
3. La pólvora en bolsa de seda
Pero ¿qué hacer con este producto indisciplinado, ante el cual el hombre mismo no está seguro? ¿Cómo dominarlo? Imagínese usted que carga un cañón y que la carga le destruye el cañón. O que quiere disparar a las trincheras del enemigo, a algunos kilómetros, y que el proyectil cae en sus propias líneas. ¿Qué hacer para que el proyectil salga por la boca del cañón y llegue a donde quiere usted que vaya, artillero?
Nuestros antepasados, que utilizaban únicamente la pólvora negra, variaron las proporciones de azufre, salitre y carbón de leña, hasta conseguir fabricar explosivos que, a decir verdad, no lanzaban el proyectil lejos, emitían nubes de humo y obstruían bastante el cañón, pero al menos éste quedaba entero. Con la experiencia descubrieron que, mientras más grandes eran los granos de pólvora, más lentamente ardían y más despacio también se formaban los gases. Sabemos que los gases que se forman rápidamente derriban todo lo que encuentran en su camino. Se trataba de escoger el tipo de granos de pólvora y las proporciones de ingredientes que provocaran, al encenderla, la formación de una cantidad de gases capaz de disparar el proyectil del cañón, de darle la velocidad necesaria, sin dañar el cañón.

Figura 6. Las cargas de explosivos se preparan automáticamente, de manera que la mano del hombre no las toca. Para eso se utiliza la máquina que vemos en el grabado.

Figura 7. Alfred Nóbel amasó con sus manos la dinamita que acababa de inventar. Hoy se mezclan las materias explosivas en este aparato.
El estopín desempeñaba un papel muy importante para encender la carga explosiva. Era un tubito de cobre lleno de mezcla explosiva, atravesado por un alambre unido a una anilla. Cuando el artillero tiraba de ésta, el alambre (frictor) provocaba un frotamiento dentro del tubito y con ello la explosión de la carga.
Recordemos esa especie de oleaje que se propaga por la dinamita después de un golpe. Aquí pasa algo parecido. La oleada de gases que se forma en el tubito avanza hacia un paquete de pólvora que está encima de la carga explosiva. En una bolsa de seda está el mediador entre el estopín y la carga: la pólvora negra.
De este modo nuestra vieja conocida, la pólvora negra, descubierta no sabemos ni siquiera hace cuántos siglos, desempeña valientemente su papel hasta hoy. Es el mediador entre el hombre y la explosión que quiere someter a su voluntad.
4. Las rocas se abren, la tierra tiembla
Hasta ahora hemos hablado de los explosivos que utiliza el hombre contra el hombre. Afortunadamente ésta no es la única manera de utilizar esa energía contenida en ciertas sustancias químicas que ya han causado al hombre tantas desgracias. El fusil no sirve sólo para propósitos militares, sino que es también un buen auxiliar del cazador. Los explosivos industriales son grandes servidores de la humanidad. Son una varita mágica que abre las rocas para que el tren pueda recorrer el túnel que perfora la montaña, cargado de ese carbón que ayuda al hombre a calentarse en el invierno y a fabricar medicinas, combustibles, colorantes y también más explosivos.
Al contrario que en la artillería, al usar los explosivos industriales no tenemos interés en que sea paulatina la presión que generan los gases. Al contrario: queremos que el explosivo se descomponga químicamente cuanto antes y libere los demonios destructores que contiene.
Que la detonación ocurra lo más rápidamente posible, ya que deseamos que la explosión destroce al instante y por completo lo que queremos destruir. ¿Cómo conseguir la máxima fuerza de destrucción? Es sencillo: mientras más compacto sea el explosivo, más apretadas estarán sus capas, una contra otra, y más rápido y potente será el infernal oleaje de gases. Para hacer más compacta la materia que queremos utilizar, se la somete a presión, dándole en general forma cilíndrica. Luego los cilindros se envuelven en papel parafinado para proteger el explosivo de la humedad.
Y ahora que sabemos lo que es un moderno explosivo, escuchemos la historia de cómo fue inventado', y por quién.
5. Explosivos preparados con harina y madera
A principios del siglo pasado, el químico francés Braconnot quiso saber qué pasaría tratando con ácido nítrico la harina corriente que, sirve para hacer el pan. No pasó nada en particular. Entonces aquel hombre curioso puso papel en un vaso de precipitados y le echó ácido nítrico. Y otra vez no pasó nada especial. A Braconnot se le había metido en la cabeza tratar con ácido nítrico todas las formas de lo que se llama en química celulosa, o sea la materia que constituye el componente principal de la madera y el papel. Vertió también ácido nítrico sobre la harina. El químico francés lavó luego todos sus preparados con agua, cuidadosamente, los dejó secar y luego acercó una llama a todos, uno tras otro. Todos se consumieron rápidamente sin dejar residuo. Braconnot escribió sobre el particular un artículo sabio en el cual casi nadie reparó.
¿Qué importa que se consuma una harina tratada con ácido nítrico? Sería mejor que el profesor nos dejara en paz con tales ocurrencias.
Después de muchos años, otro químico leyó el artículo de Braconnot. Se llamaba Schönbein, era alemán y vivía en Suiza. Él también empezó a jugar con el ácido nítrico. Pero le agregó otro ácido más, ácido sulfúrico, y no trató con esta mezcla harina ni fibras de madera, sino algodón. ¿Por qué precisamente algodón? Porque el algodón es lo que más se acerca a la celulosa pura. El algodón contiene hasta noventa por ciento de celulosa, nueve décimas partes, mientras que la madera contiene apenas cincuenta por ciento.
Luego repitió la prueba del francés curioso. El resultado fue sorprendente: el algodón tratado con la mezcla de ácidos nítrico y sulfúrico estalló. Ya en el año de su descubrimiento - 1846- empezó a fabricarse en grandes cantidades el nuevo explosivo, tan eficaz.
- ¡Qué va! ¡La pólvora negra es un juguete comparada con el algodón pólvora! - decían los químicos y los fabricantes del nuevo explosivo. Tenían razón. Sólo que su alegría y admiración por el algodón pólvora no duraron mucho. El nuevo explosivo milagroso estallaba cuando quería. Las fábricas volaban y ni siquiera se podía hablar de utilizar el nuevo producto para impulsar proyectiles de cañón. Reventaban los cañones y mataban a los artilleros, en lugar de matar al enemigo.
Al fin su uso fue prohibido en la mayoría de los países y los europeos desagradecidos regresaron humildemente a la pólvora negra.
Un solo hombre no dejó de creer en el algodón pólvora, el químico Frederick Abel. Quería averiguar simplemente por qué el algodón pólvora estallaba solo. Debía haber alguna razón para que se descompusiera espontáneamente. Examinó concienzudamente la composición del algodón pólvora, averiguó cuánto ácido quedaba en él. Y descubrió que quedaba bastante ácido en el algodón pólvora y que precisamente eran estos residuos la causa de las explosiones espontáneas.
Ideó una manera de lavar el algodón pólvora con agua en unos aparatos especiales, para que desaparecieran con el agua los últimos indicios inconvenientes de ácido.
Es cierto que el algodón pólvora ya no estallaba solo tan a menudo después de este lavado, en los campos de batalla, pero no se ganaba gran cosa con ello, pues en la mayoría de los casos se conducía como un loco y, así, no quedaba más que utilizarlo sólo como explosivo no militar. Las rocas se rompían y la tierra temblaba. Pero no era el explosivo que deseaban los soldados: fácil de manejar, dócil, no variable ni dispuesto a hacer lo que quisiera.
6. El almirante y el barril de hojalata
Durante la guerra de Crimea, que hacían los ingleses, los franceses y los turcos a los rusos, en los años 1853-1856, los aliados buscaban derrotar a los rusos no sólo en el mar Negro - de donde el nombre de guerra de Crimea- sino también en el norte de Europa, en el mar Báltico.

Figura 8. EL PUERTO DE CRONSTADT, como lo veía el corresponsal de guerra del periódico "Leipziger Kriegszeitung" en la época de la guerra de Crimea.
El almirante Charles Napier, comandante de la marina inglesa, recibió la orden de apoderarse de Cronstadt, penetrar en la desembocadura del río Neva y bombardear Leningrado, que se llamaba entonces Petrogrado. El Almirante escribía a diario en su cuaderno de bitácora. Anotaba detalladamente todo lo que pasaba en el mar, anotaba hasta lo que comía, y si le gustaba o no. En mayo y junio de 1855 anotó:
“23 de mayo. Mientras tanto nada logramos. Nuestro único éxito fue la toma de Bomarsund, en las islas Aland, pero desde entonces - y ya pasaron nueve meses- no podemos acercarnos a Petrogrado de ninguna manera. Los rusos han cerrado la desembocadura del Neva con una cadena de minas que nos tienen perplejos. Ya nos dañaron dos barcos. Las minas rusas tienen una eficacia extraordinaria. Mandé clavar un aviso prometiendo una recompensa de 10 libras a quien logre pescar siquiera una sola mina rusa.
26 de mayo. El segundo oficial del crucero, el duque James Lindwell, por poco gana las 10 libras. Hoy, inmediatamente después del amanecer, vio una mina que, según creyó, flotaba libremente sobre la superficie del mar. Hizo echar un bote al agua y con cuatro marineros trató de pescarla con una red. Pero el mar estaba muy inquieto, Lindwell no pudo acercarse a la mina y después de dos horas de vanos esfuerzos tuvo que abandonarla.
28 de mayo. ¡Tuvimos una mina rusa! Al fin la pudimos pescar. Desgraciadamente, explotó mientras la examinábamos y un marinero perdió la vida. Estamos casi donde antes. Sólo sabemos que el tal milagro ruso no es más que un barril de hojalata lleno de algún explosivo. ¡Y tal obstáculo nos impide penetrar en la desembocadura del Neva!
6 de junio. Según las noticias que recibimos hoy por la mañana, el inventor de las minas que impiden llegar a Cronstadt es un sueco. Parece que hace algunos años inventó un torpedo que fue probado con éxito en un viejo barco ruso. Ya hace bastante tiempo que vive en Petrogrado, donde fabrica explosivos”.
Hasta poco antes de concluir la paz en París, en 1856, cuando terminó la guerra de Crimea, los ingleses no se enteraron de lo que había impedido entrar en la desembocadura del Neva.

Figura 9. El Almirante CHARLES NAPIER, comandante de la armada inglesa.
En el barril de hojalata había una carga de algodón pólvora, los barriles estaban ligados unos a otros, en varias hileras, y como los ingleses no sabían nada de aquella nueva arma, no tomaron Cronstadt ni se pudieron acercar a Petrogrado para bombardearla. El inventor de las minas marinas se llamaba Emmanuel Nóbel y era el padre de Alfred Nóbel, considerado aún ahora como el más grande de los inventores en la historia de la fabricación de explosivos modernos.

Figura 10.
7. Medicina para el dolor de cabeza
En 1847 el químico italiano Ascanio Sobrero obtuvo una sustancia líquida que tenía por fórmula química C 3 H 5 (NO 3 ) 3 y que recibió el nombre de nitroglicerina. Los médicos, en la primera mitad del siglo pasado, descubrieron que aquel líquido incoloro y oleoso, de sabor dulzón, tenía efecto calmante para las personas irritadas. Los químicos averiguaron además que era venenoso y que amenazaba peligrosamente la vida si los obreros trabajaban mucho tiempo con él. Y además la nitroglicerina era explosiva, aunque no como la pólvora negra. No había que encenderla para que explotara; era necesario dar un golpe a la nitroglicerina, sacudirla para que despertara de su pereza y demostrara de qué era capaz. En pocas palabras, estallaba sólo por percusión.
El hijo de Emmanuel Nóbel, Alfred, fue un joven digno de admiración. Asistió a la escuela sólo hasta los 16 años, luego decidió ayudar a su padre. Después de una estancia de diecisiete años en Petrogrado, éste regresó pobre a Suecia, a pesar de haber inventado el torpedo y las minas; sin embargo, se propuso encontrar alguna materia química que formase con la nitroglicerina un explosivo en el verdadero sentido de la palabra. Un explosivo que el hombre pudiera dominar y llevar de un lugar a otro sin peligro de que explotara de repente el cargamento. El joven Nóbel sabía que podría alcanzar su meta sólo mezclando la nitroglicerina con alguna otra materia para dar un explosivo sólido. En el año 1863, el joven de treinta años patentó una mezcla de nitroglicerina y pólvora negra, que llamó aceite explosivo. Era más eficiente que la nitroglicerina; sin embargo, no era posible hacerla estallar con la mecha que se utilizaba para la pólvora. Era necesario darle un golpe. Y un golpe involuntario - lo mismo pasaba con la nitroglicerina- provocaba una explosión inesperada. Por último, el aceite explosivo era un líquido, no una materia sólida. Alfred Nóbel hizo más de cincuenta experimentos. Más de cincuenta veces la nueva mezcla explosiva estalló cuando él no quería. Hasta que una tarde que estaba sentado en la oscuridad de su laboratorio, en la ciudad de Heleneborg, se le ocurrió una idea genial y encontró la manera de darle un buen golpe a la nitroglicerina, que no explota sólo bajo el efecto del fuego. Esto era lo que más lo enojaba. Nóbel tomó un tubito de cobre y le puso fulminante de mercurio, que, como sabía él, estalla a una temperatura relativamente baja. Pensó que los gases que se formarían darían a la nitroglicerina el golpe necesario. Agregó al tubo una mecha y lo puso en su aceite explosivo. Aquella misma tarde salió al patio y empezó a experimentar en un rincón. Encendió la mecha y corrió a esconderse. Esperó la explosión inútilmente. La mecha ardió, ardió, pero se apagó a la mitad; era defectuosa. Nóbel respiró: lo malo era la mecha y no su idea. Cambió de mecha, la encendió y otra vez corrió al rincón. En la noche se oyó un estampido muy fuerte para la cantidad tan pequeña de explosivo que Nóbel había utilizado en su experimento. Las ventanas de las casas cercanas empezaron a abrirse, los vecinos sobresaltados por el ruido se preguntaban qué había pasado.
- Otra vez ese loco no nos deja en paz. Deberían prohibirle hacer este escándalo.
Los vecinos enojados cerraron sus ventanas y volvieron a la cama. Al día siguiente mandaron una solicitud al ayuntamiento de la famosa ciudad de Heleneborg, para "poner término al juego peligroso con materias explosivas de un ciudadano de este lugar, Alfred Nóbel, quien no sólo en el día sino también en la noche amenaza la calma y la integridad de ciudadanos honrados".
El mismo día Alfred Nóbel fue a solicitar que le concedieran una patente por la "cápsula detonadora".
Este invento se sigue considerando el más importante en el campo de los explosivos desde la época que vio la primera pólvora.
8. La fábrica flotante
Sin embargo, a los vecinos antipáticos y asustadizos de Alfred Nóbel no les faltaba razón. Lo que hacía aquel hombre solitario y encerrado en sí mismo, en medio de un barrio muy poblado, era peligroso.

Figura 11
La demostración no se hizo esperar mucho tiempo. El 3 de septiembre de 1864 voló por los aires toda la producción de nitroglicerina y aceite explosivo de Nóbel, en Heleneborg. Y debajo de los escombros del taller destruido quedaron algunos obreros y con ellos también el más joven de los hermanos de Nóbel. Inmediatamente al inventor desdichado se le prohibió instalar, en el mismo lugar "o en cualquier otra parte donde viva gente", otra fábrica de aceite explosivo.
Nóbel buscó en vano cerca de Estocolmo un terreno donde poder construir. En todas partes encontraba una negativa cortés. ¿Quién hubiera aceptado como vecino a un hombre que, como todos sabían, podía provocar otra vez una explosión en cualquier momento?
"¿Debo rendirme? - escribía Nóbel a uno de sus amigos- . ¿Rendirme precisamente ahora, cuando he logrado inventar un explosivo que supera con mucho lo que imaginara el mundo hasta ahora? Jamás."
- Si la tierra no me quiere, tal vez me acepte el agua - se dijo el sueco tenaz, y mandó construir una balsa con una barraquita encima, sobre un lago cerca de Estocolmo. Lejos de la ribera estaba aquella extraña fábrica de explosivos, pero no tan lejos que su dueño estuviera en paz. Los pescadores que pasaban todos los días le gritaban al inventor obstinado que los dejara en paz, no porque les importara que volara con toda su cocina infernal, sino porque sería una lástima que muriesen peces. Alfred Nóbel no les contestaba, se conformaba con remolcar su balsa todavía más lejos de la ribera.
Hasta que un día encontró dos personas que ni le gritaron ni trataron de evitarlo de lejos. Uno era diplomático, el otro capitán de marina, y los dos prometieron ayudarlo a regresar a tierra firme. Y así lo hicieron. Convencieron al gobierno sueco de que permitiera a Nóbel construir una fábrica cerca de Estocolmo. Y después de errar un año en una balsa de madera por el lago Mälaren, Alfred Nóbel regresó a tierra, a un laboratorio bien instalado.
Esto es sólo un acto del drama que culmina con el descubrimiento del explosivo más destructor de nuestra época, la dinamita.
9. Un descuido, un poco de arcilla y mucha sed
Todos reconocían que el aceite explosivo descubierto por Alfred Nóbel era más potente que la pólvora, por ejemplo. Pero todos sabían también de las innumerables explosiones espontáneas del explosivo de Nóbel. El sueco incansable se rompía la cabeza en vano buscando qué agregar a la nitroglicerina para hacerla más estable, más manejable, para poder transportarla de un lugar a otro sin peligro y para que estallara sólo cuando quisiera el hombre y no cuando se le antojara a ella.
Para esto era necesario transformar el líquido en materia sólida, agregar a la nitroglicerina algo que la amansara y dominase. Ensayó en vano una materia química tras otra. La nitroglicerina no se dejaba dominar. ¿Tendría que interrumpir la producción de nitroglicerina? Los ferrocarriles no querían transportar aquel explosivo tan peligroso, algunos países no sólo habían prohibido su uso, sino que no permitían tampoco que las cargas de aceite explosivo de Nóbel atravesaran sus territorios.
Como un proscrito, Nóbel buscó un país donde le permitieran fabricar su aceite peligroso. Al fin fundó una nueva fábrica, cerca de Hamburgo esta vez.
Un día - fue en el año 1866- llegó Nóbel a la nueva fábrica y se llevó un susto. Todo el contenido de un barril de nitroglicerina se había derramado por el suelo. Nóbel llamó al capataz en seguida.
- ¿Cómo pudo ocurrir esto? - preguntó señalando el líquido derramado.
El capataz empezó a balbucear, buscando una disculpa, y quiso limpiar la nitroglicerina del suelo.
- ¡Un momento! - Nóbel cogió del hombro al capataz asustado- . Se puede ir - añadió simplemente.
El desdichado pensó que estaba despedido y otra vez empezó a balbucear algo, pero Nóbel ya no lo escuchaba. Se inclinó sobre la nitroglicerina derramada en el suelo y hasta le agregó con cuidado unas cucharadas más del barril.
- ¿Ve eso? - se volvió al capataz que estaba de pie, inmóvil, detrás de él, y que había renunciado a explicarse el comportamiento de aquel sueco estrafalario- . Mire cómo absorbe.
Sólo en aquel momento el capataz se dio cuenta de que la nitroglicerina había empapado la arcilla del suelo. La arcilla se utilizaba entonces en el transporte de la nitroglicerina. Para que no se sacudieran los recipientes en que se transportaba el explosivo, los metían precisamente en arcilla blanquecina. Alfred Nóbel empezó en seguida sus experimentos. Echó nitroglicerina sobre un poco de arcilla y apreció que esta arcilla la absorbía bien. Podía absorber hasta tres veces su propio peso de nitroglicerina. Para conseguir arcilla muy pura y con el mínimo de agua posible, la secó y la recoció. Luego mezcló de 20 a 30 partes de arcilla con 70 a 80 partes de nitroglicerina y agregó a esto la mitad de su peso de sosa calcinada. Amasó esta pasta amarillenta con sus propias manos, luego hizo pequeños prismas con ella y los envolvió en papel parafinado.
Así nació el nuevo explosivo que Nóbel llamó dinamita, por la palabra griega dynamis , que quiere decir fuerza. Aquello era un diablo disciplinado que no explotaba cuando se le antojaba, sino que esperaba que un golpe que generase una temperatura por lo menos de 180°C lo despertara de su sueño. Permitía incluso que le dispararan un tiro de una escopeta y ni siquiera se inmutaba. Era tan bonachón que se dejaba encerrar en barriles de hojalata y hundir en el agua. Pero pobre del barco que se atreviera a chocar con él.
Pasaron muchos, muchos años desde el día que Alfred Nóbel se enfureció al ver la nitroglicerina derramada por el suelo en la barraca de madera cerca de Hamburgo. Sin embargo, hasta ahora no ha cambiado mucho la fabricación de la dinamita, desde la época del sueco taciturno. La materia que consolida la nitroglicerina ya no es arcilla, sino un polvo que contiene nitrato de potasio, aserrín y sosa. Y la dinamita ya no se amasa con las manos. Pero explota más espantosamente que en 1870, durante la guerra franco alemana, cuando la usaron por primera vez para matar en grande. Deshace las rocas, el carbón, vuela los puentes como cuando se oyó su nombre por primera vez en el mundo. Se toman más precauciones en las fábricas de dinamita que en aquella época. Nadie puede entrar con zapatos en el lugar donde se fabrica este producto peligroso. Hay que llevar calzado de hule, que no incluya la menor partícula de metal. Ninguno de los que trabajan con nitroglicerina o dinamita pueden llevar ni una llave en el bolsillo. Y la luz que alumbra la cocina mágica del químico que fabrica dinamita es indirecta, da en las paredes, como si se temiera que desencadenara el mismo aquelarre de demonios que vieron más de una vez, hace cien años, los que trataron de someterla a su voluntad.
10. El dedo herido
La dinamita no se hizo famosa cuando los periódicos de todo el mundo trajeron la noticia de su descubrimiento, sino un año más tarde, cuando un barco que transportaba 200 barriles de dinamita al Perú estalló a algunos kilómetros de la capital de este país, Lima. Entonces todo el mundo quedó convencido de que el nuevo explosivo era el más potente que el hombre había inventado. Sólo Nóbel no lo creyó. Pensaba que si lograba cambiar la arcilla, que no es en sí un explosivo, por una materia química que lo fuese también, la mezcla de nitroglicerina y dicha materia - desconocida por el momento- podría tener un efecto todavía más violento. Y otra vez trató de agregar a la nitroglicerina algún producto químico.
Un día de 1875, Nóbel se hirió un dedo. Y siguiendo la costumbre de entonces, se lo pintó con colodión. El colodión no es nada más que algodón mojado en una mezcla de ácidos nítrico y sulfúrico y luego disuelto en éter etílico. (Al mojar el algodón en los ácidos nítrico y sulfúrico se forma la nitrocelulosa; este proceso químico se llama nitración.)
Se fue a acostar, pero el dolor lo despertó por la noche; la herida le ardía, el colodión no servía de nada. Ya no podía ni pensar en dormir. Daban las dos de la mañana en la torre de la iglesia. Nóbel se levantó y empezó a examinar el dedo dolorido. Y fue al laboratorio en lugar de volver a la cama. Es que cuando vio con qué rapidez se había secado el colodión sobre el dedo y qué membranita traslucida se había formado, se le ocurrió averiguar cómo se conduciría esta medicina con la nitroglicerina. ¿No podría el colodión hacer con la nitroglicerina algo parecido a lo que hizo sobre el dedo? ¿No sería precisamente aquélla la materia química que buscaba con tanta ansia para solucionar el problema que lo acosaba desde hacía tanto tiempo? Empezó a agregar colodión a la nitroglicerina y esperó, inquieto, para ver qué sucedería. Vio con asombro que la nitroglicerina se mezclaba perfectamente con el colodión y que daba con él una materia sólida parecida a la que formaba con la arcilla. Pero era una materia que no se parecía a la pasta, sino a una gelatina amarillenta, casi transparente. Nóbel se olvidó completamente del dedo dolorido y pasó el resto de la noche dedicado al nuevo invento.
Cuando llegó uno de sus asistentes por la mañana al laboratorio, Nóbel pudo mostrarle el nuevo invento en un vaso de precipitados. A este explosivo hoy lo llamamos gelatina explosiva y resultó ser más potente que la dinamita. ¿Por qué? Porque el carbono que contiene el algodón del colodión se apodera ávidamente del oxígeno de la nitroglicerina. Precisamente por eso durante la detonación, cuando los demonios sueltan sus cadenas, se produce más calor y más gases que en el caso de la dinamita.
Y la gelatina explosiva es todavía mejor que la dinamita en otro sentido: congelada o mojada no cambia de propiedades.
Por eso es posible utilizarla sin ocuparse de la temperatura que indique el termómetro. La dinamita de arcilla se congela ya a 8°C, no bajo cero, sino sobre cero, y en ese momento se torna extraordinariamente peligrosa. Basta la menor excitación, el menor golpe, y se oye la violenta explosión. Desgraciadamente, quedaron convencidos de esto muchísimos dinamiteros que, en lugar de dejar la dinamita de arcilla deshelarse poco a poco - no al fuego, sino en aparatos especiales para calentar con agua tibia el recipiente con la dinamita congelada- , trataron imprudentemente de introducir la carga de explosivo en la horadación.
11. ¡Adiós, pólvora negra!
Hablemos ahora de otro descubrimiento del sueco taciturno y solitario, Alfred Nóbel.
A fines del siglo pasado los cuarteles generales de todos los países se empeñaron en que los químicos fabricasen una pólvora que no dejara una nube de humo después del disparo.

Figura 12. Pólvora sin humo aumentada siete veces.
No sólo era que los soldados que manejaban el cañón no veían, por culpa del humo, si habían dado en el blanco, sino que el enemigo veía, por la posición de las nubes de humo, de dónde habían disparado, dónde estaban colocados los cañones adversarios, lo cual ayudaba a apuntar a su vez. Pero no era sólo eso.
La pólvora negra atacaba la boca metálica de los cañones; después del disparo, el azufre contenido en la pólvora negra se combinaba con el potasio del salitre (sabemos que el salitre - o nitrato de potasio- fue desde siempre uno de los componentes de la pólvora negra), y se formaba sulfuro de potasio que obstruía la boca del cañón y la corroía.

Figuras 13 y 15. Hoy se muelen el nitrato, el carbón y el azufre en molinos de bolas de acero. Se representan el modelo antiguo y el más moderno de los molinos de bolas.
Y así los químicos de todo el mundo se pusieron febrilmente a trabajar. Todos deseaban inventar una pólvora sin humo.

Figura 14. El azufre, el carbón de leña y el nitrato se pulverizaban, hasta fines del siglo XVIII, en morteros de piedra o de madera movidos mecánicamente.
Algunos trataron de reducir algo la cantidad de azufre, así las nubes de humo eran menos densas, pero el proyectil no llegaba tan lejos como querían los artilleros. Otros buscaron la solución en el uso de toda suerte de carbones de leña - en vano. Nadie logró fabricar lo que deseaban tanto los soldados. Y así los químicos perdieron la paciencia uno tras otro. Hasta que un día, en 1884, un francés llamado Vieille disolvió el algodón pólvora en éter etílico.

Figura 15. Moderno molino
Consiguió una jalea parecida a la gelatina explosiva de Nóbel. Vieille la amasó, la comprimió y por fin la transformó en cintas que partió en rectangulitos, y los puso a secar. Y los artilleros franceses empezaron a cargar los cartuchos con aquel producto dorado y traslúcido. Después del disparo ya no salía humo, sino que la llama provocada por la combustión de los gases, salía por la boca del cañón. Otros imitaron en seguida al francés. La antigua pólvora negra, de la cual no pudieron prescindir los guerreros europeos durante largos siglos, había terminado su misión. Pero no completamente. Queda hasta hoy como recuerdo de los viejos tiempos, como mediadora entre la voluntad del hombre y el explosivo moderno que se utiliza para llenar los cartuchos, porque el hombre se entiende mejor con ella. Así consigue el estallido en el momento que desea.
Prometí narrar otro descubrimiento del sueco taciturno y les he contado lo del francés Vieille. En seguida veremos por qué.
12. La carta secreta
Vieille era desdichado. Fue a visitar algunos almacenes de su pólvora. No vio nada sospechoso en ninguno de ellos. No descubrió en ninguna parte las manchas blanquecinas ni tampoco las vejigas que, según parece, algunos oficiales habían visto en la pólvora almacenada en Grenoble. Vieille regresó a su laboratorio muy preocupado y sobre todo convencido de que alguien había provocado cierta explosión.

Figura 16
El fracaso no lo hizo desistir. Por medio de un análisis minucioso, averiguó que la pólvora "enferma" contenía menos alcohol que la sana; el éter, que servía para disolver la nitrocelulosa se evaporaba, la pólvora cambiaba de composición química y escapaba así a la voluntad del hombre.
- Trataré entonces de disolver la nitrocelulosa en algo que no sea este éter tan volátil e inestable - se dijo Vieille, y cambió el éter por alcohol amílico. Cierto era que esta vez las manchas blanquecinas aparecían menos a menudo, pero sin embargo aparecían. Los almacenes de pólvora seguían volando.
Entonces los químicos, llenos de ardor, empezaron a desempeñar la tarea que les habían encomendado: encontrar algo que impidiera las explosiones espontáneas. Siguieron un camino un poco diferente: - Si no podemos encontrar una sustancia que impida que se estropee la pólvora - se dijeron- , trataremos de encontrar la manera de reconocer con seguridad y a tiempo la pólvora "enferma" que podría estallar.
Pues las manchas blanquecinas no eran una señal bastante segura. No aparecían en toda la superficie de la pólvora, y así algunas manchitas que pasaban inadvertidas podían provocar una catástrofe.
Primero lograron averiguar que sólo 10 gramos de pólvora sospechosa, calentados en un tubo a 110°C, le decían a uno si la pólvora almacenada iba a estallar sola, e incluso cuándo: los 10 gramos de pólvora emitían vapores de óxido de nitrógeno bajo el efecto del calor. Tantas horas como pasen antes de que aparezcan los vapores, durará en meses la pólvora almacenada tranquilamente, a una temperatura de 40 °C. Luego estallará sola.
Cierto jefe de un almacén de pólvora francés, hasta entonces desconocido pero cuyo nombre figuró más tarde en la historia de los explosivos - se llamaba Lepidi- , llegó todavía más lejos. Estaba convencido de que aquella manera de averiguar si la pólvora explotaría sola no era cien por ciento segura. Por eso, durante la fabricación de la pólvora sin humo le agregó algo de difenilamina que, como sabía él, se combinaba con los vapores nitrogenados peligrosos. Esta difenilamina alterada ya no era igual que la difenilamina pura, y esto se podía descubrir fácilmente en la pólvora sospechosa. Bastaría con deshacerse de la pólvora sospechosa antes de que estallara.
Aquel capitán tenía razón; la difenilamina daba al polvo que se estaba estropeando un color tan expresivo - primero era rojo, luego pardo y al fin amarillo- , que era posible destruir a tiempo el explosivo peligroso.
Todo estaría muy bien, si no fuera por una pequeñez la pólvora sin humo estallaba a veces por su cuenta. No en el almacén, donde la podían vigilar, sino en el tubo del cañón. Regresemos de una vez al sueco taciturno, que sintió un poco no haber sido el primero en lograr solucionar el problema que quito el sueño a tantos soldados y químicos.
13. Solución
Alfred Nóbel creía en la nitroglicerina incondicionalmente. Pues aquella materia química, que antaño no servía más que para calmar un poco a las señoras irritadas, aquel producto fue, entre todos, el que lo condujo al descubrimiento del aceite explosivo, la dinamita y la gelatina explosiva. Este producto de fórmula química C 3 H 5 (NO 3 ) 3 ¿no le señalaría también el camino hacia la solución del problema que no pudieron resolver ni Schönbein ni Vieille? Y se lo señaló. Nóbel utilizó de nuevo la nitroglicerina como producto inicial en sus experimentos. Esta vez mezcló el aceite explosivo con el algodón pólvora y a la mezcla le agregó alcanfor, para que el producto final fuera lo más homogéneo posible. Y de la mezcla nació un explosivo que tenía todas las propiedades que deseaban los soldados: se podía utilizar en artillería, no estropeaba ni obstruía los cañones y no emitía nubes negras de humo. Además era una materia tan homogénea que los artilleros podían calcular exactamente la cantidad de gases formada en el momento de la explosión, la velocidad del proyectil y, sobre todo, su alcance. Esto era, naturalmente, una gran novedad en los campos de batalla.
Alfred Nóbel dio a su nuevo explosivo el nombre de balistita. Otros lo llamaron pólvora de Nóbel.
Terminemos con este relato sobre los descubrimientos e inventores de explosivos, que nos sirvió para conocer no sólo la composición química de los explosivos, sino también la voluntad asombrosa de los químicos que no temieron los fracasos ni los obstáculos y siguieron trabajando pacientemente hasta que encontraron lo que buscaban.
Añadiremos solamente algunas palabras, para saber si se interrumpió el desarrollo de la producción de explosivos en el momento que Alfred Nóbel solicitó la patente por su balistita, en 1888. Claro que no. Los químicos buscaron - y hasta hoy siguen buscando- explosivos cada vez más terribles, pero también más seguros. Descubrieron, por ejemplo, que si se extrae la hulla de las minas con explosivos corrientes, se encadenan dos explosiones: en primer lugar estalla la carga que se introduce con cuidado en la horadación; estalla además el grisú, ese gas de las minas tan peligroso, que el químico llama metano y que ha sido causa de tantas desgracias. Pero de esto tampoco nadie sabía nada. La mezcla de metano y aire se inflama ya a 650-760°C, y la temperatura a que estallan los explosivos pasa de 1 000°C. ¿Qué hacer para que el explosivo estalle a una temperatura inferior a los peligrosos 650°C que hacen detonar el metano? Es cosa sencilla: agregamos a los explosivos sales inorgánicas, por ejemplo cloruro de sodio o bicarbonato de sodio, que absorben ávidamente el gran calor liberado en la explosión. Así aparecieron los llamados explosivos de seguridad, que se usan en las minas.
Durante sus investigaciones infatigables, los químicos descubrieron también que el alquitrán de hulla, obtenido como sabemos, y del cual provienen colorantes y medicinas, conviene perfectamente para la fabricación de explosivos.
Averiguaron que, por ejemplo, un colorante amarillo canario, obtenido del maloliente y pegajoso alquitrán, colorante que se llama ácido pícrico, es un explosivo terrible para cargar granadas. Cuando se emplea así se llama ecrasita.
El comandante inglés Shrapnel inventó un proyectil perforado por varios canales largos llenos de pólvora y bolitas de plomo. La combustión de la pólvora y la explosión del proyectil dependen del número de canales.
Este comandante vivió antes que Nóbel y hace ya mucho tiempo que murió; sin embargo, su nombre se recuerda y los soldados de todo el mundo lo conocen, precisamente porque los químicos tomaron la idea del comandante británico y la perfeccionaron de una manera increíble.
Los explosivos son numerosos. Pero todos tienen una cosa en común: por una parte matan, por otra, ayudan al hombre. Pero la mayoría de ellos no hubiera podido fabricarse sin un proceso químico particularmente importante que se llama nitración.
Veremos eso visitando una fábrica de explosivos.
14. La fábrica que no parece una fábrica
Cuando recibí por primera vez permiso para visitar la fábrica de explosivos, me asombré un poco. ¿Esto es una fábrica? Pues no tiene ni siquiera una buena chimenea: altas cercas por todas partes, de alambre de púas, alrededor de algunas barracas que a fin de cuentas ni siquiera se pueden ver bien. Y entre estas barracas, murallas de arcilla con hierba y abedules.
Pero si recordamos todas las explosiones que ha presenciado el mundo, comprenderemos que todo esto está arreglado a propósito. Si estalla un taller, no deben hacerlo los demás también. Se protegen los demás lugares de trabajo con murallas de arcilla y hormigón contra las oleadas de gases que se forman en la explosión temida.
Entremos en un taller donde se nitra la glicerina, donde se hace lo que hizo muchos años atrás el sueco Alfred Nóbel, con este líquido oleoso, incoloro, dulce, que es el residuo de la fabricación del jabón. En lugar de los vasos de precipitados, cápsulas, matraces y tubos de vidrio de Nóbel, encontramos recipientes de plomo. Sus paredes tienen un centímetro de espesor, y, si quieren ustedes, pueden mirar adentro, aunque naturalmente sólo por una ventanilla de vidrio que se encuentra en la tapa del recipiente.
Me olvidaba decir que antes de que me dejaran entrar, tuve que ponerme un calzado de hule, dejar los cerillos y escuchar unos consejos, el más importante de los cuales fue que no me portara como los explosivos de la época de Schönbein o Vieille; en pocas palabras que hiciera lo que me dijesen y no lo que se me ocurriera. Volvamos ahora al aparato de nitración. Todo el recipiente está enfriado por numerosos serpentinas de plomo, que se encuentran dentro del aparato y por los que fluye salmuera. Una tubería lleva al recipiente una mezcla nitrante compuesta de ácido nítrico concentrado y ácido sulfúrico; y por otro tubo entra glicerina. Todo esto se mezcla con aire comprimido, no con un palo, como en la época de Nóbel.

Figura 17. Producción de la nitroglicerina. La glicerina se mezcla con una solución nitrante en el nitrador, debajo del cual se encuentra una tina de seguridad. La solución va del nitrador al primer lavador, de allí al segundo. Sin embargo esto todavía no basta. Todavía no se logran eliminar todas las impurezas, por eso la nitroglicerina debe pasar por un filtro.
Que no se nos olvide la parte tal vez más importante del aparato de nitración: los termómetros. Sin ellos nadie podría saber de ninguna manera, ni siquiera hoy, si iba a estallar todo, en especial ahora que la mayor parte de la fabricación de explosivos está automatizada. En cuanto llega el mercurio de los termómetros al número 27 quiere decir: ¡Cuidado, peligro! Entonces hay que cerrar el alimentador de ácidos, enfriar más la disolución que hay en el aparato, y si esto no basta y el termómetro pasa de 27°C, deshacerse de todo el contenido del aparato de nitración vaciándolo en una tina de agua fría. Basta dar la vuelta a una llave. Y esta tina tiene un nombre apropiado, se llama tina de emergencia.
Pero ¿qué pasa si todo marcha bien en el aparato de nitración? La glicerina, esta glicerina inofensiva, escoge un consorte agresivo, el ácido nítrico, adquiere sus propiedades explosivas y pasa a llamarse nitroglicerina (o correctamente, en química, trinitroglicerina o éster del ácido nítrico y la glicerina). Y el ácido sulfúrico les sirve de testigo y además es el que provoca de hecho el matrimonio. En ese momento dos miembros aparentemente decentes de la familia química se unen para formar una pareja peligrosa, capaz de causar perturbaciones inimaginables.
Miré la boda tempestuosa por la ventanilla. Cuando terminó, todo entró en paz. El que me acompañaba me dijo que teníamos que esperar un momento para que reposara, es decir, para que se separara la nitroglicerina de los residuos de ácidos. Parece que esto no tarda mucho tiempo. La nitroglicerina es más ligera, se queda en la superficie, y los residuos de ácidos nítrico y sulfúrico, que son más pesados, bajan al fondo y automáticamente pasan por un tubo a un depósito. Mientras, me enteraba de algo que pasó precisamente en aquel taller, hace muchos años, antes de que lo reformaran.
En aquella época el aparato de nitración todavía no estaba completamente automatizado. Hoy el líquido se lleva, después de reposar, a una tina revestida de azulejos y allá se sigue lavando a una temperatura de 25°C, mezclándolo incesantemente con aire comprimido y cambiando el agua. En resumen, se eliminan los últimos residuos de ácidos, que ya no tienen nada que hacer en la boda de la glicerina. Se agrega una disolución de sosa, para que el lavado sea lo más perfecto posible. Hace algunos años, agregó esta disoda a la tina un individuo que además de trabajar en la fábrica de explosivos era músico. Iba a todas las bodas y a todos los entierros a tocar el contrabajo. Un domingo amaneció tocando y fue directamente de la boda a la fábrica. Tenía sueño y estaba cansado, pero aguantó como todo buen músico. Todo marchó bien hasta el momento en que el músico, en su nuevo papel de obrero de fábrica química, tuvo que agregar la disolución de sosa a la nitroglicerina que estaba reposando.
- ¿Por qué echar en agua la sosa? - se dijo el músico- . Agua no falta aquí, vierto directamente la sosa y por lo menos esta nitroglicerina se limpiará más pronto y descansaré antes.
Y descansó en paz. Voló con la bolsa casi llena todavía, con el aparato y con toda la fábrica. No quedó absolutamente nada de él. No se le ocurrió al desdichado que la nitroglicerina no hace más que esperar la menor oportunidad, y se la dio la gran cantidad de sosa que en un abrir y cerrar de ojos hizo que el mercurio de los termómetros subiera por encima de los críticos 27°C. Bastó esto para que el músico no volviera a tocar jamás el contrabajo.
Todavía no se contenta el químico con el estado en el cual se encuentra la nitroglicerina que dejamos antes de empezar a contar la historia del infeliz músico. La filtra por una franela tendida en un marco de madera, y para que no quede ni una sola gota de agua en la nitroglicerina, echa en la franela sal común que absorbe completamente el agua.
Aquí termina la fabricación de la nitroglicerina. De la franela pasa a los tanques de plomo de fondos inclinados y provistos de una llave. La nitroglicerina es conducida de ahí a donde la necesitan: fábricas de dinamita, balistita o gelatina explosiva.
De la misma manera que hay que nitrar la glicerina con ácidos nítrico y sulfúrico, se nitran también residuos de algodón, si se trata de obtener algodón pólvora. La nitración es la llave que abre las secretas cerraduras que, durante largos años, guardaron muchas materias químicas, aparentemente inofensivas pero que al final resultaron furias peligrosas. ¡Cuántas cosas tienen que hacerse para tenerlas encadenadas! Por ejemplo, a diario hay que limpiar las llaves que están en contacto con la nitroglicerina, para que su obstrucción no provoque algún frotamiento disimulado. A diario hay que lavar el suelo para que no vaya a quedar allí ni una pizca de explosivo. Y se debe procurar que todos los aparatos qué ayudan a echar al mundo los demonios furiosos escondidos en los explosivos, estén conectados con la tierra, para que no se acumule electricidad estática en ninguna parte, lo cual podría dar a los espíritus malignos la señal de iniciar una fiesta peligrosa.
Comparemos las precauciones del químico experimentado con el comportamiento irresponsable de los niños imprudentes que creen que nada les puede pasar si fabrican explosivos o si juegan con ellos cuando les caen entre manos.
15. El testamento de Nóbel
Cuando alguien pedía a Alfred Nóbel que escribiera su autobiografía, el químico sueco contestaba: - No tengo tiempo para escribir sobre mí. Si quiere le cuento mi vida en pocas palabras: Alfred Nóbel, cuya miserable vida debió cortar al nacer algún médico filantrópico. Sus ventajas: no se aprovechó nunca de nada, nunca fue una carga para nadie. Principales insuficiencias: no tuvo familia, era malhumorado y tenía mala digestión. Su único deseo: no ser enterrado vivo. Su pecado más grande: no suspiraba por el dinero. Acontecimiento importante en su vida: ninguno.
Ninguna de las biografías que se escribieron más tarde puede aclarar la personalidad del hombre que no pudo encontrar paz en ninguna parte del mundo, ni sobre la tierra, ni sobre el agua, ni en Suecia, ni en Alemania ni en Francia, ni en Italia, y cuyo genio trajo tantos sufrimientos y una ayuda tan grande a la humanidad.


Figuras 18 y 20. "Inventas vitam iuvat excoluisse per artes". La invención ayuda al progreso de la vida por medio de la ciencia. Esta cita del poeta romano Virgilio adorna la medalla de oro que reciben los laureados con el premio Nóbel.
Alfred Nóbel, propietario de muchas patentes relativas a la fabricación de explosivos, pero también a métodos de fabricación de frenos automáticos y calderas a prueba de estallidos, condecorado por casi todos los monarcas de su época, aplazó el fin de su vida, disolviéndose debajo de la lengua grageas de nitroglicerina dulzona. Enfermo del corazón, los médicos le recomendaron - como siguen haciéndolo muchas veces- utilizar la sustancia que causa la muerte a otros en los campos de batalla.
El 27 de noviembre de 1895, Nóbel escribió de su mano, sin abogados ni testigos, su última voluntad que, en opinión de algunos, compensa sus invenciones destructoras. Deseaba que todos sus bienes se convirtieran en dinero después de su muerte y que los intereses sirvieran para recompensar, cada año, a quienes hubieran hecho más por la humanidad. Los intereses debían ser divididos en cinco partes iguales, para premiar los logros en la física, la química, la medicina, la literatura y la fraternización y el desarme de los pueblos. Cada año la Academia de Ciencias de Suecia debe decidir qué físico y qué químico recibirán el premio que lleva el nombre del inventor de la dinamita, la gelatina explosiva y la balistita. El Instituto Médico de Estocolmo escoge al médico, la Academia de Bellas Artes al escritor, un comité de cinco miembros de la Cámara de Diputados de Noruega al laureado con el Premio de la Paz.
Murió Nóbel el 10 de diciembre de 1896. Sus bienes se convirtieron, como lo deseaba él, en 33 250 000 coronas suecas. Después de deducir gastos y herencias menores, quedaron 31 250 000 coronas suecas. Esta enorme cantidad de dinero representa la base de la donación de Nóbel. Cada año, el aniversario de la muerte de Alfred Nóbel, se entregan de manera solemne los premios que llevan el nombre de este gran sueco solitario que quiso sin duda descargar su conciencia.

Figura 19. El Académico JAROSLAV HEYROVSKÝ junto a un polarógrafo moderno, por cuyo invento le fue otorgado el premio Nóbel. A la izquierda, el primer polarógrafo de Heyrovský.
El único checoslovaco que ha obtenido hasta ahora el Premio Nóbel es el académico Jaroslav Heyrovský. En 1959 le fue otorgado por la invención de la polarografía, importante método analítico, sin el cual la química moderna no sería lo que es.
Ya que pronunciamos la palabra "polarografía", ¿en qué consiste propiamente? Trataremos de explicarlo en pocas palabras. Si se quiere averiguar la composición de una disolución, se la conecta por medio de dos electrodos a un circuito eléctrico. De uno de los electrodos caen gotas de mercurio regularmente en la disolución. El líquido no quisiera dejar pasar la corriente, se defiende más o menos - por así hablar- según los elementos o compuestos químicos que contenga. Según la tensión de la corriente, que se mide en voltios, se logran reconocer los elementos o compuestos presentes en la disolución; según la intensidad de la corriente, medida en microamperios, se determinan sus concentraciones exactas.
DE LA MADERA AL CARBÓN
Contenido:
1. El secreto del hueso de la cereza
2. Los predecesores de Gottlob Keller
3. Vestidos de explosivo
4. Juego de construcciones inagotable
5. Sombrero de requesón
6. Bombas sobre Oahu
7. Reunión secreta
8. Brujerías con moléculas
9. El hombre paciente de Wilmington
10. El error que costó millones
11. ¿Casualidad o plan preciso?
12. Tobera en lugar de alambre
13. Del ámbar al PVC
14. El hombre que no sabía química
15. Buscan una pizarra blanca
16. El profesor y el carbono
17. Botones en lugar de pizarras
18. La carta de Rochester
19. Al principio fue el "coccus lacca"
20. Adiós, profesor
21. El boticario de Praga
22. Carniceros y amas de casa
23. Cien años perdidos
24. Acetileno + ácido clorhídrico = PVC
25. Parecidos y sin embargo distintos
1. El secreto del hueso de la cereza
Friedrich Gottlob Keller era hombre digno de admiración. Pasaba sentado la mañana y la tarde ante su máquina de tejer, en la pequeña ciudad sajona de Heinrichen. Tejía y meditaba. Luego, antes del anochecer, salía al bosque y al campo y se fijaba como solía decir en todo lo que sabe hacer la naturaleza mejor que el hombre.

Figura 1.
La gente se reía de Keller cuando lo veían inclinarse sobre un avispero, examinar el trabajo de los insectos amarillos y negros y luego, con cuidado con los guantes puestos y el sombrero hundido hasta las orejas coger el avispero, envolverlo en un paño y llevárselo a su casa. Sabían por qué hacía aquello. Por la noche discutiría con su vecino Heinrich Völlter, que molía trapos para luego fabricar papel con la pasta. Trataría de convencerlo de la necesidad de averiguar cómo exactamente podían las avispas hacer un trabajo tan fino que incluso el mejor papel que producía Völlter no era comparable con él.
Keller conocía muy bien las dificultades a que se enfrentaban entonces a mediados del siglo pasado los fabricantes de papel. No había bastantes trapos para la fabricación. La gente leía más que antes, los periódicos ya no salían una vez a la semana, sino todos los días, y los trapos eran cada vez más escasos. En los periódicos aparecían anuncios en los cuales los fabricantes de papel se dirigían a las "distinguidas y encantadoras señoritas, que quieran leer lindos libritos, aprender gramática o aumentar todavía más su belleza con algún adorno de papel", y les pedían que no tirasen el menor pedacito de tela que no les sirviera, sino que lo vendieran al trapero.
Keller sólo trataba de penetrar el secreto del avispero, pero en vano. La química de mediados del siglo pasado todavía no estaba bastante adelantada para ayudarlo, y además los conocimientos del tejedor eran más escasos que su curiosidad. Pero Gottlob no se rendía. Siguió andando por campos y bosques y siguió buscando la manera de penetrar algunos de los secretos de la naturaleza.

Figura 2. Aparato para la fabricación de papel del año 1734.
Un atardecer, llegó al canal del molino. Alrededor de la rueda del molino se apiñaba una multitud de niños. Sacaban de bolsitas de tela huesos de cereza, los colocaban contra la rueda para tratar de horadarlos. Cuando lograban hacerlo, ensartaban los huesos en un hilo y obtenían un bonito collar. Para no desollarse los dedos, uno de los muchachos sujetaba el hueso en una hendidura hecha en un palo y lo acercaba así a la rueda en movimiento del molino. Keller contempló largo tiempo la fabricación de collares de huesos de cereza. Le gustaban la habilidad y el espíritu inventivo del muchacho. Advirtió también que se formaba, sobre el agua alrededor de la rueda del molino, una gruesa capa de aserrín de huesos y de los palos con que los sostenían. El tejedor se inclinó sobre la superficie del agua, recogió con la mano un poco de aserrín mezclado con el agua y lo examinó con detenimiento. Luego echó a correr hasta la fonda "El Toro Negro", donde charlaba todos los días con su vecino Völlter mientras bebían un tarro de cerveza.
Aquel día no podía esperar, miraba constantemente a la puerta, en busca del fabricante de papel de Heinrichen. Cuando al fin llegó Völlter, Keller empezó a describirle su nuevo invento.
¡Ningún trapo, querido Heinrich, sino madera! ¡Madera corriente pulverizada! Con eso como materia prima vas a fabricar tu papel. Apostaría la cabeza a que las avispas hacen su nido con madera también.

Figura 3. Antiguos molinos para la fabricación de la pasta de papel.
El entusiasmo de Keller se contagió al fabricante de papel. Pocos días después empezaron los dos a examinar la nueva materia prima. En lugar de trapos machacados, como se había usado durante siglos, utilizaron madera triturada para la fabricación de papel. Y apreciaron con asombro que Keller tenía razón por lo que se refería a las avispas. Pero Heinrich Völlter era un hombre al que de veras le gustaba experimentar novedades, pero que no sabía superar los obstáculos con los cuales tropiezan todos los innovadores. Por eso, sin pensarlo más, vendió el secreto de los huesos de cereza, y también el secreto de la fabricación de papel a partir de madera, a algún comerciante por la cantidad de 1 000 marcos.
Y eso no lo pudo olvidar jamás su vecino Gottlob Keller, tejedor de profesión, que fue, gracias a su curiosidad, el auténtico inventor europeo de la fabricación del papel a partir de madera.
2. Los predecesores de Gottlob Keller
El tejedor no sabía que muchos, muchos siglos antes (exactamente 1700 años antes) se le habían adelantado los chinos. Ellos también fabricaban papel a partir de madera. Cocían líber de morera con una lejía de cenizas de madera, y conocían la calandria también. Naturalmente, no era una calandria hidráulica como las que tenemos nosotros, sino que consistía en dos tablillas de madera, entre las cuales colocaban la pasta de celulosa que había obtenido, y con la presión la privaban del exceso de humedad. Lo que no podía hacer la calandria lo hacía el Sol.

Figura 4. Fabricación del papel en China y en Japón
Así se fabricaba el papel que utilizaban los poetas chinos para escribir sus versos y los amanuenses de los emperadores para las sentencias de muerte. Aún ahora el papel se fabrica usando madera y lejía. Los moros que invadieron la Península Ibérica llevaron a Europa, además de los horrores de sus guerras, algunas cosas por las cuales les debemos estar agradecidos. Entre otras cosas, el método chino de producción de papel. Pero los europeos de aquella época no conocían el árbol que se llama morera. Aún no se sabe quién tuvo la idea de cambiar el líber de morera por un pedazo de trapo corriente.

Figura 5. En 1901 se descubrió en el Turquestán chino, en el pueblo de Lou-Lan, el más antiguo papel chino conocido hasta ahora. Fue fabricado en el siglo II de nuestra era.
Son increíbles las dificultades que encontró entonces aquella novedad, traída por los moros para echar raíces en Europa. Los europeos no le tenían confianza. Y además ¿no era mejor escribir sobre la piel curtida de animales, como se hacía desde la época de los antiguos reyes persas?

Figura 6. En los tiempos antiguos era obligación de la mujer japonesa mantener el fuego debajo de las cubas de madera en las que se cocían las ramas de morera. Los japoneses y los chinos secaban el papel sobre paredes calientes.
Es cierto que no era fácil preparar químicamente la piel. Era necesario dejarla remojar mucho tiempo en agua salada, tratarla con un extracto de corteza de roble, echarle cal, tenderla, rasparla y alisarla con conchas marinas, antes de ponerla en las mesas de la gente que sabía escribir. Pero el resultado era pergamino portador fiel y duradero de las ideas humanas. ¿Cómo podría uno atreverse a compararlo con el papel imperfecto? Y los moros añadían a su novedad pagana harina del trigo desleída en agua.
Hoy no podemos imaginar lo que hubiera pasado si nuestros antepasados no se hubieran reconciliado pronto con el descubrimiento chino, que trajeron a Europa los conquistadores árabes. Pero podemos imaginarnos lo que pasaría si un día se interrumpiese la fabricación de papel en todo el mundo.



Figuras 7,8 y 9. Izquierda y centro, almacén de madera seleccionada, en la fábrica. Derecha, madera cortada en pedacitos antes de ser tratada con lejía para obtener celulosa.



Figuras 10,11 y 12. Izquierda, por tratamiento con lejía a presión, la madera se deshace de sus impurezas, con ayuda del calor y de los productos químicos. Centro, tamiz vibrador horizontal que elimina los nudos y los restos de madera de la celulosa. Derecha, máquina de papel, en la cual se cambia la celulosa en una cinta sin fin de papel.
La fabricación del papel empieza en el monte. La madera seleccionada se carga en camiones y se transporta hasta las fábricas que la transforman. El primer paso consiste en quitar el líber de leños de un metro de largo, en cámaras especiales; luego los leños son desmenuzados con esmeril, que los ataca por debajo mientras giran. Se trata de desgarrar la madera para obtener pequeñas fibras. Pero todavía esto no llega muy lejos químicamente. En unas cámaras se rocían los leños con agua, y mientras los desmenuza el esmeril se tratan con vapor caliente, para facilitar la operación.

Figura 13. Rollo de papel liso para la imprenta.
Pero no se puede fabricar papel con las fibras conseguidas en esta forma, porque son demasiado frágiles. Hay que consolidarlas. Para eso se mezclan con celulosa legítima en grandes tinas. La celulosa, naturalmente, se prepara también a partir de madera, que se cuece, a alta presión, con una lejía bisulfítica de sodio o calcio, según la especie de papel que se quiera obtener: firme, que se utiliza por ejemplo para hacer bolsas de guardar cemento, o más fino, por ejemplo para hacer bolsitas de dulces. La mezcla de celulosa pasa luego por una máquina donde se muele, se espesa y de nuevo se diluye. Al final del aparato que ejecuta todo eso rápidamente, sin la intervención del hombre, se encuentra la máquina de papel. Es propiamente una banda sin fin sobre la cual se derrama la pasta de papel, que contiene más agua que celulosa. Hay más de 99% de agua en la mezcla diluida; por eso es necesario quitarle el agua, prensar, secar, alisar el papel con distintos aprestos como la tiza, el caolín o el yeso, y al final enrollar el papel en enormes rollos que pesan cientos de kilos. También se agrega cola al papel para escribir, a fin de que la tinta no emborrone al escribir.
3. Vestidos de explosivo
En 1889 se realizó en París una gran exposición. Los franceses querían jactarse ante todo el mundo de lo que sabían hacer. Entre los expositores se contaba cierto conde que se llamaba Chardonnet. Para divertirse hacía experimentos químicos y un día empezó a afirmar que había descubierto la seda artificial. En la sala de exposición, repleta de visitantes jóvenes y no tan jóvenes, estaba colgada, en efecto, una patente concedida el 12 de mayo de 1884, que confirmaba que el conde Hilaire Chardonnet de Besançon había descubierto "una materia sintética parecida a la seda".
Cuando le preguntaban cómo la había obtenido, contaba que durante sus estudios en París había ayudado al famoso Pasteur a averiguar la manera de curar la pebrina, enfermedad del gusano de seda que en un tiempo amenazó con aniquilar toda la industria de la seda de Francia. Fue entonces cuando tuvo oportunidad de familiarizarse con la "técnica de fabricación" usada por el insecto inestimable. Y al parecer aquello le dio la idea de imitar simplemente al gusano de seda.

Figura 14. Macho del gusano de seda.
¿Qué podía aprender el conde francés del procedimiento de la mariposa? Muchas cosas; en primer lugar, que la larva apenas sale del huevo, empieza a buscar hojas de morera. Y se alimenta de ellas, al punto de que después de 35 días de vida, mide ya 9 centímetros.

Figura 15. El gusano de seda segrega un fino filamento de una materia espesa que se solidifica en seguida. Fabrica su capullo con ésta. En dos días produce hasta 3 000 metros de fibras finas.
Luego, como si ya no tuviera hambre, empieza a ayunar y a construir esa habitación que los biólogos llaman capullo. Por el orificio de una glándula, el gusano segrega un filamento de una materia espesa que se solidifica en seguida al aire. En dos días el filamento alcanza 3 000 metros de longitud.
Chardonnet sabía más que Keller. Era químico, y además habían pasado 44 años desde el tiempo en que el tejedor sajón aseguró que la avispa construía su nido con madera. Desde aquella época la química había recorrido un camino muy largo. Chardonnet pensaba que el gusano de seda hacía su morada de celulosa. Hay celulosa en la madera, y en la hoja de morera.
¿Cómo preparar sintéticamente celulosa y, sobre todo, cómo remplazar el aparato ingenioso que tiene el gusano de seda y que emite una fibra tan fina de una materia tan espesa? Hilaire Chardonnet se acordó del químico de Basilea, de Schönbein, quien, como sabemos nosotros también, preparó una disolución de algodón pólvora en éter etílico: el colodión. Recordemos también que el colodión se solidifica rápidamente al aire.
El conde de Besançon decidió probar el colodión. Remplazó la glándula del gusano por tubitos finos de vidrio. Y sometió el algodón pólvora disuelto en éter y alcohol o sea el colodión de Schönbein a una presión de algunas atmósferas en los tubitos de vidrio. Advirtió con mucha alegría que el experimento salía bien. Las fibras brillantes que salían por las puntas de los tubitos de vidrio se podían tejer como las fibras de seda natural, fabricadas por el gusano de seda.

Figura 16. Modelo de una parte de la molécula de celulosa
Los periódicos franceses se ocuparon de la maravillosa invención y las francesas trataron de obtener seda artificial para mandarse hacer vestidos. Hilaire de Chardonnet no perdió tiempo, fundó una fábrica en su ciudad natal y no tardó en fabricar 50 kg de seda artificial al día. ¡Naturalmente, era sólo el principio! El emprendedor conde aumentaba cada día la producción de seda por la cual suspiraban tanto las francesas. Hasta que un día el gobierno francés prohibió la fabricación de seda de Chardonnet y mandó cerrar la fábrica.
¿Qué había ocurrido? Desgraciadamente, lo que debe pasar con el algodón pólvora. ¡La seda artificial de Chardonnet no era nada más que algodón pólvora! Cuando se tocaba con una plancha caliente, empezaba a arder con una bella llama clara. Ni siquiera el agua le gustaba a la nueva tela de moda. En cuanto empezaba a llover sobre los vestidos hechos con la seda de Chardonnet, aparecían manchas sobre ellos, las bellas parisienses tomaban un raro aspecto y para remate la seda empezaba a hincharse.
Una seda que no soportaba ni una plancha caliente ni un poco de lluvia no servía para nada. El conde de Besançon quedó extraordinariamente desilusionado. Lo mismo les pasó a las francesas, que dejaron de manifestar interés hacia la seda fabricada en Besançon.
Pero un día el químico se enteró de que vivía en Inglaterra cierto electricista que al parecer había logrado fabricar una fibra artificial que no ardía cuando se ponía en contacto con una plancha caliente. Además, lo interesante de la noticia era que aquel hombre, que se llamaba J. W. Swan, no buscaba la seda artificial en sí. Se trataba para él de algo completamente diferente: quería obtener un filamento que brillara en las bombillas eléctricas más que los utilizados hasta entonces.

Figura 17.
Chardonnet no vaciló un momento. Se dispuso a viajar a Inglaterra y se quedó estupefacto.
Averiguó que en realidad el electricista inglés utilizaba también una especie de colodión para fabricar su nueva fibra, pero no usaba como disolvente ni éter ni alcohol, sino ácido acético. Se encontraron los dos inventores frente a frente: Swan, profundamente desilusionado porque la fibra que había descubierto no convenía en la bombilla; Chardonnet, contentísimo porque la fibra de Swan convenía perfectamente para fabricar seda artificial.
- ¿Patentará su invención? preguntó el francés.
- No; por lo menos no en Francia fue la respuesta lacónica del inglés.
- Entonces ¿puedo fabricar seda artificial según su invento?
- Le deseo muy buena suerte en su empresa sonrió el inglés.
Hilaire Chardonnet regresó rápidamente a Francia y pidió al gobierno que le dejara abrir de nuevo su fábrica. Después de algunas pruebas, cuando los funcionarios de sombreros altos y cordones dorados se convencieron de que la nueva fibra no se encendía al contacto de la plancha caliente, el conde de Besançon recibió autorización para fabricar otra vez seda artificial.
Pero con esto no se terminan las aventuras de la fibra artificial. Los químicos no dejaron de buscar maneras de fabricarla de mejor calidad, a precio más bajo y más pronto.
Antes de hablar de uno de los métodos utilizados hoy para fabricar la fibra artificial, debemos saber lo que es exactamente la celulosa desde el punto de vista químico.
4. Juego de construcciones inagotable
Encontramos celulosa en la madera, en las raíces y tallos, en las hojas, la paja, las cañas, la ortiga irritante o la planta tintórca: en todos los vegetales. El químico que recurre a las riquezas del reino vegetal para fabricar la fibra, en el verdadero sentido de la palabra no crea en realidad nada artificial.




Figuras 18, 19, 20 y 21. La fabricación de fibras sintéticas empieza en el sexto piso. En cuanto termina una parte del proceso de fabricación, el material cae automáticamente al piso inferior. Es necesario tratar en primer lugar la celulosa con una lejía, separar luego la lejía y por último laminar la celulosa. Al agregar sulfuro de carbono al producto laminado se forma en los tanques rotatorios un bello polvo anaranjado, al xantogenato.
No hace más que disponer las cadenas de átomos de carbono, hidrógeno y oxígeno, que constituyen la celulosa, de una manera un poco diferente que la que usa la naturaleza en el pino, el abeto, la ortiga o las hojas. No hace más que poner en orden las piedras del magnífico e inagotable juego de construcciones de la naturaleza viva. En pocas palabras, da otra forma a las creaciones de la naturaleza. Para lograrlo debe tratar químicamente lo que creó la naturaleza. ¿Por qué? Para conseguir celulosa pura. Por ejemplo, la madera sólo contiene cincuenta por ciento de celulosa; el cincuenta por ciento restante se compone de otras materias como lignina, azúcares, resinas. Por eso es necesario eliminar tales impurezas indeseables durante la fabricación de las fibras sintéticas, mientras conservamos la celulosa.
¿Qué hacer?
Debemos someter estas "impurezas" a alguna sustancia química capaz de disolverlas. Se cuece la madera, en la fábrica de papel, con una lejía que contiene cal y anhídrido sulfuroso. Estos dos verdaderos policías extraen despiadadamente todo lo que no tiene cabida en la sociedad de la celulosa pura. Y las calandrias se ocupan de eliminar el exceso de agua que queda en la celulosa. Pero todo esto no basta todavía. Tenemos aún que recurrir al sulfuro de carbono, que transforma la celulosa en una materia anaranjada que se llama xantogenato.

Figura 22. Durante la fabricación de las fibras sintéticas, la temperatura se regula y registra automáticamente.
Si examinásemos la celulosa con un buen microscopio, no quedaríamos satisfechos todavía. La materia obtenida es demasiado espesa, y así no nos queda más que buscar la ayuda de dos ayudantes indispensables de la química: el filtro y el agua. Sólo cuando hay en la disolución, a la cual agregamos hidróxido de sodio, un máximo de 8% de celulosa, podemos tratar de hilar unas fibras que pueden servir para tejer vestidos o medias.
Los tubitos de vidrio de Chardonnet, por los cuales el químico de Besançon comprimió el colodión, se encuentran seguramente en algún museo de Francia. Los remplazaron toberas finas de platino. Se escogió este metal porque los ácidos no tienen efecto sobre él. Las toberas tienen 25 mm de diámetro y cada una llega a tener hasta 3 000 orificios.

Figura 23. El xantogenato todavía no es un producto final. Hay que disolverlo en una lejía de sosa, ablandarlo y convertirlo en un líquido espeso, como miel: la viscosa. En este momento se alcanza al gusano de seda antes de empezar a fabricar su capullo.
El diámetro de éstos, apenas distinguibles a simple vista, es de sólo algunas centésimas de milímetro. Y esta tobera perforada es lo que sustituye a las glándulas del gusano de seda. De esta tobera salen miles de delgadísimos chorros de celulosa diluida que caen en un baño, donde espera una disolución sulfúrica para terminar el trabajo. Allí todo lo que había transformado la celulosa en líquido, o sea lo que la había disuelto, pierde su eficacia. Los disolventes ya no tienen efecto sobre la celulosa. Es el famoso momento en que nace la fibra sintética.
Sigamos comparando el gusano de seda con la tobera: el gusano segrega por el agujerito que lleva su glándula hilos muy finos de una materia espesa, que se solidifican en seguida al aire. La celulosa diluida que sale en finos chorros de las toberas de platino no se solidifica al aire. Es necesario que entre en un baño para que forme una hebra con las propiedades que normalmente tiene la fibra segregada por el gusano de seda y que no es de celulosa, por lo demás.

Figura 24. Se remplaza la glándula del gusano por una simple tobera de platino. Por los orificios muy finos sale la viscosa, que se solidifica en un baño y se convierte en fibra.
Ahora examinemos la fibra salida del orificio menudo de la tobera y que pasó al baño ácido; comparémosla con la fibra de lana de oveja. Lo mejor será mirar otra vez por el microscopio.
Como ven hay diferencia entre las dos fibras. La fibra sintética tiene superficie lisa; por el contrario, la lana tiene la superficie escamosa y su fibra es ondulada. Y precisamente en eso está el secreto de por qué es caliente la ropa de lana.

Figura 25. Fibra sintética y fibra de lana de oveja aumentadas muchas veces.
La lana en sí no da calor, pero el ondulado que no la abandona ni siquiera después de transformar la lana en tela para hacer la ropa, hace que quede aire entre las fibras. Ya sabemos que es mal conductor del calor. Esta envoltura de aire que rodea al cuerpo humano no deja que penetre el aire frío hasta la piel. Pero no tiene esta propiedad la fibra que vimos salir del baño sulfúrico hace un momento.
El químico sería un mal químico si no tratara hasta en esto de imitar la naturaleza si no tratara de ondular la fibra sintética e imprimirle la propiedad que tiene la fibra de la lana de oveja. Como sabe mover los átomos que componen la materia química, e incluso agregar átomos, el químico moderno ha descubierto una solución que permite a la fibra quedar para siempre ondulada. Así la fibra sintética recibió la propiedad que tiene la lana. Precisamente por eso la fibra sintética tratada en esta forma llega a costar muy cara.
Así, la química puede fabricar a partir de la madera no sólo seda artificial, algodón artificial, sino también lana sintética. En lugar del costoso ganado lanar, proporciona a la gente una materia prima más barata para vestirse: la madera.
5. Sombrero de requesón
Consideremos un momento el hecho de que la lana ovejuna sea, en su mayor proporción, una proteína (como lo es la seda natural). Retrocedamos al principio de este siglo, cuando a los químicos les preocupaba la composición de la lana y trataban de extraer proteínas de la naturaleza para fabricar fibras de lana sintética.

Figura 26.
Esta vez pidieron ayuda a la vaca. Es posible sacar la proteína el requesón de la leche, pues cuando se echa cuajo a la leche descremada, se corta y se obtiene una pasta parecida a la viscosa con que se hace la seda artificial. Después de cierta preparación, fue posible hacerla pasar por los orificios muy finos de las toberas, lavarla en un baño apropiado, y así nació otra especie de fibra sintética, el lanital. Era posible hacer muchas cosas con esta nueva fibra sintética, pero no era tan sólida como la fibra de la oveja y por eso, se fabrican sobre todo sombreros con el lanital.
Antes de la segunda guerra mundial, se lanzaron a fabricar esta fibra de requesón, ante todo, los países que producían mucha leche, como Holanda, Francia y Dinamarca. Hoy han abandonado el proceso por ser antieconómico. Pues de 100 litros de leche se pueden sacar menos de 3 kilogramos de materia proteínica o caseína. Y de un kilogramo de caseína se saca un kilogramo de lanital.
El químico moderno no se contentó ni con la fibra de celulosa ni con la fibra de caseína. No dejó, ni deja, de buscar una nueva materia prima accesible en cantidad suficiente, no cara y con la que se puedan fabricar fibras sintéticas mejores que las conocidas. A fin de cuentas se volvió al modesto pedazo de hulla, que ya había ayudado tantas veces, y tan asombrosamente, a los químicos.
Pero antes de contar cómo lograron fabricar la más maravillosa de las fibras que había conocido el mundo, contaremos lo que pasó el día 7 de diciembre de 1941 en una de las islas del océano Pacífico.
6. Bombas sobre Oahu
A miles de kilómetros al este de la tierra del Sol Naciente, como llaman los poetas a Japón, se encuentra el archipiélago de Hawai. Allí está la isla de Oahu con sus palmeras y sus maravillosas playas arenosas. En diciembre de 1941 estaba reunida la armada estadounidense en el puerto de Pearl Harbor, en esta isla. Estaba allí tranquilamente en las aguas del océano Pacífico, esperando. En Europa ardía la guerra, pero allí todo era calmo.
¿Qué estaban haciendo los japoneses? Sus parlamentarios estaban precisamente en Washington, hablando de la paz que era necesario mantener entre Japón y los Estados Unidos de América. De seguro no pasaría nada, por lo menos mientras estuviera la delegación japonesa negociando en la Casa Blanca.
Es el día 7 de diciembre de 1941. El velo de la noche se levanta lentamente sobre el mar tranquilo. Está amaneciendo. El día anterior, sábado por la tarde, los marineros lanzaron al agua botes que se dirigieron, uno tras otro, llenos de oficiales, hacia la playa. Los estadounidenses, con sus uniformes blancos, se apresuraban a un baile. Quedaron en los buques sólo los centinelas y algunos oficiales.
Son las tres y doce minutos del día 7 de diciembre de 1941. El teniente que estaba sentado junto al radar del West Virginia bostezó. De repente clavó los ojos en la pantalla del radar. En la superficie vacía aparecieron unos puntos que se acercaban rápidamente. El teniente John Mulloy cogió el teléfono y llamó a la cabina del primer oficial.
Silencio. Nadie contestaba.

Figura 27. Pearl Harbor, a 7 de diciembre de 1941. Edición especial del periódico "Honolulu Star-Bulletin": ¡Guerra! Aviones japoneses bombardean Oahu.
El teniente colgó el teléfono y subió corriendo a la cubierta; de lejos se oía el zumbido regular de aviones que se acercan. Algunos marineros, acodados en la barandilla, miraban el cielo, del que desaparecían las últimas estrellas.
Aparecieron los tres primeros aviones sobre el puerto.
Ya están encima de nosotros. ¿Son nuestros? ¿Adónde van? John Mulloy miraba fijamente el cielo. En aquel momento vio a los tres aviones bajar rápidamente, como por un cable invisible, hacia los barcos estadounidenses inmóviles.
John Mulloy oyó un silbido cortante que le heló hasta la médula, y luego sólo un terrible golpe abrumador. Como si el mismo infierno se hubiera abierto.
El teniente de la armada estadounidense John Mulloy, de Nebraska, cayó sobre el suelo de acero de uno de los más grandes acorazados estadounidenses. Estaba muerto.
El lunes 8 de diciembre de 1941, a las 11 de la mañana, el embajador de Japón declaró la guerra a los Estados Unidos de América, y en el mismo momento el cuartel general de la armada japonesa anunció que el día anterior los aviones, despegados de portaaviones, habían logrado hundir en Pearl Harbor, ocho buques estadounidenses de combate, tres cruceros y destruir 188 aviones.
Ésta fue la más considerable de las pérdidas que había sufrido la marina de guerra de los Estados Unidos de América en toda su historia.
7. Reunión secreta
Dos días después del acontecimiento de Pearl Harbor, a las 9:30 sonó el teléfono en el despacho del director de una de las más grandes fábricas estadounidenses de fibras sintéticas.
- Lo llama el cuartel general dijo la secretaria, y le pasó la comunicación.
- ¿Nos puede decir dentro de cuánto tiempo lograrán remplazar la importación de seda japonesa? preguntó la voz desde el otro extremo del hilo. Silencio.
- ¿Me entendió?
- No le puedo contestar a esta pregunta en seguida. Hace poco que empezamos a fabricar las nuevas especies de fibras. Pero haremos todo lo posible.
El director quedó callado un momento.
- Mañana le mandamos tres de nuestros oficiales. Le estaríamos muy agradecidos si les diera, de ser posible, una respuesta precisa. Gracias.
El teléfono enmudeció. El director colgó el auricular, llamó a la secretaria y le pidió que reuniera en media hora el consejo técnico y algunos ingenieros que trabajaban en los laboratorios.
Para que entendamos lo que hablaron, el día 10 de diciembre de 1941, los químicos convocados a toda prisa por el director de la fábrica de fibras sintéticas, debemos saber primero lo que son las materias que llamamos plásticas.
8. Brujerías con moléculas
Sabemos que todas las sustancias químicas constan de pequeñas partículas, que se llaman moléculas. Éstas, a su vez, se componen de partículas todavía más pequeñas, que se llaman átomos. Por lo pronto nos interesan sólo las partículas más grandes, las moléculas.

Figura 28. Moléculas en disolución: de bajo peso molecular (disolución de azúcar) de alto peso molecular (cola) moléculas tridimensionales.
Si disolviéramos un terrón de azúcar en un poco de agua, y la disolución la aumentáramos y la fotografiáramos con ayuda de un microscopio más potente que los que tenemos hasta ahora, veríamos un gran número de pequeñas partículas de azúcar, que son las moléculas. Todas son como enanitos que no encuentran la menor dificultad para moverse en el agua. Si calientan ustedes la solución de azúcar, las moléculas empiezan a separarse sin la menor dificultad, precisamente porque la atracción entre ellas es muy débil. Llamamos materias de bajo peso molecular a aquellas que, como el azúcar, se componen de moléculas que se separan fácilmente. No tienen por qué ser sólo materias sólidas, como nuestro pedacito de azúcar; pueden ser también líquidos, como por ejemplo múltiples ácidos o alcoholes. Y ahora tomemos otra sustancia, por ejemplo la cola del carpintero. Añadámosle agua. ¿Se comporta exactamente como el azúcar? De ninguna manera.
Fotografiemos la cola con la ayuda del microscopio. Vemos algo completamente diferente de la disolución de azúcar. En lugar de las pequeñas moléculas redondas, aparecen largas cadenas que se entrelazan y que no se quieren separar a ningún precio.

Figura 29. Los primeros paracaídas eran de seda natural, casi siempre procedente de Japón, cuya calidad se consideraba la mejor en los mercados del mundo entero.
Se quedan bien trabadas unas a otras. Dijimos que estas moléculas son largas. Naturalmente son largas en relación con el mundo de las moléculas. En él una milésima de milímetro es una medida considerable. Las moléculas de azúcar son mil veces más pequeñas en comparación con aquéllas. Llamamos sustancias de alto peso molecular a las que, como la cola, se componen de estas grandes moléculas. Recordemos muy especialmente estas materias cuyas moléculas son cadenas que no se pueden romper tan sencillamente. Imagínense que el químico pueda reforzar esta sólida cadena molecular todavía más; con muy diversas reacciones químicas, logra tender, entre las cadenas de grandes moléculas, muchos puentecillos constituidos por otras moléculas grandes. Así se generan moléculas tridimensionales. Ya desde el principio de este siglo, los químicos se habían fijado en las propiedades excepcionales de estas materias: son insolubles en el agua, se derriten paulatinamente cuando se calientan. Lo más importante era que podían obtener materias de alto peso molecular a partir de sustancias de bajo peso molecular. Y precisamente en esta transformación de las materias de bajo peso molecular en las de alto peso molecular, reside todo el secreto de que iba a hablar, el día 10 de diciembre de 1941, tras de las puertas cuidadosamente cerradas, el consejo técnico de la fábrica de fibras sintéticas. Se trataba de saber cómo fabricar, y lo más pronto posible, la mayor cantidad de fibras sintéticas que se pudiera, no a partir de madera (que es también en buena parte una materia de alto peso molecular), sino de otras materias. ¿Por qué? Los japoneses eran para los Estados Unidos de América, hasta la declaración de guerra en el océano Pacífico, los primeros proveedores de seda natural, que se utilizaba para fabricar no sólo ropa sino también paracaídas para el ejército. Hasta que estalló la segunda Guerra mundial, Japón respondía del 80 por ciento de la producción mundial de seda bruta. Y en 1941, después del asalto a la armada estadounidense en Pearl Harbor, las reservas de seda japonesa de Estados Unidos de América eran muy pequeñas. Tal vez se pregunte por qué no les bastaban a los estadounidenses, para la fabricación de paracaídas militares, las fibras sintéticas fabricadas a partir de madera y de otras materias que contienen celulosa. La razón es que no son bastante sólidas.
9. El hombre paciente de Wilmington
Ya a principios de este siglo algunos químicos descubrieron que era posible fabricar fibras sintéticas a partir de compuestos obtenidos por destilación seca de la hulla. Sin embargo, ninguno de ellos creyó que este descubrimiento tuviera más valor que cualquier dato químico que se puede alcanzar en un laboratorio, pero que no puede ser punto de partida de una fabricación industrial. Los documentos que describían este descubrimiento quedaron unos 30 años en las bibliotecas empolvadas y en los cajones de las mesas de trabajo. Hasta que un día cierto joven decidió examinar a fondo las posibilidades de fabricar fibras sintéticas partiendo del alquitrán de hulla. Se llamaba Wallace Carothers. Tenía 32 años entonces, en el año 1928. Este químico trataba de convertir alguna sustancia de bajo peso molecular en materia de alto peso molecular. Se sabe que se puso a experimentar con doscientas clases distintas de sustancias, hasta que al final tuvo éxito, después de años de vanos esfuerzos.
Una vez calentó una mezcla de ácido adípico y hexametilendiamina a una temperatura de 300° C. Se pueden preparar estos dos compuestos a partir del benceno que, como vimos en el primer capítulo de este libro, se forma en la destilación seca de la hulla. Carothers calentó su mezcla, pero excluyendo la entrada del aire. Para ello llenó de nitrógeno los aparatos de vidrio que utilizó para su experimento. Calentó la mezcla durante varias horas hasta que se fundió todo el contenido de los aparatos. Luego destiló el agua formada durante la fusión, y en el fondo de los aparatos quedó una materia lechosa turbia. Carothers la examinó con mucho cuidado, le metió un alambre y tiró: la materia se alargaba, y mientras más adelgazaba, más firme se hacía.
Esto era notable, pero lo más extraordinario era que la fibra delgada se solidificaba al aire sin ningún baño especial. Hasta entonces, como lo vimos, pocos habían logrado fabricar una fibra sintética sin baño final.
El joven químico estaba sorprendido: la fibra delgada, en lugar de romperse, era tan tenaz como un alambre de acero. Carothers era un químico extraordinariamente inteligente, con capacidades asombrosas, y sobre todo un hombre de una paciencia poco común y de fuerte voluntad. Repitió el experimento. El resultado fue el mismo. No había dudas. El joven había descubierto una nueva sustancia que se podía utilizar para la fabricación de fibras sintéticas como nadie en el mundo las había fabricado hasta entonces. Carothers subrayó la fecha 28 de febrero de 1935 en su calendario, y acuñó la expresión "polímero 66", porque en las dos sustancias químicas que se unen en la nueva fibra ácido adípico y hexametilendiamina hay seis átomos de carbono por molécula. Sólo después de algún tiempo recibió esta fibra el nombre de nylon. Se cuenta una historieta acerca de esto. No sé si es verdadera. La cuento sólo porque es curiosa.
Dicen que un día llamó a Carothers el director de la fábrica donde trabajaba el joven inventor, y le dijo claramente que no le gustaba el nombre del polímero 66.
- Eso no quiere decir nada; necesitamos algo que suene bien, un nombre que la gente pueda recordar fácilmente dijo el director.
Carothers pensó un momento.
- Aquí lo tiene: nylon.
- ¿Qué es eso, oiga? ¿Cómo se le ocurrió eso? preguntó el director, sorprendido.
Carothers sonrió:
- Son las iniciales de las palabras de la frase: Now you lousy old Niponese.
El director se sonrió y aceptó el nuevo nombre de la fibra. Según parece, es así como la palabra nylon, mundialmente conocida, remplazó a polímero 66. Por lo menos es lo que se dice. A lo mejor es cierto que buscaron simplemente un nombre fácil de recordar y que sonara bien.
Pero ya habían pasado algunos años desde el momento que se empezó a fabricar la nueva fibra industrialmente. Y no fue nada sencillo fabricarla. Fue necesario superar muchas dificultades técnicas, y así no aparecieron primero en el mercado medias o ropa hechas con esta fibra sintética, sino cepillos de dientes. Sólo las bombas soltadas por los aviones que llevaban sobre sus alas los símbolos del Sol Naciente, el día 7 de diciembre de 1941, sobre la armada estadounidense que dormitaba en las aguas de la isla de Oahu, ayudaron a vencer todos los obstáculos. El nylon se empezó a fabricar en grandes cantidades y para propósitos que nadie hubiera ni siquiera soñado en la época que Wallace Carothers vio por primera vez la materia lechosa y turbia, en su laboratorio.

Figura 30. Corte longitudinal de fibras sintéticas: viscosa y silón.
Esta fibra de materia plástica, producto del carbón negro corriente, de la paciencia poco común y de la curiosidad del químico, es hoy parte indispensable de nuestra vida cotidiana.
Se fabrican con ella no sólo cepillos de dientes, redes de pescar, paracaídas militares, vestidos, medias, hilos que usa el cirujano para coser heridas, batas de trabajo, máscaras, ropa interior, sino también cuerdas para las raquetas de tenis.
El nylon es pariente del silón checoslovaco, del perlón alemán, del caprón soviético, del mirlón suizo, del estelón polaco, del celón inglés. ¿Preguntan ustedes por qué? Pues porque se equivocó Wallace Carothers durante uno de sus experimentos.
10. El error que costó millones
Ya dijimos que Wallace Carothers era muy concienzudo y extraordinariamente preciso, y que trataba de investigar todo compuesto que acaso pudiera cambiarse en materia de alto peso molecular para la fabricación de fibras sintéticas. La empresa estadounidense Du Pont, donde trabajaba Carothers, hacía patentar en seguida todos los inventos de éste y vendía bien caro a otras fábricas los derechos de patente por el método de producción que había inventado Carothers.
Dicen que incluso el maestro carpintero se da un martillazo a veces. De la misma manera se puede equivocar también un maestro en química. Carothers, eminente químico, se equivocó terriblemente. Veamos cómo.
La lactama es uno de los productos derivados del alquitrán de hulla. Carothers trató también de fabricar fibras a partir de este compuesto, como lo hizo con decenas de otras sustancias. (Recuérdese además que este químico trataba de transformar materias de bajo peso molecular en materias de alto peso molecular.) Pero no le salió bien el experimento con la lactama. Por eso escribió en uno de sus trabajos que no se puede fabricar fibra sintética a partir de la lactama. Y una sola frase ("La lactama no se polimeriza en la reacción que forma normalmente las poliamidas, ya se utilicen o no catalizadores durante la operación") costó una fortuna a la empresa de Carothers. Tal vez la frase en cuestión parezca incomprensible. En resumen quiere decir: "Hagas lo que hagas, si quieres convertir la lactama en materia de alto peso molecular, aunque pidas ayuda a alguna otra materia, o catalizar, que facilita la reacción química, no conseguirás nada".
Los químicos de todo el mundo leyeron esta frase de Carothers, y la entendieron muy bien. Fue un verdadero reto. Como un caballero de la Edad Media, el químico moderno había desafiado a sus rivales, los demás químicos. Y éstos le hicieron frente. Uno de ellos, el alemán Paul Schlach, consiguió en 1937 lo que no pudo conseguir Wallace Carothers: convertir la lactama en una materia muy parecida a la que utilizó el químico estadounidense para fabricar su fibra de nylon. Una grieta peligrosa que había abierto en la muralla de los derechos de patente de la empresa Du Pont, para la que trabajaba Carothers. Los alemanes, y luego todo los demás empezaron a fabricar fibras artificiales a partir de la lactama según el método de Schlach, y no siguiendo los métodos patentados por Carothers. Sólo después de algún tiempo el mundo supo con asombro que Carothers había escrito aquella frase infeliz, porque el compuesto que había utilizado para preparar su lactama, el ácido aminocaproico, no estaba bastante puro.
11. ¿Casualidad o plan preciso?
Planteemos todavía otra cuestión: ¿Carothers descubrió por casualidad el secreto del nylon, como, por ejemplo, el tejedor sajón Keller había descubierto la fabricación de papel a partir de madera? De ningún modo. Wallace Carothers persiguió su meta inexorablemente, metódicamente, según un plan preciso de investigación, y poseía grandes conocimientos químicos. Sabía muy bien cómo cambiar las materias de bajo peso molecular en materias de alto peso molecular. Sabía que el hecho de hilar el producto que quedaba en la vasija de reacción, convirtiéndolo en hilitos delgados, imponía cierto orden a las moléculas del hilo: ya no podían éstas ponerse donde se les antojara, sino que se volvían soldados disciplinados bien formados uno al lado del otro, uno junto al otro, firmemente unidos. Allí está precisamente el secreto de la flexibilidad y solidez de la fibra de nylon: en la cohesión asombrosa de las moléculas.
Aprendamos además esto: llamamos policondensación a una reacción como la que se realiza en la fabricación del nylon entre el ácido adípico y la hexametilendiamina. Es una transformación de materias de bajo peso molecular en sustancias de alto peso molecular, durante la cual se elimina algo (en nuestro caso, agua). Si no queda nada que eliminar en tal trasformación (y esto pasa en el caso de muchas reacciones químicas), se trata entonces de lo que se llama polimeración. Y ahora, la última sorpresa. Hay que saber que lo que pasa en la vasija de reacción en el laboratorio, pasa también en el cuerpo humano. En éste las proteínas se forman de la misma manera. Hay quien dice incluso que los químicos imitaron precisamente la condensación y polimerización del cuerpo humano. Pero no hay que creerles.
12. Tobera en lugar de alambre
Recordemos que cuando Carothers descubrió una materia lechosa y turbia en el fondo del recipiente de vidrio, metió en ella un alambre y tiró, para que se formara una hebra muy fina. Ahora se procede de un modo algo distinto durante la fabricación del nylon. Al salir directamente del recipiente de reacción, el polímero que así se llama el producto final de alto peso molecular es sometido a una presión de nitrógeno para expulsarlo por toberas con orificios muy pequeños. La fibra que se forma, por solidificación al aire, se enrolla en seguida en un tambor rotatorio, y precisamente al enrollarse rápidamente y estirarse adquiere solidez y elasticidad considerables.
La fibra de nylon es muy brillante y ligera, y se rompe sólo al ser sometida a una tracción de 51 kg por milímetro cuadrado.
Tiene otra propiedad, y es una propiedad inestimable de que carecen la lana y la seda: no arde. Sólo a 250°C se funde. Otra cosa más: las polillas que atormentaron tanto a nuestras madres o mejor dicho, a sus vestidos de lana guardados en el armario ni se fijan siquiera en los vestidos de nylon. El inventor del nylon, Wallace Carothers, no esperó el auge del nylon que conoce actualmente el mundo. Murió trágicamente dos años después de haber visto por primera vez, en su laboratorio de Wilmington, el hilito de la nueva materia sintética. Tenía 41 años.
13. Del ámbar al PVC
En las orillas del mar Báltico, desde hace muchos siglos, los pescadores esperan que el mar arroje de sus entrañas trozos de una materia de color amarillo miel. Ya en tiempos remotos, cuando los encontraban en sus redes los recogían y luego, en casa, a la luz de las teas, fabricaban con aquellos maravillosos dones del mar collares, prendedores y broches, para adornar los vestidos de bellas mujeres. Ninguno de los pescadores sabía de esta materia amarillenta más que el nombre: ámbar. No sabían que estaban trabajando y puliendo con sus manos la resina de árboles muertos muchos miles de años atrás y que había atravesado incontables modificaciones químicas durante tan largo tiempo.

Figura 31
Precisamente el ámbar, materia amarillo miel, es el producto de estas transformaciones.
Dios sabe desde cuándo conoce el hombre las resinas naturales y desde cuándo las utiliza. Se conservan documentos de los antiguos fenicios, que utilizaban la resina de los pinos para tapar las rendijas calafatear de los barcos en que navegaban lejos, hasta el norte de Europa. Resinas de plantas muy diversas se han usado en muchos lugares del mundo. El incienso y la mirra son resinas. En el Asia sur oriental se emplean desde tiempo inmemorial resinas de muy variados árboles para hacer teas y alumbrarse. El copal de México es una resina fósil, que luego de permanecer enterrada durante milenios se desenterraba y quemaba con fines rituales. Aun ahora se utilizan grandes cantidades de resinas naturales en la fabricación de barnices. Una fuente valiosa de resina la constituye el árbol llamado kauri, que crece en Nueva Zelanda. Así, el hombre conoce las resinas naturales desde hace mucho tiempo, pero no supo arrancarles grandes secretos durante esos largos siglos. Ya en el pasado siglo los químicos lograron no sólo utilizar mejor que sus antepasados las resinas naturales, sino que consiguieron crear resinas sintéticas que superan a las resinas naturales en muchas, pero muchas, de sus propiedades. Se trata de las materias plásticas.
14. El hombre que no sabía química
A John Hyatt le gustaban las matemáticas; estudió mucho, pero como su padre, que era herrero, no tenía bastante dinero para que el muchacho terminara sus estudios, tuvo que ponerse a trabajar a los dieciséis años. Escogió la tipografía y pasó de una imprenta a otra, no se quedaba mucho tiempo en ninguna parte, y al final se empezó a ocupar de todo menos de la caja de imprenta de donde se sacan las letras para formar palabras. El adolescente inventó un aparato para afilar cuchillos y en seguida lo patentó. Y el día que leyó en el periódico que la más grande fábrica estadounidense de bolas de billar prometía una recompensa de 10 000 dólares a la persona que pudiera fabricar bolas de algo que no fuera marfil, se dijo que tenía que ganar aquellos 10 000 dólares. Pero ¿cómo? Por el momento no tenía la menor idea. Hyatt no había estudiado química, no conocía ni una sola fórmula química, ni cómo convertir cuerpos compuestos de bajo peso molecular en materias de alto peso molecular, acaso ni oyó nunca hablar de esto hasta el fin de su vida. Por otra parte, si hubiera tenido alguna noción de química, a lo mejor no hubiéramos sabido nunca de él. Este hombre que quería ganar la recompensa a cualquier precio, empezó a mezclar y calentar todo tipo de materiales. Mezcló aserrín de madera con cola y con la materia que obtuvo trató de fabricar piezas de ajedrez; cuando vio que aquello no servía, mezcló pedacitos de papel con laca y agregó a esto el famoso colodión, que había mostrado a Alfred Nóbel el camino hacia la fabricación de la dinamita. Todo fue en vano. No aparecía la materia que debía remplazar al marfil.
Un día el tipógrafo de dieciocho años se propuso hacer experimentos con nitrocelulosa. Sin pensarlo más, agregó a este explosivo un poco de alcanfor y alcohol. Aquí está la mejor prueba de que Hyatt no entendía ni una jota de química: empezó a calentar la disolución altamente explosiva y además la sometió a presión. Hasta hoy nadie puede entender cómo aquel hombre atrevido no voló al realizar el experimento. Pero, la experiencia durante la cual Hyatt se expuso tanto, se hizo histórica. Es que el tipógrafo de Alabama descubrió así la primera materia plástica, el celuloide. La materia transparente que apareció, aquel día de 1865, en el fondo del recipiente ante la mirada estupefacta de Hyatt, empezó a solidificarse y acabó por ponerse completamente dura. Cuando Hyatt la calentó de nuevo, se fundió. Se le ocurrió vaciar la mezcla caliente en moldes de metal. En poco tiempo la materia se solidificó en el molde, y cuando la sacó, se encontró con vaciados perfectos.
John Hyatt tenía un hermano que se llamaba Isaías, y los dos fundaron la primera fábrica de celuloide del mundo, en el año 1870, en Nueva York. El nuevo producto se vendió bien, pues era posible fabricar con él muñecas como no habían visto las niñas hasta entonces, películas y también gafas para el Sol. Sólo las bolas de billar fueron lo que no pudo fabricar nadie con la nueva materia, y así John Hyatt no pudo ganar los 10 000 dólares.
Pero, y aquí debemos regresar a las sustancias que dieron origen al celuloide. La nitrocelulosa, diablillo bullicioso, siguió viviendo en el celuloide y hacía que la primera materia plástica del mundo se encendiera con grandísima facilidad, y hasta estallara. Los químicos trataron de obtener un celuloide que no tuviera estas malas propiedades. Con el tiempo lograron producir un éter acético que se fundaba en la misma materia prima que la nitrocelulosa: la celulosa, pero sometida a los efectos del ácido acético. Naturalmente este celuloide tampoco era ininflamable en el verdadero sentido de la palabra. Pero se encendía sólo cuando entraba en contacto directo con el fuego, y además no estallaba. Por eso fue posible utilizarlo en gran escala, durante la primera Guerra mundial, en la construcción de aviones. La cabina del piloto era toda de celuloide. Se podían hacer incluso vestidos con él o mejor dicho, con sus fibras, que se parecían mucho a las de la seda artificial del conde francés Hilaire Chardonnet.

Figura 32. Partes de plástico del avión.
Pero volvamos un momento al inventor del celuloide, John Hyatt. ¿Por qué el tipógrafo de Alabama agregó alcanfor a la nitrocelulosa?
Durante largos siglos los antiguos chinos afirmaron que los cristales blancos del alcanfor, que obtenían por la acción de vapor de agua sobrecalentado sobre la madera del árbol alcanforero, tenían un poder milagroso. Según decían, la persona que llevaba alcanfor consigo se aseguraba el amor del ser querido, la misericordia de los dioses, y ninguna enfermedad la podía afectar. El alcanforero crecía en Formosa y los comerciantes chinos vendían su madera a un precio extraordinariamente elevado. No era posible comprar los cristales milagrosos en cualquier tienda. Se pesaban escrupulosamente sólo en las balancitas de las boticas. Fue precisamente el alcanfor una de las razones por las cuales los japoneses se abalanzaron sobre Formosa hacia fines del siglo pasado. Y cuando esta isla, cuya desgracia era que en ella creciera el magnífico Laurus camphora , el alcanforero, hasta de 12 metros de alto, cayó en 1895 entre las manos de los conquistadores japoneses de ojos rasgados, empezaron éstos a hacer negocio del alcanfor milagroso. Con el desarrollo de la industria cinematográfica aumentó la demanda de alcanfor y su precio también. Los japoneses se hicieron los proveedores exclusivos de los cristales blancos de aroma penetrante. Y fue así hasta la primera Guerra mundial, cuando el bloqueo naval dirigido por los ingleses forzó a los alemanes a fabricar alcanfor sintético.
Cuando alguien le preguntaba a John Hyatt, ya al fin de su vida, lo que preguntamos nosotros también, a saber, por qué exactamente agregó el alcanfor a la nitrocelulosa, el viejo señor encogía los hombros y contestaba: No sé.
Otra vez la casualidad de los tiempos pasados. Pero ahora los químicos saben exactamente qué papel desempeñaron los cristales milagrosos de la isla del océano Pacífico en el experimento que hizo descubrir a John Hyatt el celuloide. El alcanfor es un ablandador que mejora la calidad de la materia plástica.
Un compuesto de alto peso molecular, sacado de una planta en nuestro caso es la celulosa sacada de la madera , calentado en presencia de alcohol y otro compuesto extraído también de una planta en nuestro caso se trata del alcanfor es capaz de crear una materia plástica. Dicho de una manera más sencilla todavía: las moléculas de dos sustancias vegetales crean una materia nueva, de alto peso molecular, que es posible moldear en caliente, como vio Hyatt.
Recordemos que la primera materia plástica se fabricó porque el hombre quitó a la naturaleza las moléculas de dos materias vegetales para formar una materia de moléculas todavía más grandes. Lo ayudó también el calor que utilizó para tratar los dos compuestos. El nuevo cuerpo que se formó en caliente se solidificó al enfriarse. Pero no para siempre. Si se calienta de nuevo el celuloide, se ablanda y se le puede dar la forma que quiera uno.
Llamamos termoplásticas las materias cuya forma puede cambiar completamente en caliente, a diferencia de las materias que se endurecen cuando se las somete a una temperatura suficiente. Se haga lo que se quiera con estas últimas materias, ya no retornan al estado fundido. Llamamos termoendurecibles a este tipo de cuerpos. Por ejemplo la baquelita es una materia termoendurecible, de la cual hablaremos en cuanto terminemos con John Hyatt. No hay que asustarse por estas palabras exóticas, termoplástico y termoendurecible. Las dos comienzan con el mismo prefijo, "termo". Thermos en griego significa caliente.
El inventor de la primera materia plástica no recibió, como vimos, la recompensa para la fabricación de las bolas de billar. El celuloide no pudo remplazar al marfil. El tipógrafo estadounidense se desinteresó pronto también de la producción de celuloide, vendió sus patentes y se lanzó a nuevas invenciones. En 1891 inventó el sistema de cojinetes de bolas y parece que este nuevo descubrimiento lo llevó lejos, pero mucho más lejos, que el descubrimiento de la primera materia plástica del mundo.
15. Buscan una pizarra blanca
Dos químicos alemanes, Krische y Spittler decidieron buscar alguna materia que se pudiera utilizar para fabricar pizarras blancas para las escuelas. Hace unos sesenta años no era como hoy, que los niños en cuanto van a la escuela, escriben en seguida en cuadernos y hasta con pluma. Escribían sobre pizarras con un marquito de madera. Pero estas pizarras eran quebradizas, se rompían con facilidad. En 1897, los dos químicos alemanes se fijaron en una noticia aparecida en ciertos periódicos, como Hyatt en otro tiempo: "Pagaremos bien a la persona que descubra una materia para fabricar pizarras blancas irrompibles".
Ni siquiera preguntaron el monto de la recompensa y empezaron a pensar con qué sería mejor hacer las tales pizarras blancas. Probaron materiales, uno tras otro, pero no les servía ninguno. Cada cuerpo que experimentaban tenía alguna desventaja. Uno era demasiado pesado, sobre otro no se veían bien las letras, y el tercero se rompía entre las manos como la pizarra que debía remplazar. Y para colmo ninguno de los materiales era blanco.
Un día los dos químicos convinieron en que valdría la pena probar la caseína. Ya conocemos esta sustancia, ya que nos adelantamos a los dos químicos alemanes al hablar del sombrero de requesón. Agreguemos sólo que es un compuesto orgánico de carbono, hidrógeno, oxígeno, nitrógeno y fósforo. Y se trata precisamente de un compuesto de peso molecular tan elevado como la celulosa.
Krische y Spittler prepararon la caseína de una manera muy sencilla: agregaron cuajo a la leche descremada en aquel tiempo utilizaban como cuajo la cuarta parte del contenido del estómago de un becerro alimentado sólo con leche. La leche se cortó y los dos químicos obtuvieron una masa blanca de requesón, y suero. ¿Qué hacer con ello? Quitaron el suero y se plantearon la cuestión siguiente: ¿Qué agregar al requesón para que sea más firme? Probaron ácidos y bases. Nada. En resumidas cuentas, no salían del requesón. Hasta que un día los dos químicos decidieron agregar formol a la caseína que obtuvieron en forma de polvo blanco, después de hacer evaporar el agua.
¿Qué es el formol? Para saberlo debemos retroceder unos 50 años desde la época en que los dos químicos alemanes trataban de fabricar pizarras blancas irrompibles. Y debemos trasladarnos a Kazan, en Rusia.
16. El profesor y el carbono
A mediados del siglo pasado, el profesor Alexandr Mijailovich Butlerov enseñaba Química en la Universidad de Kazan. Tenía apenas 31 años y todo el mundo químico sabía ya de él. Este químico descubrió el formaldehído en 1859; era un nuevo compuesto. Lo encontró entre los gases que se forman durante la fabricación del coke, pero era posible obtenerlo a partir de los gases naturales que escapan de la tierra, y hoy es producido durante el tratamiento del petróleo.

Figura 33. Alexandr Mijailovich Butlerov (1828-1886).
Butlerov averiguó que uno de los gases que se forman durante la fabricación del coke, el metano, oxidado por el oxígeno del aire, se cambia en formaldehído, y que las moléculas de este gas se unen a las moléculas de otras sustancias, bajo ciertas circunstancias. Y otra cosa más: de esta unión resultan compuestos muy complejos.
El profesor de Kazan averiguó que ciertos compuestos de carbono e hidrógeno hidrocarburos, que son precisamente componentes de los gases que se forman durante la fabricación del coke o durante el tratamiento del petróleo, tienen un hambre terrible. Se dice que no son saturados y por eso desean una unión directa con otros hambrientos como ellos mismos. Químicamente hablando: los gases que se forman durante la fabricación del coke y el tratamiento del petróleo y que llamamos hidrocarburos simples no saturados, crean materias líquidas y una especie de hule a consecuencia de su unión recíproca. Podemos acelerar esta unión recíproca agregando ciertas otras sustancias a las que se están combinando. Estas sustancias, que ayudan a que se realice la reacción que no ocurre tan bien de otra manera, se llaman catalizadores; son ayudantes generosos y desinteresados.
Se dirá, a primera vista, que hablamos más de lo necesario del formaldehído. Tal vez hubiera bastado recordar que el formaldehído es un gas que se forma durante la fabricación del coke a partir de hulla, o durante el tratamiento del petróleo, y que fue descubierto por el químico ruso Butlerov en 1859. Pero este descubrimiento no fue cualquier descubrimiento. Pronto nos encontraremos de nuevo con el formaldehído, y de nuevo recordaremos al modesto profesor de Kazan, cuando hablemos de las materias plásticas modernas. Es que el formaldehído es una de las materias básicas que se utilizan para la fabricación de las materias plásticas modernas. Se llama formol la disolución acuosa de formaldehído. Pero mientras, tendremos que seguir pacientemente otro trecho a los dos químicos alemanes. Los dejamos en el momento en que agregaron formol al polvo blanco seco de caseína.
17. Botones en lugar de pizarras
¿Qué pasó cuando Krische y Spittler agregaron el formol a la caseína? Pasó lo que querían. El polvo blanco se solidificó y ante los dos químicos apareció una materia córnea artificial, dura, de color amarillo oscuro. La segunda materia plástica había nacido.
Adviértase la semejanza de los destinos de la primera materia plástica, el celuloide, y la segunda, que sus descubridores llamaron galalita. Hyatt trataba de obtener una materia que remplazara al marfil, y descubrió el celuloide. Krische y Spittler querían fabricar pizarras blancas irrompibles, y descubrieron la galalita, que no podía servir para fabricar tales pizarrones para niños de escuela, pero que convenía perfectamente para la fabricación de botones, cajas, peines y otros incontables artículos. Hyatt y los dos químicos alemanes empezaron sus experimentos después de ver en los periódicos avisos que prometían recompensas por la fabricación de nuevas materias sintéticas. Sin embargo, había entre ellos cierta diferencia. Hyatt no sabía absolutamente nada de química, mientras que los dos alemanes eran químicos.
Una palabra más acerca de la galalita. Hoy esta segunda materia sintética está eclipsada: 30 litros de leche por un kilogramo de caseína para fabricar botones, es demasiado en una época en la que se puede aprovechar mejor la leche.
Si quieren, pueden mirar el esquema de la fabricación de la galalita. Porque ya es tiempo de conocer el tercer hijo de la familia de las materias plásticas.
18. La carta de Rochester
En el tren que corría de Nueva York a Rochester iba sentado junto a la ventanilla un hombre que no tenía todavía cuarenta años, llevaba anteojos sobre su nariz ancha y bigotes como se usaban en aquellos tiempos (faltaba un año para que acabase el siglo pasado). El paisaje desfilaba rápidamente, pero el hombre de la ventanilla no se fijaba en él.
Hacía unos días había recibido una carta que lo invitaba a Rochester para discutir su invención. El director de la fábrica Kodak, que fabricaba aparatos, películas y papeles fotográficos, había invitado al profesor Leo Henry Baekeland a charlar acerca de la venta del papel fotográfico que había descubierto, el cual se podía usar incluso con alumbrado artificial. Hasta entonces se conocía sólo un papel que únicamente imprimía fotografías tomadas cuando brillaba el Sol.
El hombre de la ventanilla, consideraba el punto siguiente: le pediré 50 000 dólares por este descubrimiento. Si me los da, bueno. Pero ¿y si no me los da? No acepto menos; no lo vendo, por ejemplo, por 25 000 dólares.
Ante las ventanillas del tren pasaban las primeras casas de Rochester; el doctor Baekeland bajó y se dirigió rápidamente a la fábrica, que tenía en la puerta un gran letrero: "Kodak".
- Su invención es algo fabuloso, profesor dijo el director a Baekeland, recibiéndolo. Esto no se puede comparar con los papeles que ya conocemos. ¿Cuánto quisiera por ello?
De repente el profesor no supo qué partido tomar. Si decía 50 000 dólares, se burlaría de él. Y tal vez no vendería nunca su Velox.
Es que no fue nada sencilla la historia de esta invención. Baekeland estaba completamente convencido de esto. Empezó a fabricar solo su nuevo papel fotográfico, pero los fotógrafos de profesión no le tenían confianza a esta novedad. Al final tuvo que dirigirse personalmente a los fotógrafos aficionados. Pero ni siquiera éstos manifestaron interés especial por el nuevo papel.
El doctor Leo Henry Baekeland sabía lo que era la miseria. Pertenecía a una familia belga pobre, y cuando ingresó a la Universidad de Gante, como excelente alumno, a los dieciséis años, tuvo que dar clases a los estudiantes menos talentosos y ayudar en el laboratorio, para conseguir mantenerse y pagar sus estudios. A pesar de ello, se doctoró en el año de 1884, con los máximos honores summa cum laude , como se dice en latín, según convenía a un estudiante que no tuvo más que excelentes calificaciones. A los 24 años llegó a profesor de química en Gante, y después de tres años allí, fue profesor de química y física en la Escuela Superior Técnica de Brujas. Baekeland fue profesor siete años en total, se casó y cruzó el océano. Pensó que al otro lado del mar le iría mejor que en Bélgica. Pero ¡qué desilusión se llevó el joven químico en cuanto vio el Nuevo Mundo! Trabajó dos años como químico en una fábrica de artículos fotográficos, luego probó suerte como asesor químico privado. La gente que conocía a Baekeland en aquella época decía de él: Tiene pocos clientes y menos dinero; sólo las ideas le sobran.
De veras mal le fue al profesor de Brujas. Enfermó, se endeudó y ya no sabía qué hacer. Al final se decidió a concentrarse en una sola cosa que pudiera liberarlo de la miseria y a abandonar las demás ideas que tenía en la cabeza. Se acordó de su actividad en la fábrica de artículos fotográficos y de las dificultades existentes para obtener fotografías cuando no brillaba el Sol. Y se decidió a inventar un papel fotográfico con el que fuera posible trabajar incluso con alumbrado artificial.
Y allí estaba sentado el inventor del Velox, escuchando los elogios dirigidos a su invención por el director de la más grande fábrica estadounidense de accesorios fotográficos.
- Bueno, ¿cuánto? preguntó el director con impaciencia.
- ¿No sería mejor que usted mismo me ofreciera algo? El doctor Baekeland fijó sus ojos inteligentes, detrás de los anteojos, en la cara del director.
- ¿Le convendría un millón de dólares? preguntó el director.
Más tarde, cuando Baekeland contaba esta conversación, decía que su gran suerte era haber estado sentado en una silla bien firme en aquel momento. No pudo pronunciar una sola palabra. Pero en menos de una hora había firmado el contrato que le permitía dedicarse tranquilamente a los experimentos que había tenido que abandonar no hacía mucho tiempo. Todo el mundo debe algo a este contrato, ya que al poco tiempo hizo que naciera una nueva materia plástica, la tercera. Por eso hablamos tanto de él. Hay que añadir un detalle: el papel que se llama Velox se utiliza aún hoy. Y así el millón de dólares ya ha regresado muchísimas veces a los bolsillos aparentemente generosos de la fábrica Kodak.
19. Al principio fue el "coccus lacca"
Sí, es un insecto corriente, parecido en todo a cualquier pulgón. Vive en la India, se llama Coccus lacca , y es el insecto de la laca.

Figura 34. Insecto de la laca. Hembras del insecto de la laca y hembra adulta con el cuerpo cubierto de laca. (Longitud real: 1-2 mm.)
Vive en las ramas de ciertas plantas. Allí perfora las cortezas, y las plantas segregan una resina de color rojo subido. Las hembras de este animal se reúnen a montones y se atiborran de la resina que sale. Cuando les nace otra generación debajo de su caparazón, todos juntos empiezan a comerse la capa rojo subido. Y es en este momento cuando los aborígenes quitan la resina de las plantas, para venderla como laca. Esta laca se utilizaba para la fabricación de discos de gramófono y su consumo mundial aumentaba a diario. Y eso precisamente le dio a Baekeland que se había instalado con alegría en su laboratorio en la villa de Yonkers la idea de tratar de fabricar sintéticamente lo que segregaba la planta acosada por el insecto Coccus lacca .
En una revista química de 1909, Baekeland describió detalladamente cómo se había preparado para este trabajo. En primer lugar, leyó a fondo todo lo que habían escrito los químicos que habían inventado cosas parecidas hasta entonces. Luego repitió todos aquellos experimentos que, según afirmaban sus autores mismos, no conducían a nada, y descubrió errores que habían cometido sus predecesores.
¿No se preguntan por qué Baekeland se tomó el trabajo de leer lo que habían escrito otros acerca de experimentos infructuosos? ¿Por qué no realizó un análisis químico de la materia segregada a causa del insecto de la laca? Averiguaría así de qué sustancias químicas se compone la laca natural, y luego tal vez ya no sería tan difícil fabricarla sintéticamente.
Pero desgraciadamente había un problema bien embarazoso: el producto del insecto de la laca no cristalizaba y tampoco se podía disolver fácilmente. Esto quiere decir que no era nada fácil de analizar químicamente.

Figura 35. Insecto de la laca. Fragmento de una rama cubierto de resina.
Por eso Baekeland empezó por estudiar los trabajos y experimentos de sus predecesores y al final llegó a la conclusión de que todo el secreto de la fabricación de lacas sintéticas se encontraría en la unión química del fenol y del formaldehído. Sabía que estas dos materias producen, al reaccionar, compuestos de alto peso molecular. Naturalmente, sería necesario regular esta unión que se llama poli condensación, interrumpirla en el momento preciso para que no se fuera a formar una materia demasiado rígida, que no sería posible utilizar.
La luz brillaba hasta muy entrada la noche en el laboratorio de Yonkers. Los experimentos se sucedían. Pero esta vez la suerte había abandonado al emigrado belga. Muchos químicos hubieran dejado allí mismo el juego con el fenol y el formaldehído, sobre todo si hubieran leído más de una vez como lo había hecho Baekeland que los experimentos con estos dos compuestos no conducían a nada. Es cierto que Baekeland trató de agregar otras sustancias al fenol y el formaldehído, y que ensayó como catalizadores, para ayudar al proceso químico, toda suerte de ácidos y bases. En vano. Obtenía cosas muy parecidas a pasteles de alquitrán con espuma encima. Con aquello no se podía barnizar nada.
Por suerte Baekeland tenía tiempo. Pudo seguir experimentando pacientemente. Un día se le ocurrió algo: ¿Si hiciera lo contrario de lo hecho hasta ahora? En lugar de tratar de mantener una temperatura baja durante la reacción del fenol y formaldehído, procurar elevar la temperatura lo más posible y facilitar la reacción química aplicando una intensa presión.
Mezcló el fenol y el formaldehído en iguales proporciones, vertió la mezcla en una autoclave (la autoclave es un recipiente de metal provisto de una tapadera hermética, donde se calientan los líquidos a presión más elevada que la atmosférica; recuérdese la famosa olla de Papin) y la calentó a una temperatura de 200°C bajo presión. Luego esperó pacientemente para ver qué pasaría. Y lo que pasó fue que se formó un líquido que se solidificó al aire, y cuando se solidificó tomó la apariencia del ámbar. Era, incluso, más duro que esta resina natural y el agua no tenía ningún efecto sobre él y era posible trabajarlo con un cuchillo afilado.
Baekeland no se contentó con la verificación de estas propiedades. Quiso saber más: cómo se portaría la nueva materia ante la corriente eléctrica, si sería malo o buen conductor del calor y si se alteraría químicamente con el tiempo. El belga siguió haciendo experimentos, pacientemente, durante dos años, hasta averiguar en qué proporciones convenía combinar el fenol y el formaldehído y qué catalizador era más apropiado para tal combinación. Sólo cuando se convenció de que la nueva materia sintética era un mal conductor de la electricidad y del calor y de que el tiempo no tenía ningún efecto sobre ella, le dio un nombre muy parecido al suyo: baquelita (la terminación viene de la palabra griega lithos , que quiere decir piedra).
La primera patente que se refería a la tercera materia plástica tuvo el número 942699.
El doctor Baekeland no quedó desilusionado por el hecho de haber descubierto la tercera materia plástica en lugar de una laca sintética. El día 6 de febrero de 1909, en una reunión de químicos en Nueva York, presentó por primera vez conmutadores eléctricos, boquillas y también discos de gramófono de baquelita, y declaró que conocía once maneras de utilizar su invención. En aquel tiempo el antiguo profesor belga de química, luego feliz inventor de un papel fotográfico y entonces genial descubridor de la baquelita, no se pudo imaginar ni en sueños que algunas decenas de años más tarde su materia plástica se haría auxiliar indispensable de todos los sectores industriales. Desde la manufactura de conmutadores eléctricos, aparatos telefónicos, cajas de radio y artículos para fumadores, hasta la fabricación de automóviles y aviones.
Fue necesario agregar todavía algo a las materias fundamentales, el fenol y el formaldehído. Lo llamamos carga o relleno. ¿Por qué? El relleno es en general aserrín o papel molido, tejidos, asbesto, arena o fibras de vidrio: disminuye el consumo de materias básicas, llena el espacio entre las partículas y así refuerza la consistencia de las moléculas formadas por condensación del fenol y el formaldehído; sin él no se obtendría una materia plástica de propiedades tan útiles.
Naturalmente, hay diferencias entre los distintos rellenos. Si quisieran fabricar, por ejemplo, un palo de golf de baquelita, no agregarían aserrín al fenol y el formaldehído, sino recortes de tela que sobra, por ejemplo, de la fabricación de camisas. El palo será catorce veces más sólido.
Así el principal ingrediente de la mayoría de las materias plásticas es algún compuesto orgánico de carbono e hidrógeno, oxígeno y, si acaso, otros elementos. Lo llamamos aglutinante. En el caso de la galalita es la caseína; en el caso de la baquelita, el fenol y el formaldehído; en el caso del celuloide la nitrocelulosa.
El segundo componente, muy importante en esta fabricación, es el ablandador, que cambia la materia fundamental, frágil, en una materia pastosa, para que se pueda moldear. Durante la fabricación del celuloide se utiliza el alcanfor, de olor penetrante, como ablandador; durante la fabricación de galalita se usa glicerina.
El tercer componente de las materias plásticas es el relleno, materia barata, que ahorra dinero, por el hecho de que hace la materia plástica todavía más sólida y disminuye su peso.
Y al final, a todo esto que acabamos de mencionar se agrega un colorante, para obtener la materia plástica del color que se desee.
Fíjense en una cosa más: en la producción de celuloide o galalita sólo unimos grandes moléculas ya preparadas, tales como se encuentran en la naturaleza. Así se forma la materia plástica. No hacemos más que reagrupar las moléculas ya preparadas y producidas por la naturaleza. Pero es un poco diferente el caso de la baquelita. En ella las grandes moléculas se han formado a partir de las pequeñas moléculas del fenol y del formaldehído, generadores de una nueva materia plástica.
Esto representa decididamente un progreso en el desarrollo de las materias plásticas. Un progreso que acarreó la aparición de más materias plásticas.
20. Adiós, profesor
Uno pensaría que, como Baekeland descubrió algo todavía más extraordinario que el papel fotográfico Velox, el profesor viviría feliz y tranquilo en su laboratorio en la pequeña ciudad estadounidense.

Figura 36
Así terminaría el cuento de hadas del hombre ligado a todo el mundo por el gran progreso realizado en el desarrollo de las materias plásticas. Pero la vida es un poco distinta de un cuento de hadas. Apenas el doctor Baekeland publicó su invención, por todas partes se oyeron voces que aseguraban que no se trataba de nada nuevo, y que aunque fuera nuevo no servía para nada. Pero Baekeland no se inquietó. Empezó a producir baquelita y su manufactura se difundió rápidamente, incluso más allá de las fronteras de los Estados Unidos de América.
Y Baekeland no dejó de trabajar ni siquiera cuando estuvo cubierto de honores que le llegaban de todo el mundo. Hasta los 76 años eso fue en 1939 no se retiró. Se instaló en su casita en la costa de California, y con la misma paciencia y el mismo amor con que se había dedicado a la química en su juventud, se entregó allí al cultivo de plantas tropicales.
En medio de las maravillosas creaciones de la naturaleza murió, en el año de 1944, su no menos maravilloso imitador.
21. El boticario de Praga
El día 16 de mayo de 1918, cierto boticario de Praga, que se llamaba Hans John y vivía en la calle de Hus número 5, se presentó en la Oficina de Patentes de Viena, para hacer registrar un nuevo invento. Pero la Oficina de Patentes ya no tenía tiempo para atender la solicitud del boticario de Praga. El Imperio Austro-Húngaro había caído en el otoño de aquel año, y los documentos ya que se trataba de un ciudadano checoslovaco habían sido enviados a Praga. Ya estaban tramitando allá la fundación de una nueva Oficina de Patentes Checoslovaca. Y el día 6 de agosto de 1921, esta oficina registró, bajo el número 6150, en un libro muy voluminoso, encuadernado en piel, llamado Registro de Patentes, el derecho de Hans John de utilizar "El método de fabricación de productos condensados a base de formaldehído y urea, o tiourea u otros derivados de la urea".

Figura 37
Pocos años más tarde apuntaron al lado de esto, con bonita letra, que el boticario John no había pagado sus derechos de patente por segunda vez y que, por esta razón, caducaba su derecho de patente en el año 1926.
¿Por qué fui a consultar los viejos libros de la Oficina Estatal para las Invenciones y la Normalización que sucedió a la antigua Oficina de Patentes? Porque detrás de algunas frases escritas con bonita letra, pero ya pálidas, se esconde, según yo, un acontecimiento extraño y al mismo tiempo dramático.
Pero otra vez debo retroceder, como tantas otras veces. Esta vez serán 134 años. En el año 1827, Friedrich Wöhler fue el primer hombre en el mundo que obtuvo urea a partir de un compuesto inorgánico, el cianato amónico, sin recurrir a la "fuerza vital" de ningún organismo. Este descubrimiento tuvo una importancia que hizo época, porque con este golpe Wöhler derribó la frontera que existía hasta entonces entre química orgánica e inorgánica. Hasta la época de Wöhler eran clasificadas como materias orgánicas las que provenían de un organismo animado. Las que pertenecían a la naturaleza inanimada, inorgánica, se incluían entre las materias inorgánicas. Wöhler demostró, con la obtención de urea sintética a partir de materias inorgánicas, que tal frontera era artificial.
El mundo admitió el hallazgo de Wöhler, lo registró y siguió adelante. ¿Y qué más pasó con la urea? A decir verdad, es cierto que alguna vez, en la penúltima década del siglo pasado, aparecieron en alguna revista química un par de renglones, mencionando que al agregar formaldehído a la urea se forma una materia sólida. Pero nadie se fijó en esto en serio y la urea fue de nuevo olvidada.
Y luego, después de 40 años, un boticario checo, del todo desconocido, de repente patenta su derecho a fabricar una materia sólida a partir de urea y formaldehído. Dos meses después de presentar esta solicitud de patente, el doctor John presentó otra. Había descubierto un método todavía mejor para fabricar una materia sólida a partir de urea. Y esta solicitud tuvo un resultado positivo. El boticario recibió una nueva patente, anotada con el número 10011 en el libro encuadernado en piel, como su primera patente, pero hasta el día 28 de febrero de 1923.
¿Para qué exactamente recibió el derecho de patente el boticario de la calle de Hus? Para la fabricación de una nueva materia plástica, la cuarta: ¡la resina de urea y formaldehído!
Ahora ustedes supondrán que alguien se ocupó de este asunto y que comenzó a fabricar el material en Checoslovaquia. Están equivocados. También al lado de esta segunda inscripción consta que la patente caducó, porque el doctor John no pagó los derechos anuales que se deben pagar por el otorgamiento de la patente.
Fue un ciudadano checoslovaco el primero en el mundo en recibir una patente referente a la fabricación de un plástico de urea y formaldehído. ¡Pero no pasó nada en Checoslovaquia, país tan bello y tan industrializado!
Pero sigamos hojeando la literatura que trata de la historia de la aparición de las materias plásticas a base de urea. ¿Y qué encontramos? El nombre de cierto químico vienés, Fritz Pollak, que hizo registrar algunos años más tarde una patente sobre un "Método de obtención de productos condensados a partir de formaldehído y urea, o tiourea u otros derivados de la urea."
No es esto todo. Sabemos también que Fritz Pollak empezó a fabricar la materia plástica a partir de urea según su patente, y que la llamó pollopas. Era una materia plástica transparente, parecida al vidrio, pero tenía un defecto: era demasiado frágil. No duró mucho tiempo; en Francia, Inglaterra y Estados Unidos de América empezaron a ocuparse de esta materia. La privaron de su fragilidad, le hicieron mucha publicidad y la producción tomó un buen camino.
Examinemos una vez más el Registro de Patentes, que se encuentra en la Oficina Estatal para Invenciones y Normalización. ¿No olvidamos nada cuando examinamos por primera vez el libro encuadernado en piel? Sí, olvidamos algo. Se nos escapó un pequeño detalle: "Derecho de patente transferido a la Compañía Pollopas Ltd., London".
Entonces es así como terminó el invento del boticario de Praga, el doctor Hans John. El invento que nació en la "Ciudad Vieja" de Praga, en la calle de Hus número 5, terminó en Londres, después de permanecer, naturalmente, algún tiempo con el químico vienés Fritz Pollak. Fuera que el doctor John no quisiese fabricar en Checoslovaquia la materia plástica que descubrió o que no encontrara en aquella época una fábrica que quisiese producir el producto, fue una lástima, y veremos en seguida por qué.
22. Carniceros y amas de casa
En los años treinta de nuestro siglo, los carniceros estadounidenses buscaban balanzas más ligeras. Las que utilizaban hasta entonces para pesar las libras de carne a las amas de casa, eran demasiado pesadas, lo cual no tenía nada de raro, puesto que eran completamente de metal. Cuando aumentó la demanda de balanzas más ligeras, una de las fábricas que las producían decidió buscar la manera de fabricar de materia plástica algunas de las partes de las balanzas de carnicería. En el año 1928 no se conocían más que tres materias plásticas: el celuloide, la galalita y la baquelita.
Les pareció que convendría la última de las materias mencionadas, la baquelita, para la fabricación de balanzas más ligeras.
Al mercado y a las carnicerías llegaron pronto balanzas en verdad más ligeras. Toda la caja, que era hasta entonces de esmalte blanco, se fabricó de baquelita oscura.
Pero ¿qué estaba pasando? Los carniceros que habían comprado tales balanzas se dieron cuenta pronto que disminuía el número de sus clientes. Buscaron la razón y descubrieron que las amas de casa no acudían a comprar, porque les repugnaba el color oscuro de la balanza. Afirmaban que los carniceros usaban aquellas balanzas negras para disimular la suciedad.
Tal era entonces la opinión de las amas de casa, que daban la preferencia a las tiendas donde todo era blanco y limpio. Como no era posible fabricar baquelita que no fuera parda o negra y como los carniceros querían, a toda costa, tener balanzas más ligeras, pero de materia plástica clara, no le quedó más a la fábrica que tratar de fabricar balanzas que no fueran de baquelita.

Figura 38. Esquema de la fabricación de las materias de urea-formaldehído.
Entonces alguien se acordó de la materia cuya fabricación estaba inscrita en el Registro de Patentes de Praga bajo el número 6150 y que se podía conseguir por reacción entre urea y formaldehído. La urea que se utilizaba para esto no provenía de un organismo vivo, era urea sintética, cristales blancos fabricados a partir de anhídrido carbónico y amoniaco.
Si no sirve la baquelita, ensayemos la materia sintética fabricada a partir de urea, se dijeron los fabricantes de balanzas; y lo probaron. El éxito fue mayor que lo esperado. La nueva materia plástica, que recibió el nombre de plascón, se podía teñir de color claro, y así podían escoger los carniceros. Tuvieron balanzas de todos los matices posibles. Y las amas de casa quedaron contentas.
Hoy se fabrican con aminoplásticos como llamamos a las materias plásticas que se fabrican a partir de urea utensilios para el hogar, como por ejemplo platos, saleros, tazas, y también cajas de radio, máquinas de rasurar, estuches para lentes y tubos de lápiz labial.
El plástico se produce en aparatos inoxidables provistos de un dispositivo de agitación, de un sistema de enfriamiento y dispuestos para eliminar el agua durante la reacción química. Se echa poco a poco la disolución acuosa y caliente de urea en el recipiente que contiene el formol (disolución acuosa de formaldehído). Se utiliza carbonato de sodio como catalizador, para acelerar el proceso. La policondensación o sea la transformación de las dos sustancias de bajo peso molecular, urea y formaldehído, en materia de alto peso molecular, reacción durante la cual se elimina el agua (por eso se llama policondensación y no polimerización, durante la cual no se elimina agua) se realiza mezclándose constantemente y a una temperatura de 70°C.
Pero no quedaremos satisfechos con lo conseguido a esta temperatura. Es una resina acuosa que sirve como pegamento. Pero lo que queremos es fabricar una nueva materia plástica dura. No nos queda más que seguir mezclando, y elevar todavía más la temperatura.
Ahora bien, lo que pasa en el recipiente de reacción es algo más que una condensación corriente. Es una condensación multiplicada, repetida, una condensación doble, triple, múltiple. La materia que está en el recipiente se espesa cada vez más, hasta solidificarse completamente.
Con eso termina nuestro trabajo. No completamente, a decir verdad. Todavía debemos moler y empacar esta materia artificial, cuyo color es el del colorante que le agreguemos. Con el producto obtenido se puede fabricar toda especie de artículos, prensando el polvo en moldes.
Pero las resinas de urea-formaldehído se utilizan hoy también de otra manera. En la industria textil, con ellas en forma de disoluciones se tratan fibras, con las cuales se fabrican luego tejidos inarrugables. Convirtiéndolas en espuma es posible fabricar con ellas objetos tan ligeros que comparándolos con los de corcho, parecen éstos muy pesados, pues llegan a pesar nueve veces más que los hechos de plástico a base de urea. Y estos materiales ligeros convienen perfectamente para la construcción de instalaciones de refrigeración, por su mala conductividad térmica.
Naturalmente, a las materias plásticas de urea y formaldehído se les hace lo mismo que a las demás materias plásticas: se les agrega un relleno, especialmente aserrín.
Claro que no tendremos ni que decir que ni las vajillas, ni las vasijas ni los tubos de lápices labiales hechos de aminoplásticos huelen mal, y que, higiénicamente, son del todo irreprochables.
Pensemos una vez más en lo raros que son a veces los caminos de las invenciones. Con dificultades, la invención viaja de la calle de Hus, en la "Ciudad Vieja" de Praga, a Londres, pasando por Viena; luego hasta América. Es nuestra cuarta materia plástica. Luego la imponen las amas de casa que prefieren las balanzas de carnicería de urea-formaldehído a las de baquelita.
23. Cien años perdidos
Despidámonos de las materias plásticas contando la historia de una de ellas, que se llama en breve PVC, pues el nombre completo es cloruro de polivinilo.
Pero no vayamos a pensar que no existen en el mundo más que las cuatro materias plásticas que ya vimos, y la quinta, de la cual empezamos a hablar. Tuvo razón el que dijo que el campo de los plásticos es como los circos de varias pistas. No sabemos a dónde mirar, ni qué cosa en alguna de las pistas nos sorprenderá de un momento a otro. Hay más de treinta tipos de materias plásticas. Escogimos para la despedida precisamente el PVC, entre todas éstas, por una buena razón. Es la materia plástica más conocida en el mundo actual. La tercera parte de la producción mundial de materias plásticas corresponde precisamente al cloruro de polivinilo.
La resina vinílica que es la base de la materia plástica PVC no es ningún invento de estos últimos días. Ya hacia el año de 1835, el químico francés Regnault hubiera logrado obtenerla. Pero el francés se quedó a la mitad del camino. Combinó acetileno con ácido clorhídrico (como se sigue haciendo hasta ahora), pero no mencionó en ninguna parte que hubiera obtenido, por polimerización del producto, una materia de alto peso molecular que llamamos hoy PVC. Y nuestro conocido, el profesor alemán A. W. Hofmann, que descubrió la anilina y fundó en Londres la primera escuela superior de química, a solicitud de la reina de Inglaterra, estuvo a punto de hacer el gran hallazgo. Pero se le escapó un secreto maravilloso de entre las manos. Durante sus experimentos llegó a una materia de alto peso molecular, un verdadero polímero vinílico, pero no supo qué hacer con ello. Esto fue en 1860.
El mundo tuvo que esperar todavía otros 52 años la primera patente con la cual el químico ruso Ostromislenskii salvaguardó su invención, que era la fabricación de polímeros vinílicos, que son plásticos vinílicos de grandes moléculas. Su patente se registró y, como otras veces, no pasó nada. Nadie la utilizó industrialmente, a nadie se le ocurrió que en aquellos pocos renglones que certificaban el derecho de patente del ingeniero ruso, estaba escondida la llave de la fabricación de la materia plástica más extendida hoy. A nadie se le ocurrió que la materia fabricada por Ostromislenskii, y que era terriblemente dura, se pudiera amansar agregándole ablandadores, en resumen, que se pudiera obtener de ella una verdadera materia plástica.
Fueron otorgadas algunas otras patentes, relativas a la elaboración de la resina vinílica, pero nadie quiso de veras fabricarla industrialmente. Hasta que la necesidad forzó a hacerlo. Otra vez el lamentable Pearl Harbor, la agresión de los aviones japoneses a la armada estadounidense en la isla de Oahu, se encuentra al principio del desarrollo acelerado de la nueva materia plástica, el cloruro de polivinilo.
Iniciada la guerra con Japón, la armada estadounidense pidió a la industria que le suministrara lo más pronto posible, cubiertas impermeables aisladoras para cables. Necesitaba también rápidamente algo que pudiera hacer impermeables los tejidos. Corría el año 1941, y los químicos sacaron de las bibliotecas y de los repertorios de patentes todo lo que había escrito acerca del compuesto que se llama cloruro de vinilo y del cual se sabía tan poco.
Y cuando se familiarizaron con lo que se había publicado sobre él y con las experiencias que habían realizado con él hasta entonces, los químicos modernos dirigieron su atención hacia las caleras.
24. Acetileno + ácido clorhídrico = PVC
La cal es el primer eslabón de la cadena que representa la fabricación de fundas plásticas aisladoras para cables, o incluso de casas enteras de materia plástica, como la que construyeron en Canadá no hace mucho tiempo. Sigamos, pues, la peregrinación de la cal hasta su transformación milagrosa en materia plástica. Si tratamos en hornos eléctricos especiales, a una, temperatura de 3 000°C, cal con gas de coke, obtenemos un compuesto que conocen todos: el carburo. Es una materia blancuzca, de olor nada agradable, y cuando le echamos agua, emite un silbido y desprende un gas incoloro: el acetileno. Nuestros abuelos alumbraban sus casas con él, quemándolo en lámparas. Si se respira el acetileno ordinario, hace daño, y en caso de una dosis más fuerte se puede perder el conocimiento. El acetileno es el padre del PVC. El otro progenitor es el ácido clorhídrico. Sabemos que es un gas venenoso, de sabor ácido, de olor penetrante, fumante al aire húmedo. Se fabrica a partir de la sal común, con ácido sulfúrico. Durante esta reacción química se forma también, además de ácido clorhídrico, sulfato de sodio, pero éste no nos importa aquí.
Ahora, si calentamos juntos acetileno y ácido clorhídrico, se forman gases, entre los cuales encontramos el cloruro de vinilo. Sólo éste nos interesa. Preferimos obtenerlo puro, sin la menor huella de otra materia química. Para ello enfriamos los gases, los lavamos y luego los secamos. Esto no es cosa sencilla, pero tenemos aparatos perfeccionados que realizan esta importante misión. Tenemos primero que eliminar todas las demás materias y dejar puro el cloruro de vinilo; sólo entonces estaremos en condiciones de emprender la operación que consiste en transformar las pequeñas moléculas en moléculas grandes. La verdad es que no podemos obtener un cloruro de vinilo completamente puro. Pero basta con que no contenga más de 0.5% de otras materias.
¿Cómo realizaremos la polimerización, que es la transformación de materias de bajo peso molecular en materias de alto peso molecular? El químico contesta a esta pregunta. En las autoclaves, que ya conocemos (sabemos que son recipientes con una tapadera firme, ajustada herméticamente). En la autoclave, que ya contiene el agua necesaria, introducimos cloruro de vinilo e iniciamos la agitación. Mientras el agitador funciona, la mezcla se calienta sola en la autoclave. La temperatura llega a ser alta, tanto que si no se enfriara la mezcla de afuera, estallaría.
En este momento empieza el milagro, la transformación de las pequeñas moléculas en grandes. Y cuando termina la polimerización, queda uno sorprendido al ver el líquido absolutamente corriente que resulta, muy parecido a la leche. ¿Qué se hace con él? Si lo comparamos, por ejemplo, con un moderno disco de gramófono, apenas se puede creer que el disco duro, irrompible, sea fabricado con la emulsión lechosa que acabamos de obtener.
Todavía debemos esperar un momento, pacientemente. Vertemos la emulsión en jeringas con inyectores finos y empezamos a pulverizarla en una máquina secadora llena de aire caliente. Allí la leche se vuelve en seguida un polvo blanco. Y con esto termina para nosotros el proceso químico. Acabamos de fabricar otra resina sintética, el cloruro de polivinilo, el famoso PVC.
Un químico minucioso nos reprocharía haber simplificado el proceso. Pues para obtener el verdadero PVC es necesario agregar a la emulsión lechosa algunas sustancias, que se llaman estabilizadores, para que la mezcla no se altere químicamente desde la autoclave, por su largo camino, hasta el producto final. Olvidamos el ablandador, que ayuda a hacer la pasta que luego se puede moldear con más facilidad; olvidamos también el colorante.
Todo es verdad. Sólo se trataba de saber con qué se fabrican impermeables, discos de gramófono, aisladores de cables, tubos inoxidables, imitaciones de la piel natural, o también la mencionada casita en Canadá, que es completamente de PVC. Ahora sabemos lo que queríamos: en principio son de acetileno y ácido clorhídrico, que se transforman por un proceso un poco complicado en un polvo blanco de cloruro de polivinilo. Después de agregarle todo lo que no olvida un químico minucioso, pueden hacer con él lo que quieran: inyectarlo en moldes y con la ayuda de una prensa hidráulica dar a esta materia suave el aspecto que encargue el que pague el molde. O podemos laminarla con rodillos calientes para que se transforme en hojas. A partir de este momento dominamos la materia plástica conocida como PVC: la materia plástica que empieza a dominar al mundo.
25. Parecidos y sin embargo distintos
No existe ningún sector de nuestra vida donde no nos encontremos con el plástico PVC. Puede remplazarlo todo: la madera, los metales, el vidrio, la porcelana, las piedras preciosas, los ladrillos. Lo encontramos, usado como prótesis, en el cuerpo humano. Pero no es un producto usado a falta de algo mejor, como las plantas que se explotaron durante la primera Guerra mundial en vista de la carencia de lana y algodón.

Figura 39.
Es un material de construcción multiforme, que fabricó el químico de tal manera que contenga lo mejor de lo que creó la naturaleza. El químico moderno puede fabricar, con materias primas comunes, productos que dota de las propiedades que la naturaleza reparte entre varias materias y que no concede a una sola.
El alquimista moderno da a su nueva invención ligereza, solidez, permanencia y belleza. Con eso le quitó al hombre el miedo a que le falten un día acero, madera, piel o hule natural.
Y en esto está el mayor mérito de los que descorrieron el velo que ocultaba los misterios de la fabricación de las materias plásticas.
EL HOMBRE Y EL PERFUME
Contenido:
1. Una de las insuficiencias del ser humano
2. Viaje a la tierra de la reina de Saba
3. ¿Por qué huelen bien las flores?
4. No sólo las flores
5. El gato y la cucharita
6. El perfume de las flores
7. Otra vez el químico
8. El profesor que amaba las violetas
9. Fin de una tradición, comienzo de otra
11. Despedida
1. Una de las insuficiencias del ser humano
Quisiera aún hablar de un sector de la química que se acerca más a la poesía: la química de los perfumes. Me interesa no sólo uno de los secretos interesantes del cuerpo humano, el sentido del olfato, sino también el comportamiento de nuestros antepasados, que trataron de aplicar los perfumes de las plantas e incluso de los animales sobre sus cuerpos o alrededor de ellos, sólo para embellecer la vida.
Antes de llegar al perfume de las violetas, de la rosa o del ámbar, debemos empezar con la nariz humana. Muchos sabios fisiólogos se han roto la cabeza tratando de averiguar qué es el olfato, por qué hay quien lo tiene más fino que otros, por qué y cuándo percibimos perfumes o malos olores o no percibimos nada en absoluto.
Presentaremos la última hipótesis científica sobre lo que suscita la sensación olfativa, su transmisión a los centros nerviosos y el mecanismo que permite discriminar entre las múltiples especies de olores.
Los científicos afirman que las moléculas de las materias olorosas vibran. Esta vibración se trasmite a las células del cerebro por las fibras nerviosas. Éstas son largas hebras protoplásmicas, extraordinariamente finas, su diámetro llega a ser inferior a un milésimo de milímetro y hace falta un microscopio muy poderoso para verlas. Y estas fibras tienen cargas eléctricas en su superficie: negativa en la parte interior, positiva en la exterior. Los científicos creen que en el sistema nervioso existen estaciones intermedias que amplifican las señales producidas por la vibración de la molécula de materia aromática.
Le da vueltas la cabeza a uno, cuando se entera de que los órganos olfatorios están ligados al cerebro por 45 000 fibras nerviosas, por las cuales viaja la noticia del aroma. Se trata de un mecanismo tan ingenioso, que esta red telegráfica humana puede trasmitir más de 16 000 000 de informaciones acerca de la molécula de materia aromática que ha tocado los órganos receptores. O, dicho muy sencillamente, informa cuál es el olor que llega a la nariz del hombre.
Toda esta información se concentra en una especie de central telegráfica, en terminaciones nerviosas cargadas de un pigmento amarillo oscuro. La molécula de este pigmento vibra con la misma frecuencia que la molécula de la materia aromática. Y en esto precisamente reside todo el secreto: con esta vibración se forma el impulso nervioso que trasmite al cerebro humano la noticia del olor. Es por esta larga vía nerviosa perfeccionada por donde se precipitan toda especie de señales al cerebro. Éstas se reúnen como un telegrama que comunica al hombre los detalles del perfume, le da una idea precisa de él. Así el hombre puede distinguir varios olores. Es algo fantástico.
Y decididamente esta última teoría de la olfación demuestra otra vez que el cuerpo humano es un mecanismo muy ingenioso. Pero por lo que se refiere al olfato, cualquier perro supera al hombre, y por su parte ni siquiera se puede comparar con ciertos insectos, que perciben con facilidad perfumes de los cuales el hombre no tiene la menor idea.
2. Viaje a la tierra de la reina de Saba
Y ahora, después de ocuparnos un momento del funcionamiento del cuerpo humano y de señalar una de nuestras insuficiencias, trasladémonos a la tierra donde reinó en otro tiempo la reina de Saba. Es el Yemen actual. Entonces -y hablo de muchos siglos antes de nuestra era- la capital de este reino se llamaba Maryab. Hace algún tiempo los arqueólogos excavaron sus ruinas, y encontraron obras hidráulicas no muy distintas de las actuales. Hace alrededor de dos milenios y medio salían de este reino caravanas de camellos cargados de materias preciosas: incienso, bálsamos, canela y sal. Los esclavos que no pasaban de ser un suplemento, iban encadenados y se arrastraban detrás de la caravana de camellos. El oro no llegaba a igualar en valor los tesoros colocados sobre los lomos de los camellos. Un líquido espeso y oleoso, de color amarillo oscuro, de olor agradable y de sabor amargo, el bálsamo de mirra -una resina líquida- extraído del árbol llamado Commiphora abyssinica , formaba parte de las medicinas de aquellos tiempos y se utilizaba también para los oficios religiosos. Pero la más preciosa de todas era la resina del cedro del Líbano, cuyo perfume llenaba el templo en las grandes ceremonias.

Figura 1. Delante de las puertas de la ciudad de Maryab había sacerdotes, con las manos extendidas, recogiendo su parte de la carga de bálsamo y alheña, considerados en aquel tiempo como los más preciosos cosméticos.
Trescientas familias luchaban en el sur de Arabia, en aquellos tiempos, por el derecho de fabricación de esta materia preciosa. El escritor e historiador griego Heródoto, que vivía en el quinto siglo antes de nuestra era, contaba que no eran la reina ni sus autoridades las que autorizaban esta fabricación, sino los dioses mismos. No era fácil conseguir el divino permiso. El árbol, cuya corteza era necesario herir, estaba, según decían, guardado por serpientes venenosas, y si alguien se hubiera atrevido a extraer la preciosa resina en otro momento que en la época de novilunio, los dioses hubieran castigado severamente tal pecado. Ya desde hacía mucho tiempo la gente llevaba al templo todo lo que, según ellos, alegraría a los dioses con su perfume. Pero al final, cuando las terminaciones olfativas del cerebro de aquella gente apreciaban el perfume del incienso, de la resina y de las flores, eran ellos mismos los que se ponían contentos. Y el hombre quiso disfrutar, cada vez más, aquel placer, aquella sensación agradable. Hablamos del hombre, pero esta vez tendríamos que ser más precisos. Los precursores en el sector de la química que llamamos perfumería, y que incluye también el cuidado de la belleza del cuerpo -los cosméticos-, fueron, a decir verdad, más las mujeres que los hombres. Muchísimo tiempo antes de nuestra era, las persas y las bellas mujeres del reino de Saba sabían que la raíz de la planta que se llama alheña y que crece en los arenales, contenía un bello colorante rojo. Descubrieron también (y en esto las ayudaron mucho los hombres) que la raíz de la alheña remojada algún tiempo en el aceite, teñía el aceite de rojo. Las señoras y doncellas de Saba gustaban de hacer lo que acabamos de mencionar: disolvían la alheña en el aceite y con este aceite rojo, al cual agregaban otros aceites aromáticos, se teñían el pelo y las uñas. No les importaba nada que en la puerta por la cual se entraba a la ciudad, estuvieran sacerdotes, con la mano tendida, que percibían el diezmo, la décima parte de la alheña recogida. Entonces este cosmético no era barato. Para "alargarse los ojos", las mujeres de Tebas se pintaban los párpados con una mezcla de arcilla y hollín.

Figura 2. No es una aspersión de DDT sino un polvo con el cual el barbero embellecía a los nobles.
Pero veo que soy injusto con los hombres en este relato. Es que me olvidé completamente de los nobles romanos. Para acentuar su virilidad se pintaban las venas de las manos de azul (quién sabe si no tendrá esto algo que ver con lo de la sangre azul de los nobles).
Naturalmente, todo esto no es todavía exactamente perfumería. Es sólo un relato para ilustrar cómo la gente quiso, desde hace mucho tiempo, embellecer su apariencia.
Parece que los primeros verdaderos fabricantes de perfumes fueron los árabes. Todavía hoy, después de más de dos milenios, nos sorprende el indiscutible ingenio de aquellos fabricantes de perfumes y ungüentos. Cocían con agua en jarritos de cobre los pétalos de flores, los capullos y también ciertas semillas, y colocaban estas vasijas con decocciones aromáticas en sus habitaciones. Pero conocían también un sistema para captar el perfume embriagador de las flores: las dejaban remojar en aceite o las ponían en contacto con la grasa de ciertos animales, y así trasladaban el perfume de las flores al aceite y a la grasa. Es asombroso enterarse de que hasta hace muy poco los perfumistas no hacían en realidad nada más que esto.
Europa no vivió la edad de oro de los cosméticos y perfumería hasta los siglos XVII y XVIII. Entonces los nobles, en lugar de contentarse con vestirse, como antes, con los colores favoritos de sus señores, se rociaban con los perfumes que utilizaban sus mujeres o sus amantes. Los reyes de Francia pedían que sus alcobas tuviesen un perfume distinto cada día. Las diferencias de clase entre las mujeres eran tan profundas, que las reinas y las princesas utilizaban ciertas especies de perfumes y maquillajes, las damas de la corte, otras, y las mujeres de los ricos burgueses, otras más. En aquellos tiempos, naturalmente, eran sólo mujeres ricas las que podían comprarse perfumes y maquillajes. No tiene nada de extraño, ¡pues para la obtención de un solo gramo de esencia de violeta era necesario nada menos que un quintal métrico de pétalos de violetas!
La situación ha cambiado muchísimo desde el tiempo de los perfumistas árabes, y hasta del de los reyes de Francia. El químico analiza las plantas con las que se fabrican los perfumes, y después de averiguar la composición de las esencias, que son las materias primas principales para la fabricación de perfumes, empieza a imitar a la naturaleza.
3. ¿Por qué huelen bien las flores?
Antes de entrar en el laboratorio del químico moderno -que otra vez se dispone a utilizar el hediondo alquitrán de hulla para fabricar perfumes- echemos una ojeada a la naturaleza un momento. Mientras, tratemos de averiguar por qué huelen bien las flores y cómo es posible que ciertas exudaciones nauseabundas del cuerpo de los animales se tornasen materias primas de las más preciosas para la fabricación de los perfumes.
Hay plantas que tienen algo magnífico que se llama comúnmente esencia. Es una mezcla aromática de muy variados géneros de sustancias formadas ante todo en las partes verdes de la planta -es decir en las hojas y en el tallo-, pero en cuanto empieza a desarrollarse la flor, la esencia se encamina a ella. Y allá se concentra todavía más, para atraer al insecto que fecunda la flor con el polen. Cuando la planta ha terminado de florecer, la esencia se traslada a veces de nuevo a su hogar verde.
La esencia que se forma en las células vegetales atraviesa la pared celular y escapa al aire. Los órganos olfatorios del hombre captan las moléculas de esencia dispersas en el aire y que constituyen el aroma, y comunican la impresión al cerebro, como dijimos hace un momento. El hombre percibe el olor de la flor. Si arrancamos una flor, olerá un rato y luego de ella quedará sólo una materia marchitable y moribunda, sin perfume.
¿Cómo sacar entonces el perfume de la flor o de la planta y conservarlo, para que sobreviva?
Escuchen la leyenda de la joven emperatriz de la India, la esposa de Yehangera, que inventó la esencia de rosa.
Cuentan que un día se paseaba la Emperatriz junto a la fuente de su jardín, donde no había más que rosas. De repente se detuvo asombrada, mirando la superficie cubierta de miles de pétalos de rosa. Al tomar en la mano un poco del agua en que flotaban los pétalos, le sorprendió su olor: el agua había adquirido el aroma de los pétalos de las rosas moribundas. Cuentan que así nació la primera fábrica de esencia de rosa.

Figura 3. Rosa, tu perfume es el más suave/ tu perfume es el rey de todos./Tú eres la más encantadora de las flores./"Poesía de la India"
Abandonemos a la bella princesa de la India en su jardín de rosas y regresemos a la realidad actual. Veamos, por ejemplo, en el sur de Francia, a orillas del Mediterráneo, la ciudad de Grasse. Allí es la cuna de la fabricación moderna de los más maravillosos perfumes del mundo, perfumes hechos con verdaderas flores. Miles y miles de personas viven del cultivo de la tuberosa, el jazmín, la violeta, el clavel, la flor del naranjo, el lirio de los valles, el jacinto y la rosa, flores con las cuales se fabrican los perfumes.
Viajemos allá, a ver qué hacen. Pero no se vayan a sorprender si, antes de encontrar flores de perfumes gratos, vemos barriles llenos de grasa de puerco y sebo de res, y tanques de aceite de oliva.

Figura 4. Plantaciones de jazmín cerca de la ciudad francesa de Grasse.Almacén de pétalos de rosa.
Es que sin eso no existirían perfumes finos. Los fabricantes de los famosos perfumes franceses aplican estas grasas a gruesos discos de vidrio con marcos de madera, que colocan superpuestos. Y entonces ponen flores frescas sobre las gruesas capas de grasa de puerco mezclada con sebo de res.

Figura 5. Con los ojos cerrados se distinguen los aromas agradables de los olores desagradables. Es fácil darse cuenta de que se está oliendo un clavel, y no un frasco de amoniaco.
Los blancos jazmines y los pétalos rosados de los claveles se tienen largas horas en estos marcos cargados de grasa animal. Y esta grasa absorbe sin cesar el perfume de las flores, la esencia que se está evaporando de ellas. Cuando mueren las flores, la mano del hombre las remplaza con otras, frescas. Una y otra vez la grasa absorbe el perfume de la tuberosa, del jazmín o del clavel. Hasta setenta veces se cambian las flores. Luego la mano del perfumista quita del vidrio la grasa de puerco, saturada del perfume agradable, y la guarda en recipientes. Pero todavía no es éste el verdadero perfume que deseamos. Es sólo una pasta aromática, que los fabricantes de perfumes llaman pomada o "concreto". Ésta se debe tratar todavía, hay que agregarle un poco de alcohol puro, y calentar moderadamente toda la mezcla. Así se realiza el traslado de la esencia. Esta portadora de perfume abandona la grasa de puerco y pasa al alcohol. Los perfumistas llaman a este alcohol, cargado de esencia, extracto floral.
Todavía no están contentos. Quieren obtener esencia de flores pura, y para eso congelan el extracto alcohólico, hasta que se solidifique el último residuo de grasa disuelto en el alcohol, pues si queda grasa en esta disolución, el perfume no olerá a lo que debe, sino a grasa. Por eso es necesario filtrar la disolución en alcohol, trasladarla a un aparato de destilación, evaporarla y enfriar los vapores. Sólo entonces está terminado el trabajo. En el recipiente donde se recibe el líquido se acumula un maravilloso aceite aromático. Basta un poco de alcohol, y ya está el perfume que llega a la tienda.

Figura 6. Antiguo sistema de destilación de perfumes
Existen muchos métodos más para obtener esencias aromáticas de flores. Por ejemplo, hay un procedimiento según el cual las flores se meten en bolsas de tela, que se sumergen en aceite tibio y allí se tienen hasta que toda la esencia pasa de las flores al aceite. Este proceso químico se llama maceración. Pero podemos olvidar esto. Se trataba ante todo de saber qué es lo que huele bien en las flores o en las plantas, y cómo aprendió el hombre a arrebatar su perfume a la flor. Ahora lo sabemos: la esencia, jugo aromático de las plantas, es un licor vivo que, después de una larga peregrinación química, se guarda en bellos frascos de cristal cortado y nos hace la vida agradable.
4. No sólo las flores.
Ahora fijémonos en ciertos animales, uno de los cuales vive en el mar, el segundo en tierra, en África y en la India, y el tercero en el Himalaya.
Desde tiempos inmemoriales los marineros descubrían en alta mar una materia que flotaba en la superficie del agua y que no tenía un olor nada agradable. Durante mucho tiempo nadie supo de dónde venía aquello. Sólo cuando se descubrió una materia análoga en el cuerpo de los cachalotes se sospechó que esta materia maloliente, parecida a una cera, pudiera acompañar a los excrementos del cachalote. Pero ¿cómo se originaba en el cuerpo de este habitante del mar? Parece que las sepias que les gusta saborear a los cachalotes tienen algo que ver, pero la verdad es que hasta hoy nadie puede explicar la cosa con precisión.

Figura 7. Cachalote
Por lo demás, este punto no fue ni es lo más interesante de este cuerpo poco atractivo. Si se sumerge un pedacito de esta materia gris, producida por el cachalote, en el alcohol, se lleva una gran sorpresa. En lugar de oler algo desagradable, se percibe un maravilloso perfume, que de momento no se puede comparar con nada. Esta secreción del cachalote se llama ámbar gris (no tiene que ver con el otro ámbar) y fue más solicitada que el oro y las piedras preciosas, por su perfume. Los perfumistas empezaron a agregarlo en cantidades insignificantes a sus productos y pronto reconocieron que el ámbar gris no sólo huele bien, sino que suaviza también los demás perfumes y los hace más constantes y permanentes. Naturalmente, el precio del ámbar gris era elevado.
Abandonemos el mar, dejemos el cachalote a su destino y ahora partamos hacia el Himalaya. Allá vive un rumiante, parecido a la cabra o a la gamuza, pero sin cuernos. Es arisco, sale sólo después de la puesta del Sol, de día se esconde entre las rocas, donde se alimenta de hierba y líquenes. Es el almizclero y en la parte ventral de su cuerpo tiene una glándula que segrega una materia parda rojiza, pegajosa y maloliente. Hace ya mil años que los aborígenes saben que la bolsa llena de esta materia, que le arrancan al animal después de matarlo, vale más que una bolsa de piedras preciosas. Es que contiene, cuando está llena, treinta gramos de la mencionada materia granulosa, que se llama almizcle. Cuando se muele este almizcle con un poquito de arena y luego se disuelve en alcohol, se obtiene un líquido de maravilloso perfume, una especie de tintura. Es la más preciosa de las materias primas que se agregan a los perfumes. Es tan cara que precisamente su rareza y su precio elevado determinaron a los químicos a fabricarla sintéticamente lo antes posible. Lo lograron, pero no por eso el almizcle perdió su valor.
Hasta hoy los tratantes en almizcle siguen tratando de engañar a sus clientes añadiendo al producto sangre seca o pedazos de piel, para que pese más la bolsa.
5. El gato y la cucharita
Mencionemos por lo menos otra materia prima para hacer perfumes que tiene origen animal. En Etiopía y en Egipto vive un animal parecido al gato: es la civeta o gato de algalia.

Figura 8. Civeta de África
Esta fierecilla segrega en glándulas, comparables a las del almizclero, una materia amarillenta y sebácea que recogen sus criadores una vez por semana con una cucharita; las glándulas se encuentran en el abdomen del animal. Este líquido no es nada agradable, hiede terriblemente. Pero se produce el milagro cuando se disuelve en alcohol y se deja allí algún tiempo; adquiere un olor muy agradable. Es caro y también hace más suaves y constantes los perfumes fabricados con flores.
6. El perfume de las flores
Ya hablamos demasiado de las materias malolientes segregadas por los animales que, como si fuera con una varita mágica, se cambian en maravillosos perfumes por contacto con el alcohol. Pero no debemos olvidar algo. El perfume de las flores que respiramos no corresponde nunca a una sustancia pura. Siempre se trata de mezclas de numerosas sustancias fragantes, entre las cuales, cierto es, suele predominar un componente fundamental, completado por los demás.
Y ahora que sabemos todo esto, abandonemos el jardín de rosales y también las regiones multicolores, junto a las costas del Mediterráneo, con sus naranjos aromáticos, sus lirios y tuberosas; dejemos la civeta, el cachalote y el almizclero, y entremos valientemente en el laboratorio del químico, donde encontramos, en lugar de violetas, lavanda y rosas, probetas alineadas, mecheros Bunsen y aparatos de destilación de vidrio.
7. Otra vez el químico
Los químicos trataron desde hace mucho tiempo de fabricar perfumes a partir de materias más baratas que las flores o la madera de árboles preciosos. La creciente demanda de perfumes ha obligado a buscar materias primas en partes que no sean los bosques de la India, donde crece el sándalo, ni en Sicilia, donde huelen tan bien las flores del naranjo y del limonero, ni en partes como Zanzíbar, muy lejos, donde se da el jengibre. Hasta principios del siglo pasado se encontraban los investigadores ante un misterio indescifrable: aunque analizaran variadas esencias, encontraban una y otra vez las mismas materias aromáticas fundamentales. Por ejemplo, la esencia de comino parecía tener la misma composición química que la de clavo. Naturalmente, en aquel tiempo no sabían todavía gran cosa de los isómeros, que son sustancias con la misma fórmula química global, pero con distintas estructuras, y por ende, propiedades diferentes. Era un verdadero misterio que no podían entender. Wöhler -ya conocemos a este químico, recordemos que fue el primero en el mundo en fabricar urea sintética-, sabio alemán, descubrió que la disposición de las moléculas en una materia química no quiere decir gran cosa. Lo importante es saber cómo están dispuestas en las moléculas las mínimas partículas que componen la materia, es decir los átomos. Y este descubrimiento tuvo un valor inapreciable, por lo que se refiere a la investigación de los perfumes. En cuanto supo el investigador cómo era el rompecabezas químico de, digamos, la esencia de clavo o de lavanda, no sólo por lo que se refiere a las moléculas sino también al último átomo, pudo fabricar las esencias sintéticamente. Y para ello no necesitaba ninguna flor. Pudo incluso fabricar perfumes mejor que la misma naturaleza. Es casi increíble, pero tómese por ejemplo la esencia de rosa que se fabrica con la rosa de cien hojas y es un famoso producto búlgaro. El aroma de la esencia de rosa pura, que se fabrica por destilación de pétalos, es débil y ni siquiera muy agradable. La esencia de rosa huele bien sólo cuando la atenuamos. La esencia natural de rosa tiene incluso una mala propiedad: es difícil quitarle la parafina que hace que el aceite se enturbie y solidifique. Ésta es, pues, la esencia de rosa que ofrece la naturaleza. Ahora permitan que el químico prepare su esencia de rosa sintética. Es horrible lo que utiliza para eso. En lugar de rosas, otra vez el alquitrán de hulla de olor desagradable, que encontramos ya tantas veces. Desde el siglo pasado, se averiguó que dos compuestos derivados del alquitrán de hulla -el benzaldehido y el ácido salicílico- daban, entre las manos del químico, una esencia de rosa. El benzaldehido es un líquido aromático amarillento que huele a almendras amargas, y el ácido salicílico sintético se presenta como agujitas incoloras. Y ahora fíjense en esto: el benzaldehido, llamado también esencia sintética de almendras amargas, se encuentra en la naturaleza en éstas (bajo una forma que tiene un nombre complicado: benzaldehido-cianhidrina) y también en el alquitrán de hulla. Y el ácido salicílico se encuentra, por ejemplo, en las fresas y en las hojas del sauce que crece en las riberas de algunos riachuelos y ríos.
¿No es de veras asombroso que se pueda fabricar esencia de rosa sin una sola rosa, sino con hulla? ¡Y qué esencia! Una esencia que mientras se fabrica ya tiene un olor maravilloso, no se enturbia, se disuelve mejor; en pocas palabras, es mejor que la esencia de rosa que extrae el hombre de los pétalos de la rosa de cien hojas. Y hay algo más. De dos toneladas de pétalos de rosa se obtienen apenas cinco gramos de esencia. El químico fabrica la misma cantidad de esencia de rosa con algunos mililitros de benzaldehido.
8. El profesor que amaba las violetas
Existen en el mundo 2 000 especies de perfumes sintéticos. Ocurre esto porque los químicos siguieron buscando, a pesar de ciertos experimentos infructuosos, hasta encontrar lo que buscaban, ellos y las mujeres también. Es justo mencionar por lo menos a uno de estos químicos. Se llamaba F. Tiemann y aprendió química en Berlín. Durante toda su vida, este profesor no hizo más que tratar de obtener perfumes sintéticos. Algunos días antes de su muerte, sus alumnos le preguntaron cuál había sido el día más feliz de su vida.
-El día que logré imitar el más bello de los perfumes que la naturaleza ha inventado, el perfume de las violetas -contestó el profesor Tiemann sin vacilar.
El profesor berlinés buscó este perfume de violeta mucho, mucho tiempo en su laboratorio. Debajo de sus ventanas florecían violetas, y a veces, aunque no se diera cuenta, se inclinaba sobre ellas como si esperara que le susurraran su secreto. Tal vez se lo dijeron de veras. Un día percibió el perfume de violeta en un matraz donde había puesto una esencia extraída de la gramínea del Andropogon nardus , acetona (líquido incoloro fabricado a partir de acetato de calcio) y ácido sulfúrico. Al calentar esta mezcla, Tiemann obtuvo una materia que olía precisamente a violeta. Nuestras mujeres e hijas deberían dar las gracias al profesor Tiemann mentalmente, por el hecho de que puedan comprar por poco precio un frasco de perfume de violeta sintético. Antes el perfume de violeta era accesible sólo a los ricos.

Figura 9.
El profesor berlinés contribuyó a una larga serie de investigaciones que se prolongaron todo el siglo XIX; uno tras otro, la cumarina, la vanillina, el alcohol feniletílico, los nombres se sucedieron, y detrás de ellos se escondían productos sintéticos que remplazaban esencias naturales. Hasta las materias malolientes producidas por las entrañas del cachalote y la civeta se pueden remplazar por materias que prepara el químico en el laboratorio. Naturalmente, son muchísimo más baratas que la algalia, el ámbar gris o el almizcle.
9. Fin de una tradición, comienzo de otra
Hace aún no muchos años, se podía leer todavía en una callejuela de la Ciudad Pequeña, en Praga, una inscripción: Demartini, jabonaría y perfumería. No sé si está puesta allí como lo estaba hace casi 200 años, cuando un miembro de la familia de los Demartini decidió fundar la primera fábrica de jabones, y más tarde de perfumes, en Bohemia. No era ni químico ni boticario. Demartini era deshollinador. Su familia se trasladó de alguna parte de Italia a Bohemia. Todos los Demartini eran deshollinadores. Sólo a uno de ellos no le gustó subirse a los tejados y limpiar chimeneas. Por razones que ya no conoce nadie hoy, decidió fabricar jabones y perfumes en 1777.

Figura 10. La más antigua perfumería y jabonería checa
Francisco Prochaska fue el segundo fabricante de perfumes en Checoslovaquia. Él tampoco sabía química. Era carnicero y le gustaba correr mundo. Llegó a Francia y allá, en la provincia soleada, se familiarizó con el arte de la perfumería. Cuando regresó a su tierra, empezó él también a fabricar perfumes.
11. Despedida
No puedo dejar de pensar en el juego extraño de la naturaleza que, como con mano delicada, dio a las flores gota a gota parte de sus secretos, que el hombre percibe por sus sentidos. Me vuelvo mentalmente a cada momento hacia el investigador curioso que supo descorrer el velo aparentemente impenetrable y fabricar perfumes que la naturaleza no quiso dar al mundo. Contemplo con sincera admiración su curiosidad asombrosa, su paciencia infinita y su sabiduría.